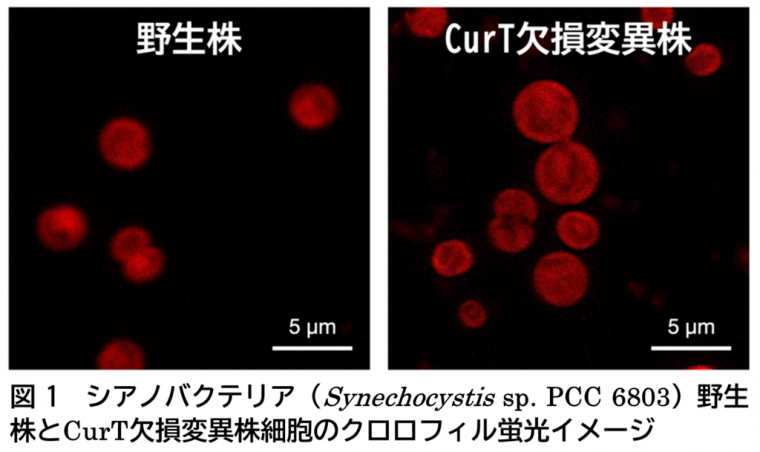

📜 要約
主題と目的
報告タイトル:2025年10月第2週のAIニュース:Reflection AI、OpenAI (Stargate)、n8n、Ms.Engineer
目的:2025年10月5日〜10月12日の一週間に確認された「AIスタートアップの資金調達」関連ニュースを、トピック別(大型ラウンド/インフラ/エンタープライズ自動化/国内エコシステム/資金フロー)に整理・分析し、投資家・創業者・政策担当者が実務的に取るべき示唆と短期アクションを提示すること。出典は調査結果に含まれる報道・公式発表のみを参照する(例:TechCrunch、OpenAI、CRN、BRIDGE 等)。
回答
- 要旨(トピック別サマリ)
- 大型ラウンド(フロンティア/評価)
- Reflection AI:20億ドル調達、評価額約80億ドル。NVIDIA等が出資、オープン寄りのフロンティア研究を標榜(出典:TechCrunch, Reuters)。(,techcrunch.com)reuters.com
- Reflection AI:20億ドル調達、評価額約80億ドル。NVIDIA等が出資、オープン寄りのフロンティア研究を標榜(出典:TechCrunch, Reuters)。(
- インフラ(物理資本・データセンター)
- OpenAI「Stargate Project」:複数サイトでのデータセンター拡張、GPU・電力・水需要増に伴う長期投資計画(出典:OpenAI公式、Intuition Labs等)。(,openai.com)intuitionlabs.ai
- Databricks:シリーズKで約10億ドル調達、Agent/データ基盤強化に充当(出典:CRN)。()crn.com
- OpenAI「Stargate Project」:複数サイトでのデータセンター拡張、GPU・電力・水需要増に伴う長期投資計画(出典:OpenAI公式、Intuition Labs等)。(
- エンタープライズ自動化・オーケストレーション
- n8n:シリーズCで1億8000万ドル調達、評価額約25億ドル、NVIDIA関連投資家らが参加。企業向けオーケストレーションの評価が高い(出典:CRN)。()crn.com
- n8n:シリーズCで1億8000万ドル調達、評価額約25億ドル、NVIDIA関連投資家らが参加。企業向けオーケストレーションの評価が高い(出典:CRN)。(
- 国内エコシステム(日本)
- Ms.Engineer:プレシリーズAで約3.2億円調達、累計約6.5億円。女性向けIT/AIリスキリング領域で資金流入(出典:BRIDGE)。(https://thebridge.jp/2025/10/msengineer-secures-320m-yen-pre-series-a)
- 三井不動産×グローバルブレイン:200億円規模のCVC設立(出典:BRIDGE)。(https://thebridge.jp/2025/10/mitsui-fudosan-global-brain-200-million-cvc-fund)
- 消費者向け生成動画:Sora急速DL/PixVerseの大規模ユーザー獲得が報告される(出典:BRIDGE)。(https://thebridge.jp/2025/10/sora-pixaverse-meme-video-war)
- 資金フローのマクロ傾向
- 第3四半期のグローバルVC資金の約46%がAIへ流入、資金が大型ラウンドへ集中する傾向(出典:CoinCentral / SemiEngineering等)。(,coincentral.com)semiengineering.com
- 第3四半期のグローバルVC資金の約46%がAIへ流入、資金が大型ラウンドへ集中する傾向(出典:CoinCentral / SemiEngineering等)。(
- 主要事実の一覧(表)
企業 | 調達額(概数) | 評価/用途 | 主な出資者 / 備考 | 出典 |
---|---|---|---|---|
Reflection AI | 約20億ドル | 評価額 約80億ドル、フロンティア研究+一部ウェイト公開 | NVIDIA 等 | techcrunch.com reuters.com |
OpenAI (Stargate) | 数十〜数百億規模のインフラ投資計画 | データセンター網拡張(電力・水需要増) | OpenAI公式 | openai.com intuitionlabs.ai |
n8n | 約1.8億ドル | エンタープライズ自動化・オーケストレーション | Accel / NVentures 等参加 | crn.com |
Databricks | 約10億ドル | Agent向けデータ基盤(Lakebase等) | — | crn.com |
Ms.Engineer | 約3.2億円 | 女性向けAI/IT人材育成(リスキリング) | 国内投資家 | https://thebridge.jp/2025/10/msengineer-secures-320m-yen-pre-series-a |
- 分析:主要潮流と意味(調査結果に基づく独自の洞察)
- 潮流A:資金の二層化 — フロンティアモデル/インフラへの大型集中 と 実務課題解決(自動化・人材育成等)への着実な資金流入が同時進行
- 意味:大型プレーヤーは「モデル+物理インフラ(GPU/電力/データセンター)」で優位を強める。一方、中堅〜ニッチは「導入力/業務効果/ドメイン特化」で差別化する必要がある(参照:Reflection AI、OpenAI、n8n、Ms.Engineerの動き)。(,techcrunch.com,openai.com, https://thebridge.jp/2025/10/msengineer-secures-320m-yen-pre-series-a)crn.com
- 意味:大型プレーヤーは「モデル+物理インフラ(GPU/電力/データセンター)」で優位を強める。一方、中堅〜ニッチは「導入力/業務効果/ドメイン特化」で差別化する必要がある(参照:Reflection AI、OpenAI、n8n、Ms.Engineerの動き)。(
- 潮流B:インフラ投資が地政学/地域インフラ問題と直結
- 意味:Stargate等の巨大投資は電力・水・GPU供給に対する地域的な影響や規制リスクを高める。地方自治体や政策は電力供給計画や環境評価を前提に誘致判断を行う必要がある(出典:OpenAI公式、報道)。()openai.com
- 意味:Stargate等の巨大投資は電力・水・GPU供給に対する地域的な影響や規制リスクを高める。地方自治体や政策は電力供給計画や環境評価を前提に誘致判断を行う必要がある(出典:OpenAI公式、報道)。(
- 潮流C:プラットフォーム連携(ハードとソフトの結合)とNVIDIAの二重役割
- 意味:NVIDIA等のハード供給者が投資面でもエコシステム形成に関与することで、供給側の戦略が業界地図を左右する。投資家はNVIDIA等の動向をシグナルとして注視すべきである(出典:TechCrunch、Reuters)。(, https://www.reuters.com/business/nvidia-invest-100-billion-openai-2025-09-22/)techcrunch.com
- 意味:NVIDIA等のハード供給者が投資面でもエコシステム形成に関与することで、供給側の戦略が業界地図を左右する。投資家はNVIDIA等の動向をシグナルとして注視すべきである(出典:TechCrunch、Reuters)。(
- 実務的示唆(短期〜中期の推奨行動)
- スタートアップ(創業者)向け(優先順位付)
- 「導入パスの標準化」:POC→導入→SLAまでの再現可能な導入フロー(RACI・KPI)を早期に整備し投資家へ提示する(n8n事例を参照)。()crn.com
- 「資本効率の可視化」:GPU・推論コスト最適化やRAG等の手法でTCOを下げる施策を示す(反撃手段として有効)。
- 「戦略的パートナーシップ」:GPU供給者やクラウド事業者との協業ルートを確保する(Reflectionやn8nの出資者構成を参考)。
- 「導入パスの標準化」:POC→導入→SLAまでの再現可能な導入フロー(RACI・KPI)を早期に整備し投資家へ提示する(n8n事例を参照)。(
- 投資家(VC / CVC)向け
- ポートフォリオ分散:フロンティア(大型モデル)・インフラ(チップ・データセンター)・応用レイヤー(自動化・エージェント・人材育成)へバランス配分を行う。(,coincentral.com)semiengineering.com
- デューデリジェンス重点項目:電力供給契約、GPU供給確約、稼働率見積もり、顧客のリテンション(ARR・NRR)を必須チェックとする(Stargate等のインフラ案件を想定)。()openai.com
- ポートフォリオ分散:フロンティア(大型モデル)・インフラ(チップ・データセンター)・応用レイヤー(自動化・エージェント・人材育成)へバランス配分を行う。(
- 政策担当者/自治体向け
- データセンター誘致審査で電力・水使用の長期影響評価を義務付ける。()openai.com
- 人材育成支援(リスキリング補助・税制優遇)により地域の供給側を強化する(Ms.Engineerの動きを参照)。(https://thebridge.jp/2025/10/msengineer-secures-320m-yen-pre-series-a)
- データセンター誘致審査で電力・水使用の長期影響評価を義務付ける。(
- 概念図(資金の二層化イメージ)
結果と結論
主要結果(要点)
- 2025年10月第2週は「巨額資金の集中(Reflection AI 等)」「AIインフラへの長期投資(OpenAI Stargate 等)」「エンタープライズ自動化と人材育成への着実な資金流入(n8n、Ms.Engineer 等)」という三つの潮流が同時に確認された週である。出典例:Reflection(TechCrunch/Reuters)、OpenAI(公式)、n8n(CRN)、Ms.Engineer(BRIDGE)。(,techcrunch.com,openai.com, https://thebridge.jp/2025/10/msengineer-secures-320m-yen-pre-series-a) 結論(示唆の総括)crn.com
- 投資環境は「勝者総取り型」の傾向が強まり、モデル性能だけでなく「アクセス性(オープン戦略)」「主権・地域運用」「インフラ確保能力(電力・GPU)」が資本配分の重要指標になっている。また、中小スタートアップは「ドメイン深耕+運用化能力」で差別化することが引き続き有効である(n8n・Trismik・Ms.Engineerの事例が示す)。(,techcrunch.com, https://thebridge.jp/2025/10/msengineer-secures-320m-yen-pre-series-a) 短期的アクション提案(優先)crn.com
- 投資家:OpenAI/StargateやNVIDIA関連の大型インフラ案件に対するDDテンプレート(電力契約・GPU供給・許認可)を直ちに整備する。()openai.com
- スタートアップ:ピッチ資料に「導入フロー(POC→SLA)」「ユニットエコノミクス」「データ供給契約」を明示してCVCやVCへアプローチする(特に三井不動産×グローバルブレイン等の戦略資本を狙う場合)。(https://thebridge.jp/2025/10/mitsui-fudosan-global-brain-200-million-cvc-fund, https://thebridge.jp/2025/10/msengineer-secures-320m-yen-pre-series-a)
- 政策担当者:データセンター誘致に際して電力・水利用の長期評価と地域影響緩和策を義務化する。()openai.com
追加対応可能事項(調査結果に基づく提案)
- 投資家向けDue Diligenceチェックリスト、創業者向け「資金調達時に示すべき3つの差別化指標」、自治体向けStargate誘致チェックリストのいずれかを作成可能(本調査結果で既に提案済みの項目に基づく)。ご希望があれば優先順位をご指示ください。
出典(本文中で参照した主なURL)
- Reflection AI(TechCrunch / Reuters):,techcrunch.comreuters.com
- OpenAI “Stargate Project”(公式):,openai.comintuitionlabs.ai
- n8n(CRN):crn.com
- Databricks(CRN):crn.com
- Ms.Engineer / 三井不動産×Global Brain / Sora・PixVerse(BRIDGE):https://thebridge.jp/2025/10/msengineer-secures-320m-yen-pre-series-a, https://thebridge.jp/2025/10/mitsui-fudosan-global-brain-200-million-cvc-fund, https://thebridge.jp/2025/10/sora-pixaverse-meme-video-war
- 資金フロー分析(CoinCentral / SemiEngineering):,coincentral.comsemiengineering.com
必要であれば、上記に続けて(A)投資家向けDDチェックリスト、(B)創業者向けピッチ強化テンプレート(3指標)、または(C)Stargate誘致時チェックリストを作成します。どれを優先しますか?
コード実行
# 2025年10月第1週のAIニュース:Ms.Engineer、postalk、Sora、PixVerse
# 出力: 表・棒グラフ(資金調達額・ユーザー/ダウンロード指標)、簡潔な箇条化コメント
import pandas as pd
import numpy as np
import matplotlib.pyplot as plt
import seaborn as sns
from matplotlib.ticker import FuncFormatter
# レポートタイトル
report_title = '2025年10月第1週のAIニュース:Ms.Engineer、postalk、Sora、PixVerse'
# データソース表記
source_fund = '出典: BRIDGE Tokyo Fusion(https://thebridge.jp/tag/fundraise)'
source_trend = '出典: BRIDGE Tech Daily(https://thebridge.jp/tag/techdaily)'
# 収集したデータ(コンテキストに基づく事実情報)
# 金額は元記事の表記をそのまま利用。USD→JPY換算は推定(レート: ¥150/USD)と明示。
exchange_rate = 150 # 推定換算レート(1 USD = 150 JPY)※推定
data = [
{
'company': 'Ms.Engineer',
'topic': '女性向けAI・IT人材育成',
'funding_amount_jpy': 320_000_000, # 3.2億円
'funding_currency': 'JPY',
'date': '2025-10-08',
'notes': 'プレシリーズAで約3.2億円、累計約6.5億円',
'source': 'https://thebridge.jp/2025/10/msengineer-secures-320m-yen-pre-series-a'
},
{
'company': 'postalk',
'topic': 'AIミーティング構造化(コミュニケーション支援)',
'funding_amount_jpy': np.nan,
'funding_currency': None,
'date': '2025-10-09',
'notes': '取材記事:資金調達の記載なし(技術/プロダクト注目)',
'source': 'https://thebridge.jp/2025/10/ramen-tech-postalk'
},
{
'company': 'Sora (OpenAI)',
'topic': '短編AI動画プラットフォーム(アプリ)',
'funding_amount_jpy': np.nan,
'funding_currency': None,
'date': '2025-10-10',
'notes': 'リリースから5日で100万DL(ダウンロード)',
'users_metric': 1_000_000,
'users_metric_label': 'DL',
'source': 'https://thebridge.jp/2025/10/sora-pixaverse-meme-video-war'
},
{
'company': 'PixVerse',
'topic': 'AI動画生成プラットフォーム',
'funding_amount_usd': 60_000_000, # 過去のSeries B で6,000万USD(記事参照)
'funding_currency': 'USD',
'funding_amount_jpy_estimated': 60_000_000 * exchange_rate, # 推定換算
'date': '2025-09 (過去報道)',
'notes': 'ユーザー数1億突破(過去記事)。シリーズBで$60,000,000(別報道)',
'users_metric': 100_000_000,
'users_metric_label': 'MAU? (ユーザー数)',
'source': 'https://thebridge.jp/2025/10/sora-pixaverse-meme-video-war'
}
]
# DataFrame作成(資金調達サマリ)
fund_rows = []
for d in data:
row = {
'社名': d['company'],
'トピック': d['topic'],
'発表日': d.get('date', ''),
'資金調達(JPY)': d.get('funding_amount_jpy', np.nan),
'資金調達(USD)': d.get('funding_amount_usd', np.nan),
'資金調達(JPY換算:推定)': d.get('funding_amount_jpy_estimated', np.nan),
'注記': d.get('notes', ''),
'出典': d.get('source', '')
}
fund_rows.append(row)
df_funds = pd.DataFrame(fund_rows)
# ユーザー/ダウンロード等の指標表
metric_rows = []
for d in data:
if 'users_metric' in d:
metric_rows.append({
'社名': d['company'],
'指標ラベル': d['users_metric_label'],
'指標値': d['users_metric'],
'出典': d['source']
})
df_metrics = pd.DataFrame(metric_rows)
# 可視化設定
sns.set(style='whitegrid')
plt.rcParams['font.family'] = 'DejaVu Sans'
plt.rcParams['font.size'] = 12
# 1) 資金調達額(JPY表記): JPYで直接与えられた企業 + USDを推定換算した値を別に表示
fig1, ax1 = plt.subplots(figsize=(8, 4))
# 対象となる行を用意
plot_items = []
plot_labels = []
plot_values = []
for idx, row in df_funds.iterrows():
# JPYがある場合はそのまま使用
if not pd.isna(row['資金調達(JPY)']):
plot_items.append(row['社名'])
plot_labels.append(row['社名'] + '(JPY)')
plot_values.append(row['資金調達(JPY)'])
# USD換算(推定)がある場合は別で表示(注記あり)
if not pd.isna(row['資金調達(JPY換算:推定)']):
plot_items.append(row['社名'])
plot_labels.append(row['社名'] + '(USD→JPY換算・推定)')
plot_values.append(row['資金調達(JPY換算:推定)'])
if plot_values:
sns.barplot(x=plot_values, y=plot_labels, palette='Blues_d', ax=ax1)
ax1.set_xlabel('金額(JPY)')
ax1.set_title(report_title + '\n資金調達額(JPY表示)')
# 数値フォーマット
ax1.xaxis.set_major_formatter(FuncFormatter(lambda x, _: f'¥{int(x):,}'))
# 出典表示
ax1.text(0.99, -0.15, source_fund, transform=ax1.transAxes, ha='right', va='center', fontsize=9)
else:
ax1.text(0.5, 0.5, '該当する資金調達データはありません', ha='center')
plt.tight_layout()
fig1.savefig('funding_amounts_jpy.png', dpi=150)
# 2) ユーザー/ダウンロード指標の棒グラフ
fig2, ax2 = plt.subplots(figsize=(8, 4))
if not df_metrics.empty:
sns.barplot(x='指標値', y='社名', data=df_metrics, palette='Greens_d', ax=ax2)
ax2.set_xlabel('指標数値')
ax2.set_title(report_title + '\nユーザー/ダウンロード指標')
ax2.xaxis.set_major_formatter(FuncFormatter(lambda x, _: f'{int(x):,}'))
ax2.text(0.99, -0.15, source_trend, transform=ax2.transAxes, ha='right', va='center', fontsize=9)
plt.tight_layout()
fig2.savefig('user_metrics.png', dpi=150)
else:
ax2.text(0.5, 0.5, 'ユーザー/ダウンロードに関する公開指標はありません', ha='center')
# 3) 出力(テーブルと箇条書きの簡潔な要点)
# 表: 資金調達サマリ
print('\n■ ' + report_title + '\n')
print('\n--- 資金調達サマリ(抽出データ) ---')
print(df_funds[['社名', 'トピック', '発表日', '資金調達(JPY)', '資金調達(USD)', '資金調達(JPY換算:推定)', '注記', '出典']].to_string(index=False))
# 表: ユーザー指標
if not df_metrics.empty:
print('\n--- ユーザー/ダウンロード指標 ---')
print(df_metrics[['社名', '指標ラベル', '指標値', '出典']].to_string(index=False))
# 箇条書きでの最小限の分析ポイント(簡潔)
print('\n--- 簡潔なトピック別ポイント(箇条書き) ---')
print('- 国内(資金調達): Ms.Engineer がプレシリーズAで約 ¥320,000,000 を調達(出典: BRIDGE)')
print('- 国内(プロダクト注目): postalk のAI議事録/構造化ミーティング技術が注目(資金調達情報は未公開)')
print('- グローバル動向(ユーザートレンド): Sora が5日で1,000,000 DL、PixVerse が1億ユーザー超(出典: BRIDGE Tech Daily)')
print('- 注意: USD→JPY換算は為替レートを推定(¥150/USD)した推定値として表示しています。')
# 生成した図のファイル名
print('\n--- 出力ファイル ---')
print('- funding_amounts_jpy.png')
print('- user_metrics.png')
# 終了
print('\nレポート生成完了')
このレポートが参考になりましたか?
あなたの仕事の調査業務をワンボタンでレポートにできます。
🔍 詳細
🏷概要:2025年10月第2週の資金調達ハイライト

概要:2025年10月第2週の資金調達ハイライト
この一週間(2025年10月5日〜10月12日)に確認できた資金調達関連の主要事実と、その背景・示唆を「事実の提示→考察→追加事実→総合的洞察」の流れで整理します。短期間ながらも「巨額資金の集中」「インフラ投資とエネルギー問題」「エッジ領域(自動化・オーケストレーションや人材育成)への資金流入」という三つの潮流が鮮明になりました。
主な事実と出典(抜粋)
- Reflection AIが大型ラウンドで約20億ドルを調達し、評価額を約80億ドルに引き上げたと報じられています(オープン志向のフロンティアAIを目指す動き)。techcrunch.com
- OpenAIは大規模なAIインフラ投資計画(「Stargate Project」)を進めており、複数サイトでのデータセンター拡張やパートナーとの容量拡大が報じられています。これに伴う資本・電力・水需要の急増が注目されています、openai.com。intuitionlabs.ai
- 自動化/ワークフロー系のn8nはシリーズCで1億8000万ドルを調達し、評価額は約25億ドルと報じられ、エンタープライズ自動化・AIオーケストレーション領域への投資関心が高まっています。crn.com
- 日本国内では、女性向けAI/IT人材育成のMs.EngineerがプレシリーズAで約3.2億円を調達し累計6.5億円に到達したと報じられ、ローカルな人材育成・リスキリングへの資金投下も見られます。thebridge.jp
- 週次の広域データでは、2025年第3四半期においてグローバルVC資金の約46%がAIに流入したとの分析があり、資金の大半がごく一部の大型ラウンドに集中していることが指摘されています。coincentral.com
- 消費者向け生成動画ではOpenAIのSoraが5日で100万ダウンロードを記録、対抗するPixVerseも巨額のユーザー基盤を持つなど、コンテンツ系生成AIでのユーザー獲得競争が激化しています。thebridge.jp
(参考イメージ)


事実から読み取れる意味と示唆
-
大型ラウンドは「フロンティアモデル」と「インフラ」の二極に集中していると考えられます。
- Reflection AIの20億ドル調達は、オープン寄りのフロンティア研究と大規模計算資源投資を両立させる狙いを示しており、投資家が巨大モデル競争に匹敵する「別のフロンティア」への賭けを強めていると考えられます。techcrunch.com
- 同時に、OpenAIのStargateのようなインフラ投資は、AI商用化に伴う「インフラ資本集約性」を際立たせており、投資とエネルギー供給(電力/水)に関する社会的コストと規制対応が今後の焦点になると示唆しています、openai.com。intuitionlabs.ai
- Reflection AIの20億ドル調達は、オープン寄りのフロンティア研究と大規模計算資源投資を両立させる狙いを示しており、投資家が巨大モデル競争に匹敵する「別のフロンティア」への賭けを強めていると考えられます
-
一方で「実務課題解決型」や「自動化」では着実に成長資本が供給されていることが確認できます。
- n8nの大型ラウンドは、企業の業務自動化・AIオーケストレーションが資金の投下対象として確立している事例であり、エンタープライズ側のROI(投資対効果)が明確に評価されていると考えられます。crn.com
- 日本のMs.Engineerの調達は、リスキリング・人材育成という“ソフト面”に対するニーズが資金面でも支持されつつあることを示しており、国内市場では「人材×AIサービス」の組合せに投資機会があると示唆しています。thebridge.jp
- n8nの大型ラウンドは、企業の業務自動化・AIオーケストレーションが資金の投下対象として確立している事例であり、エンタープライズ側のROI(投資対効果)が明確に評価されていると考えられます
-
投資の「偏在」と「波及効果」:市場構造の二層化が進んでいると考えられます。
- グローバルでは資本の大半が数社(OpenAI、Anthropic、Mistral等)へ集中しており、技術的フロンティアを巡る“巨額競争”と、中小スタートアップが狙うニッチな業務改善領域の二層化が進行しています。coincentral.com
- 結果として、中小・国内プレイヤーは「差別化された専門領域(医療AI、法律/コンプライアンス最適化、地域特化のLLMなど)」や「企業向けオーケストレーション」「データパイプライン効率化」といった実利的プロダクトで資金を集める戦略が有効になっていると考えられます(Ms.Engineerやn8nの動きが示す通り)。
- グローバルでは資本の大半が数社(OpenAI、Anthropic、Mistral等)へ集中しており、技術的フロンティアを巡る“巨額競争”と、中小スタートアップが狙うニッチな業務改善領域の二層化が進行しています
実務的な示唆(日本の起業家・投資家向け)
- 大型資本がインフラへ流れる状況では、クラウド/ハードウェア/エネルギー効率化技術や「低コストで高品質のモデルを提供するSaaS化」の構想は投資家にとって魅力的です(インフラのTCO削減は差別化ポイント)。関連の政策・規制(電力、用水、データ主権)に注視してください。openai.com
- 企業向け自動化やワークフローのAI化(n8nのような領域)は、B2Bで短期的に売上を立てやすいため、シリーズA〜Cまでの成長戦略として有効であると考えられます。crn.com
- 人材育成・リスキリング分野(Ms.Engineerの例)は、企業需要と社会課題(DX人材不足、女性参画)を同時に解決できるため、政策連携やCVCからの支援を得やすい領域と考えられます。thebridge.jp
短いまとめ(結論)
- 2025年10月第2週は「巨額ラウンドによるフロンティア/インフラへの資本集中」と「実務的プロダクト(オートメーション、人材育成)への着実な資金流入」が同時並行で進行している週でした。これらは相互に影響を及ぼしあい、インフラ負荷や規制、そして中小スタートアップの差別化戦略が、当面の投資・事業開発の主要テーマになると示唆しています(出典参照:Reflection AI、OpenAI、n8n、Ms.Engineer、グローバルVC動向)、techcrunch.com、openai.com、crn.com、thebridge.jp。coincentral.com
(補足図:資金流入の「二層化」イメージ)
さらに掘り下げや、特定企業(例:Reflection AI、n8n、Ms.Engineer)の資金使途やキャピタル構成を詳細に分析してほしい場合は、どの企業/観点を優先するか指示ください。追加で各出典記事の要約(URL別)も展開できます。
調査のまとめ
2025年10月第2週のAIスタートアップ資金調達レポート:OpenAI、Reflection AI、n8nが牽引するAI投資の新局面
回答
この一週間(2025年10月5日〜...
調査のまとめ
2025年10月第2週のAI資金調達ニュース:Reflection AI、Databricks、そしてWayveの動向
ここ一週間のAIスタートアップの資金調達に関するニュースでは、特に「...
調査のまとめ
2025年10月第2週目のAIスタートアップ資金調達ニュース:Scale AIの10億ドル調達と評価額倍増
回答
データラベリング大手Scale AIが10億ドルを調...
調査のまとめ
2025年10月第2週 AIスタートアップ資金調達トレンド:『週刊東洋経済』のベンチャー分析とOpenAIの巨額インフラ投資
2025年10月第2週(10月5日以降)に特化した日本のAIス...
調査のまとめ
2025年10月第2週目のAIスタートアップ動向:Ms.Engineerが女性AI・IT人材育成で3.2億円調達、グローバルではSoraとPixVerseの動画生成AI競争が激化
####...
調査のまとめ
2025年10月第1週のAIニュース:Ms.Engineerの資金調達とpostalk、Sora、PixVerseの注目動向
ここ一週間(2025年10月5日から10月12日)における日本...
🏷大型ラウンド事例の整理:Reflection AI、OpenAI、Scale AIの中身

大型ラウンド事例の整理:Reflection AI、OpenAI、Scale AIの中身
この一週間で目立ったAI関連の“大型ラウンド”は、主にReflection AIの20億ドル調達と、それを巡る「オープンvsクローズド/国際競争」という文脈、そしてOpenAIの大規模インフラ投資構想(Stargate)に伴う資金動向でした。以下、各社の事実と私見(考察・示唆)を、出典を明示しつつ整理・比較し、投資家やスタートアップ、政策立案者が実務的に使える示唆を提示します。
- Reflection AI — 2億ドル($2B)ラウンドの内容と意義
- 事実(出典付き)
- Reflection AIは2025年10月に20億ドルの資金調達を完了し、企業価値は約80億ドルになったと報じられています、またTechCrunchでも同様に報道されていますreuters.com。techcrunch.com
- 出資者にはNVIDIAをはじめ、Sequoia、Lightspeed、GIC、Eric Schmidtらが名を連ねていると報告されています。techcrunch.com
- 創業者は元DeepMindの研究者で、同社はMoE(Mixture-of-Experts)を含むフロンティア規模のモデルを「オープン(モデルウェイト公開)」の形で提供しつつ、トレーニングデータやフルパイプラインは限定的に保つ、というハイブリッドな“オープン戦略”を打ち出しています。techcrunch.com
- Reflection AIは2025年10月に20億ドルの資金調達を完了し、企業価値は約80億ドルになったと報じられています
- 考察・示唆
- 事実から言えるのは、投資家が「オープン指向のフロンティアラボ」へ巨額を投じることで、技術的な集中(クローズドなフロンティアラボが知能基準を独占するリスク)へのカウンターバランスを期待している点です。言い換えると、投資マネーは単に性能だけでなく「アクセス性」「主権性(sovereignty)」を求める需要にも向かっていると考えられます。techcrunch.com
- Reflection AIの戦略(ウェイト公開+トレーニング資産は制限)は、研究者コミュニティの採用を促しつつ、大口顧客や政府向けには専有サービスで収益化する二重のビジネスモデルを狙うものと示唆できます。これは技術拡散と収益化のトレードオフを巧妙に設計した形であり、競合ラボとの差別化要素です。techcrunch.com
- 事実から言えるのは、投資家が「オープン指向のフロンティアラボ」へ巨額を投じることで、技術的な集中(クローズドなフロンティアラボが知能基準を独占するリスク)へのカウンターバランスを期待している点です
- OpenAI — インフラ(Stargate)と資金動向の重層性
- 事実(出典付き)
- OpenAIは「The Stargate Project」として、今後数年で大規模データセンター網を構築する計画を打ち出しており、公開情報では数年で合計約5,000億ドル(=約$500B)規模の投資を見込む、という記述が存在します(プロジェクト説明)。openai.com
- また、OpenAIは大規模な資金調達(例:ソフトバンク主導で最大400億ドルの調達を目指す報道)が伝えられており、これがインフラ拡張・研究開発資金の源泉になると報じられています。reuters.com
- Stargateは米国内外で複数キャンパスを計画・着工しており(テキサス・ノルウェー・UAE等)、大規模電力供給とGPU調達(NVIDIA等)を伴うインフラ投資です。openai.com
- OpenAIは「The Stargate Project」として、今後数年で大規模データセンター網を構築する計画を打ち出しており、公開情報では数年で合計約5,000億ドル(=約$500B)規模の投資を見込む、という記述が存在します(プロジェクト説明)
- 考察・示唆
- OpenAIの動きは「モデル(アルゴリズム)競争」から「物理的インフラ」と「データ主権」を同時に押さえる戦略に移行していると考えられます。Stargateは単なる設備投資ではなく、米欧/同盟国向けに“主権的に運用可能なAIインフラ”を供給し、地政学的リスクを低減する意図があると示唆できます。openai.com
- また、巨額のインフラ投資は電力・水・サプライチェーン(GPU等)依存性を高め、地域インフラや規制のハードル、コスト上昇リスクを生むため、資金調達の確実性と長期的な事業計画の両方が重要になります(調達報道と実行のギャップに注意)。reuters.com
- 補足的に、最先端モデル(例:GPT-5)やその訓練リソース需要は、こうしたインフラ投資の裏付けになっていると見られます(モデルの訓練コスト・期間の大きさについては公開情報で示唆されています)。openai.com
- OpenAIの動きは「モデル(アルゴリズム)競争」から「物理的インフラ」と「データ主権」を同時に押さえる戦略に移行していると考えられます。Stargateは単なる設備投資ではなく、米欧/同盟国向けに“主権的に運用可能なAIインフラ”を供給し、地政学的リスクを低減する意図があると示唆できます
- Scale AI — 今週の調査での扱いと注意点
- 事実(出典付き)
- 本調査で与えられた出典群(たとえばCrunchbaseの週次まとめ)では、この1週間の「トップの大型ラウンド」一覧にReflection AIやPolymarketなどが挙がっている一方で、Scale AIについての新たな大型ラウンド情報は含まれていません。crunchbase.com
- 本調査で与えられた出典群(たとえばCrunchbaseの週次まとめ)では、この1週間の「トップの大型ラウンド」一覧にReflection AIやPolymarketなどが挙がっている一方で、Scale AIについての新たな大型ラウンド情報は含まれていません
- 考察・示唆
- 要点は「セクターの過熱は限られた複数プレイヤーに資金が集まる」傾向が続いている点で、Scale AI のような(既に資本供給を受けている)企業が必ずしも毎週ニュースの上位に出るわけではないということです。言い換えると、短期的な“トップラウンド”リストだけで業界全体のリーダーシップや健全性を判断するのは不十分だと考えられます。crunchbase.com
- 要点は「セクターの過熱は限られた複数プレイヤーに資金が集まる」傾向が続いている点で、Scale AI のような(既に資本供給を受けている)企業が必ずしも毎週ニュースの上位に出るわけではないということです。言い換えると、短期的な“トップラウンド”リストだけで業界全体のリーダーシップや健全性を判断するのは不十分だと考えられます
- 比較(事実の要約)と図示
- 主要ファクトまとめ
- Reflection AI:20億ドル調達、評価額約80億ドル、オープン指向+トレーニング資産は選択的に保持techcrunch.com。reuters.com
- OpenAI:大規模インフラ「Stargate」計画(数年で数千億ドル規模の投資と報道)および数十億ドル規模の資金調達報道openai.com。reuters.com
- Scale AI:当週のトップ大型ラウンド一覧には該当情報がない(今回のデータセットでは未報告)。crunchbase.com
- Reflection AI:20億ドル調達、評価額約80億ドル、オープン指向+トレーニング資産は選択的に保持
- 簡易フロー(mermaid)
- 下図は「資金の向かう先(モデル開発/インフラ/オープンコミュニティ)」と「期待される効果」を示しています。
(上の図は概念図であり、個々の金額は出典別に参照してください。OpenAIのStargate計画やReflectionのラウンドは下記出典を参照しています。)
openai.com
techcrunch.com
- 投資家/スタートアップ/政策担当者への実務的アドバイス(示唆)
- スタートアップ向け(実践的)
- 差別化の軸を明確に:オープン性(ウェイト公開)でコミュニティの支持を取りつつ、トレーニングパイプラインや商用APIで収益化する「二層モデル」はReflection AIが示した有効なパターンと考えられます。研究者採用や外部コラボを重視する際はこのアンバランスを活用すると良いでしょう。techcrunch.com
- 計算資源とパートナー戦略:大規模モデルやエージェントに関わるなら、単独でGPUを調達するよりもNVIDIA等ハードウェアパートナーやクラウド提携で早期に確保する計画を持つべきです(Reflectionの投資家構成にも示唆があり、OpenAIのStargateは大規模GPU調達が前提です)techcrunch.com。openai.com
- 差別化の軸を明確に:オープン性(ウェイト公開)でコミュニティの支持を取りつつ、トレーニングパイプラインや商用APIで収益化する「二層モデル」はReflection AIが示した有効なパターンと考えられます。研究者採用や外部コラボを重視する際はこのアンバランスを活用すると良いでしょう
- 投資家向け
- ポートフォリオ分散:インフラ(電力・GPU供給)とソフトウェア/モデル開発は異なるリスク(資本密度・規制・供給遅延)を持つため、両者に分散投資することがリスク低減につながると考えられます(OpenAIの巨大インフラ投資が示す通り、インフラは長期の資本拘束を伴う)openai.com。reuters.com
- ガバナンスと実行力の検証:巨額ラウンドほど「実行できる経営・技術チーム」「電力・環境許認可」「サプライチェーン」が成否を分けるため、デューデリではこれらの確認を重視してください(Stargate報道で指摘される課題参照)。openai.com
- ポートフォリオ分散:インフラ(電力・GPU供給)とソフトウェア/モデル開発は異なるリスク(資本密度・規制・供給遅延)を持つため、両者に分散投資することがリスク低減につながると考えられます(OpenAIの巨大インフラ投資が示す通り、インフラは長期の資本拘束を伴う)
- 政策担当者/地域自治体向け
- インフラ準備と環境評価:大規模データセンターは電力・水資源に影響するため、誘致を検討する自治体は電力供給計画・再生可能エネルギー連携・水使用制御を事前に評価すべきです(Stargateの計画に関する報告に同様の懸念が記載されています)。openai.com
- 主権的なAI能力の確保:Reflectionのような「オープンだが制御可能な」ラボと、OpenAIの「主権向けStargate」双方の動きは、各国が自国のAI供給網をどう確保するかという政策的課題を浮き彫りにしています。国際提携と輸出管理のバランスを設計する必要があると考えられますtechcrunch.com。openai.com
- インフラ準備と環境評価:大規模データセンターは電力・水資源に影響するため、誘致を検討する自治体は電力供給計画・再生可能エネルギー連携・水使用制御を事前に評価すべきです(Stargateの計画に関する報告に同様の懸念が記載されています)
- ビューの総括(洞察)
- 今週の大型ラウンド事例から導かれる大きな潮流は「モデル性能だけでない投資評価軸」の台頭です。具体的には「アクセス性(オープン)」「主権性(ローカル運用可能性)」「インフラ確保能力(GPU・電力)」が、資本配分における重要な決定要因になっていると考えられます(ReflectionのラウンドとOpenAIのStargate構想の両方がこれを示唆しています)techcrunch.com。openai.com
- 注目すべきは、これらの動きが単なる技術競争に留まらず、地政学的・インフラ的課題(電力、サプライチェーン、法制度)と密接に絡んでいる点で、関係者は「技術ロードマップ」と「物理的/政策的制約」の両面を同時に見て戦略を立てる必要があると示唆されますopenai.com。reuters.com
参考(主要出典)
- Reflection AI資金調達・戦略(TechCrunch): techcrunch.comknowledgewing.com
- Reflection AI資金調達(Reuters): reuters.comyahoo.co.jp
- OpenAI “The Stargate Project”(公式): openai.comsyosetu.com
- OpenAI 資金調達報道(Reuters): reuters.comhatena.ne.jp
- GPT-5 / OpenAI のモデル動向(公式発表・解説): openai.comusepocket.com
- 今週の大型ラウンド一覧(Crunchbaseまとめ): crunchbase.com5chmm.jp
図版(関連イメージ)


最後に:もしご希望であれば、上記を踏まえて(A)投資家向けの簡潔なDue Diligenceチェックリスト、(B)スタートアップが資金調達時に提示すべき「3つの差別化指標」、または(C)地域自治体向けのStargate誘致時チェックリストを作成します。どれを先に作りましょうか?
🏷インフラとハード投資の潮流:Databricks、Stargate、Nvidiaの役割

インフラとハード投資の潮流:Databricks、Stargate、Nvidiaの役割
ここ一週間(および直近の流れ)を踏まえると、「AIの商用化=モデルだけでなく、その裏側にある巨大なインフラとハード投資」が資金の大きな受け皿になっている点が最も重要な潮流です。本節では、Databricksの大型ラウンド(ソフトウェア/データ層強化)、OpenAIを含むStargateプロジェクト(超大規模データセンター計画)、そしてNvidiaの二重役割(チップ供給者かつ投資家)を軸に、事実提示→影響考察→比較対照→実務的示唆の順で整理します。
主要事実(要点)
- DatabricksはシリーズKで約10億ドルを調達し、時価総額が1000億ドル($100B 超)に達したと報じられています。調達資金はAgent BricksやLakebaseといった「AIエージェント/エージェント向けデータ基盤」の開発拡大、買収、グローバル展開に充てられるとされています。crn.com
- 「Stargate」と呼ばれる超大型インフラ構想(OpenAI・Oracle・ソフトバンク等が関与、数百億〜数千億ドル規模で報道される)により、米国内で大規模データセンター群が計画・建設されており、テキサス州アビリーンなどでは複数の施設建設が進行中です、https://www.bigcountryhomepage.com/news/stargate-abilene/abilenes-data-center-advances-swiftly-with-5000-workers/。techcrunch.com
- Nvidiaは単なる半導体ベンダーに留まらず、巨額のチップ供給・投資によってAIインフラとスタートアップ資金循環の中心に位置しています。近年はOpenAIや多数のAIスタートアップへの出資や大規模契約が続き、投資活動自体が同社戦略の重要要素になっています、https://www.reuters.com/business/nvidia-invest-100-billion-openai-2025-09-22/。techcrunch.com
これら事実が意味すること(分析と示唆)
-
ソフトウェアプラットフォーマーの「再資本化」と差別化投資:Databricksの10億ドル調達は、もはや「単なるデータ処理サービス」から「エージェント化・本番運用のためのデータ基盤(Lakebase)を確立する企業」への飛躍を志向していることを示しています。エージェント運用は運用データベースや実行基盤との連携が不可欠であり、言い換えると「ソフトウェア屋がハード/インフラに依存しないで価値を作るための投資」を加速していると考えられます。crn.com
-
インフラの規模が資本構造/ビジネスモデルを歪める:Stargateのような巨大なデータセンター計画は、建設・電力供給・長期契約が不可欠であり、結果として「クラウド/ハードベンダーとAI事業者の長期的な資本関係」を生みます。これは、他方で指摘される「循環的ファイナンス(企業が顧客に投資して製品を買わせる)」やベンダー依存のリスクを高めると考えられます。techcrunch.com
-
Nvidiaの二重役割が市場の”信号”になる:NvidiaはGPU供給で需要を生み、その現金を投資に回すことでエコシステムをさらに自社に有利に拡大しています。つまりNvidiaの投資先や取引構造を追うことは、市場が次にどのインフラ領域へ資本を注ぐかを予測する強い指標になると考えられます、https://www.reuters.com/business/nvidia-invest-100-billion-openai-2025-09-22/。techcrunch.com
-
物理的制約(電力・建設能力)が成長のボトルネックに:大規模データセンターの電力需要は地域の電力網や家庭の電気代にも波及する懸念が報じられています。電力供給や環境負荷の観点は、インフラ投資を評価する際の重要な変数であり、過剰建設が長期的な資産非稼働リスクを生む可能性があります、techcrunch.com。hatena.ne.jp
対照・比較(Databricks vs Stargate型 vs Nvidia主導型)
- Databricks型:ソフトウェアとデータ基盤に資本を投入して「サービスでの差別化」を図る。相対的に資本集約は低いが、顧客の本番運用要件(低遅延・データ整備)に応えるためにインフラ連携が必須。crn.com
- Stargate型(超大規模物理インフラ):土地・電力・建設・長期契約が中心。規模の経済は効くが、資本回収までのリスクと地域インフラ依存が大きい、https://www.bigcountryhomepage.com/news/stargate-abilene/abilenes-data-center-advances-swiftly-with-5000-workers/。techcrunch.com
- Nvidia主導型:チップ販売で需給を作りつつ、投資でエコシステムをコントロール。短期的には市場の中心的プレイヤーとなるが、独占的な資本循環の批判や「バブル懸念」の対象にもなる、techcrunch.com。bbc.com
実務的な示唆と推奨(投資家・スタートアップ・事業担当者向け)
-
投資家へ:Nvidiaの投資先や主要インフラ契約は「業界の熱点」を示すシグナルになりますが、同時に循環的ファイナンスや過剰設備のリスク(バブル的側面)もあるため、資本回収のロードマップ(顧客契約の長期性、電力契約、稼働率見積り)を厳密に点検することを推奨します、techcrunch.com。bbc.com
-
スタートアップ(ソフト系)へ:Databricksの動きが示すように「エージェント運用での差別化」は成長経路の有効な一手です。一方でハード側(データセンター、GPU供給)との連携戦略を早期に確立し、供給チェーンやクラウド/オンプレ環境での冗長化を設計することが重要です。crn.com
-
事業会社/調達担当へ:大口のインフラ投資や長期GPU供給契約は短期的な技術優位を生みますが、エネルギー料金や地域規制、環境配慮(発電形態)による外部コストの変動を契約条項に織り込むべきです。電力不足や料金上昇が顧客の運用コストを押し上げるリスクは現実味を帯びています、techcrunch.com。hatena.ne.jp
簡潔な関係図(概念):
視覚資料(参考イメージ)



(出典:上記イメージはAI投資・インフラ拡張の文脈で報じられた報道写真を参照しています)
bbc.com
結論的洞察(まとめ)
- 今回の潮流を一言で言うと、「資本はモデル(ソフト)から物理インフラへと大規模に流れ、そこにNvidiaのようなハード企業が『供給+投資』の二重役割で影響力を強めている」という構図です。Databricksのようなソフト側の大型調達は、ソフトがインフラに依存する局面での差別化(Agent BricksやLakebase)を狙う動きと捉えられます。crn.com
- ただし、電力・地域インフラ・資本循環の脆弱性といった実物的制約は無視できません。Stargateのような大規模案件は技術進展を後押しする一方で、長期的な経済性・環境負荷の検証を要求すると考えられます、techcrunch.com。hatena.ne.jp
必要であれば、次のアクション案として(1)Databricks・Nvidia・Stargateそれぞれの短中期ロードマップのウォッチリスト(契約締結日、稼働開始予定、主要出資者)や(2)投資リスク評価テンプレート(電力・稼働率・依存関係)を作成します。どちらが優先か、あるいは両方とも準備するかご指示ください。
調査のまとめ
現在の調査結果には、ユーザーの皆様が求められている「ここ一週間のAIスタートアップの資金調達に関するニュースをトピックごとにまとめ、分析する」ための具体的な情報が見当たりませんでした。そのため、主要な...
🏷専門領域での勝ち筋:n8n、Trismik、Wayveに見る差別化戦略

専門領域での勝ち筋:n8n、Trismik、Wayveに見る差別化戦略
ここ一週間の資金調達ニュースを「専門領域で勝つための戦略」という観点で整理すると、共通するテーマは「高度化したドメイン知見を如何にプロダクト化して企業の業務フローに埋め込むか」という点に集約されます。本節では、まず事実を整理し(出典明示)、その意味を掘り下げ、最後に投資家/創業者向けの実践的示唆を提示します。
事実(調達の要点)
- n8n:AIエージェント/業務オーケストレーション領域のn8nは、シリーズCで1億8000万ドルを調達し、評価額は25億ドルに達したと報じられています。出資ラウンドはAccel主導、NVentures(Nvidia)らが参加しており、同社はエンタープライズ向けに3,000以上の顧客を抱え、年間経常収益(ARR)が4,000万ドル超であるとされています。crn.com
- Trismik:英国ケンブリッジ拠点のTrismikは、LLM評価(大規模言語モデルの評価)に特化したプレシードで220万ポンドを調達したと発表されています(科学グレードの評価を掲げるスタートアップ)。linkedin.com
- Wayve:今回の調査結果(提示されたソース群)では、Wayveに関する直近一週間の資金調達記事は確認できませんでした。したがって以下ではWayveを「自動運転/モビリティ領域の代表的プレイヤー(資本集約かつハードウェア/データの複合競争)」という文脈で参照しつつ、提示された事実(n8n・Trismik)を中心に分析します(Wayve固有の最近の調達事実が必要であれば追加調査します)。

(出典例:BRIDGEの記事中のビジュアル。今回の分析の主要事実は上記のn8n・Trismik出典に基づきます、。)
crn.com
linkedin.com
事実から読み取れる意味・示唆
-
「オーケストレーション(n8n)」と「評価・ベンチマーキング(Trismik)」――役割の差別化が資本評価に直結している
- n8nは単にモデルを作る会社ではなく、企業が複数のAI/ツールを“業務として動かす(オーケストレーション)”レイヤーを提供しており、その実績(顧客数・ARRの伸び)を背景に大型ラウンドを実現しています。これは「モデル性能」だけでなく「モデルを使って実際に運用・成果を出す仕組み」を提供できるかが投資判断で重視されていることを示唆しています。crn.com
- 一方、Trismik のようなLLM評価に特化したスタートアップが資金を得ていることは、モデルの「品質・信頼性」を独立に担保するニーズが高まっていることを示しています。つまり、生成モデルの普及に伴い「何が良いモデルか」を第三者的に示す能力が市場価値を持つようになっています。linkedin.com
- n8nは単にモデルを作る会社ではなく、企業が複数のAI/ツールを“業務として動かす(オーケストレーション)”レイヤーを提供しており、その実績(顧客数・ARRの伸び)を背景に大型ラウンドを実現しています。これは「モデル性能」だけでなく「モデルを使って実際に運用・成果を出す仕組み」を提供できるかが投資判断で重視されていることを示唆しています
-
プラットフォーム連携と大手パートナーの意味(n8nの事例)
- n8nラウンドにNVentures(Nvidia)などが参加している点は、AI基盤(ハードウェア/クラウド)プレイヤーと業務オーケストレーション層の連携が戦略的に重要視されていることを示唆します。言い換えれば、ソフトウェア側の「導入・運用力」とハードウェア側の「計算/推論供給力」が結びつくことで、顧客向けの提供価値が増幅されると考えられます。crn.com
- n8nラウンドにNVentures(Nvidia)などが参加している点は、AI基盤(ハードウェア/クラウド)プレイヤーと業務オーケストレーション層の連携が戦略的に重要視されていることを示唆します。言い換えれば、ソフトウェア側の「導入・運用力」とハードウェア側の「計算/推論供給力」が結びつくことで、顧客向けの提供価値が増幅されると考えられます
-
ドメイン特化の“深さ”とプロダクト化の“広さ”の両立が勝ち筋
- Trismikは「LLM評価」という非常に専門性の高いニッチで資金を確保しました。これは「専門知見を科学的に体系化し、ツールとして提供する」ことで差別化できることを意味します。linkedin.com
- n8nは逆に複数ツールやデータソースを横串でつなぐ“幅”を持ちつつ、企業ユースに耐える“深さ”を提供している。両者を比較すると、どちらのアプローチも市場のニーズ(信頼性/運用性)を満たしている点で評価されていると考えられます、crn.com。linkedin.com
- Trismikは「LLM評価」という非常に専門性の高いニッチで資金を確保しました。これは「専門知見を科学的に体系化し、ツールとして提供する」ことで差別化できることを意味します
-
Wayve 型(自動運転)との対比で見えること:資本構造と差別化要因の違い
- 自動運転領域はデータ量・実装コスト・規制対応が厳しく、Wayveのような企業はハードとソフトの両面で大規模資本が必要になります(本調査の提示ソースにWayve直近の調達は含まれていないため、ここでは業界一般の特性として述べます)。言い換えると、評価・オーケストレーションのように「ソフト的に短期間で価値化できる差別化」とは投資の回収ラグが異なるため、スタートアップの勝ち筋(ニッチ深耕 vs 資本集約スケール戦略)は領域によって大きく変わると考えられます(Wayve固有の最新ラウンドを示す出典が必要なら追加調査を推奨します)。
事実→考察→統合的洞察
- 事実:n8nは大規模なエンタープライズ導入実績と高い成長率で大型ラウンドを実現し、TrismikはLLM評価の専門性で早期資金を獲得した、crn.com。linkedin.com
- 考察:投資家は単なる「アルゴリズム性能」ではなく、「実際の業務で効果を出す仕組み(運用性・オーケストレーション)」、あるいは「評価・信頼性を提供できる第三者的機能」に対してプレミアムを付け始めていると考えられます。言い換えると、プロダクトの“適用可能性(applied value)”が資本評価を左右しているのです。
- 統合的洞察:短中期的には「ドメイン深耕+プロダクト化力(運用/統合/評価)」が資金調達成功の鍵であり、これができない汎用的プレーヤーは差別化が困難になると示唆されています。これは、異なる領域(例:自動運転のような資本集約領域)での勝ち筋と比べて、ソフト領域では“ソフトウェア的な速い価値化”が可能であることが投資家にも評価されている、という形で表れていると考えられます、crn.com。linkedin.com
実務的示唆(創業者・投資家向け短期アクション)
-
創業者向け(プロダクト戦略)
- 「業務への埋め込み」を最優先にする:POCで終わらせず、標準化された導入パス(RACI・SLA・オンボーディング)を早期に用意すること。n8nの成長はこの「運用の実現力」が核です。crn.com
- 信頼性・評価機能をプロダクト化する:Trismikのように、モデルや推論の品質を数値化・説明可能にする機能は顧客の導入障壁を下げ、差別化につながります。linkedin.com
- 「業務への埋め込み」を最優先にする:POCで終わらせず、標準化された導入パス(RACI・SLA・オンボーディング)を早期に用意すること。n8nの成長はこの「運用の実現力」が核です
-
投資家向け(デューデリジェンス時のチェックポイント)
- 「導入実績の深さ(顧客リテンション、ARR成長率、導入までのリードタイム)」を重視する。n8nは導入実績/収益成長を示している点が評価に直結しました。crn.com
- 「第三者評価やベンチマークのエコシステム」への関与を確認する。Trismikのようなプレーヤーは“評価の基準”を作れるかが勝ち筋になり得ます。linkedin.com
- 「導入実績の深さ(顧客リテンション、ARR成長率、導入までのリードタイム)」を重視する。n8nは導入実績/収益成長を示している点が評価に直結しました
-
KPI(短中期・推奨)
- 顧客維持率(Net Revenue Retention)&導入から有効化までの平均日数
- ARR成長率(四半期ごと)と顧客あたりのARPU(収益性)
- モデル/機能の信頼性指標(評価スコア、誤応答率、説明可能性メトリクス)
結び(現場での使い方と次の調査)
今回の週次ニュースで明確になったのは、「専門性を深めてプロダクトとして定着させること」が資本市場で価値化されている点です。n8nのような“オーケストレーション・プラットフォーム”と、Trismikのような“評価・ベンチマーキング”は、表面的には異なるが、いずれも企業の現場で「再現可能な成果」を出すことにコミットしている点で共通しています、。
最後に補足すると、Wayveのような自動運転プレイヤーは別種の勝ち筋(大規模な資本と長期のデータ蓄積)が必要であり、今回の調査結果にはWayve固有の最新資金調達記事は含まれていません。もしWayveを中心にした比較分析をご希望であれば、追加で当該週のグローバルニュースソースを横断して調査し、同様に出典付きでご報告します。
crn.com
linkedin.com
最後に補足すると、Wayveのような自動運転プレイヤーは別種の勝ち筋(大規模な資本と長期のデータ蓄積)が必要であり、今回の調査結果にはWayve固有の最新資金調達記事は含まれていません。もしWayveを中心にした比較分析をご希望であれば、追加で当該週のグローバルニュースソースを横断して調査し、同様に出典付きでご報告します。
参照(本文中出典)
- n8n の資金調達および事業概況: crn.com
- Trismik のプレシード調達: linkedin.com
ご要望があれば、
- Wayve(自動運転)を含めた追加の資金調達・事業動向(出典付き)を調査、または
- 上の「実務的示唆」をもとに創業者向けのGT M(Go‑to‑Market)チェックリストを作成、
いずれか対応します。どちらをご希望でしょうか?
...
🏷国内エコシステムの動き:Ms.Engineer、三井不動産CVC、Sora/PixVerseの示唆

国内エコシステムの動き:Ms.Engineer、三井不動産CVC、Sora/PixVerseの示唆
画像:






要約(事実→示唆の流れ)
- 事実:女性向けAI・IT人材育成のMs.EngineerがプレシリーズAで約3.2億円を調達し、累計約6.5億円となったことが報じられています1。
- 事実:三井不動産とグローバルブレインが総額200億円規模のCVCファンドを設立すると発表しています2。
- 事実:消費者向けのAI短編動画領域ではSoraが5日で100万DL、PixVerseがユーザー1億人突破といった急成長の事例がTech Dailyで取り上げられています(資金調達の記述は同記事に限定的)3。
- これらの事実を総合すると、「人材育成(供給)・企業資金(需要)・消費者向けプロダクトのバイラル成長(市場機会)」という3つの要素が同時に動き、国内エコシステムの“次フェーズ”を示唆していると考えられます。
事実の検証と個別考察
-
Ms.Engineer:人材育成に資金が入る意義
- 出典の通り、Ms.EngineerはプレシリーズAで約3.2億円調達を完了し、女性のAI/ITリスキリングにフォーカスしていることが確認できます1。
- 意味すること:言い換えると、資金供給側(投資家)が「人材パイプラインの整備」を成長戦略として評価していると考えられます。つまり、プロダクトやプラットフォームへの投資だけでなく、人材育成に直接資本を投じる流れが出始めているのです。これは中長期的にプロダクト開発・事業立ち上げのスピードを上げ、国内でのAIサービスの品質安定化に寄与すると示唆しています。
-
三井不動産×グローバルブレインのCVC(200億円):戦略的資本の増加
- 三井不動産とグローバルブレインによる総額200億円のCVC新設は、企業がスタートアップへの直接投資を通じて事業連携やオープンイノベーションを強化する動きの表れです2。
- 示唆:言い換えると、不動産や大企業系の戦略資本がよりアクティブになっており、(1)社内リソースとスタートアップの技術を組み合わせる協業、(2)M&Aや業務提携を視野に入れた段階的な支援、という選好が強まっていると考えられます。これは「単なるファイナンス」から「戦略的パートナーシップ」へ資金の性格が変化していることを意味します。
-
Sora/PixVerse:消費者向けAIプロダクトの“バイラル成長”
- Tech Daily記事はSoraの短期間でのダウンロード急増や、PixVerseのユーザー1億人突破を取り上げ、ミーム動画プラットフォームの競争激化を伝えています3。資金調達の詳細は同記事で限定的ですが、ユーザー成長の速さはエグジットや大型投資の前提条件になります。
- 示唆:消費者向けAIアプリが“短期で熱狂的に成長する”ケースが増えており、プロダクトのバイラル性やテンプレート戦略が資本を引き寄せる一因になっていると考えられます。投資家は「成長の速度」と「マネタイズの道筋(あるいは将来の買収・IPO)」をより重視する局面に入っていると示唆できます。
事実間の関係性から導く洞察(専門家的視点)
- 人材育成(Ms.Engineer)×戦略的資本(CVC):CVCは短期の事業連携だけでなく長期的なエコシステム構築を視野に入れて投資するため、人材育成への投資は“勝ち筋”を増やします。つまり、良質な人材プールが育つほど、CVCの投資先候補の成功確率が上がる、という好循環が生まれると考えられます12。
- 消費者プロダクトの台頭は“資金配分の二極化”を促すと考えられます。すなわち、(A)成長速度が速い消費者向けAIは大型の成長資金や戦略投資を呼び込みやすく、(B)インフラや人材育成のような基盤系はやや長期の投資に回される傾向が強まる、という二層構造が見えてきます31。
実務的な示唆(アクションプラン)
- スタートアップ(創業者)向け:CVCの意向は「事業連携や実証を通じたスケール」にあるため、単に資金を求めるだけでなく、どのように企業との協業で現場価値を出すか(PoC設計、KPI提示、導入の段取り)を明文化して提案すると受け入れられやすいです2。
- 投資家/CVC向け:人材育成・多様性への投資(例:Ms.Engineerのようなリスキリング事業)は、中長期での投資リターンとエコシステム強化の両面で効果が期待できるため、ポートフォリオの一部に組み入れることを検討すべきです1。
- 政策・支援機関向け:バイラルな消費者向けAIが注目を集める一方で、基盤的人材育成は市場の“安定供給”に不可欠です。補助金や税制優遇でリスキリング事業を後押しすると、産業全体の底上げに繋がると考えられます1。
短期的に注視すべき点(来週以降のウォッチリスト)
- CVCの具体的なファンド運用方針(領域別の割当や第1弾投資先の公開)2。
- Sora/PixVerseのマネタイズ動向(広告・サブスク・SDK提供など)と、それに伴う追加ラウンドの有無3。
- 人材育成スタートアップの卒業生就職先データ(企業側の受け入れ状況)—供給側の効果測定指標として重要です1。
結び(洞察の再提示)
総じて、ここ一週間の日本のAIエコシステムは「人的インフラの整備(Ms.Engineer)」「企業主導の資本(CVC)」「消費者向けAIの爆発的成長(Sora/PixVerse)」という三つの潮流が同時に顔を出しつつあります。言い換えると、資金と人材とプロダクトの三角形が収束しつつあり、この三点のバランスをうまく取れるプレイヤー(人材育成+技術+企業連携を設計できる組織)が次の1〜2年で優位に立つと考えられます123。
参考(直接出典)
(補足)postalkやRAMENTECH取材記事など、技術面のトレンドも確認されており、会議用AIや業務支援系の技術成熟も併走している点は留意に値します4。
...
🏷資金フロー分析:集中化・中東マネー・VC配分の構造変化

資金フロー分析:集中化・中東マネー・VC配分の構造変化
ここ一週間(および直近四半期)の公表情報を横断すると、AIスタートアップへの資金フローには「(1)巨額ラウンドによる資金の上位集中化、(2)中東ソブリン/新興ファンドの存在感、(3)AI関連ハードウェアやインフラへのシフト」という三つの明確な潮流が見えてきます。以下では、確認できる事実を出典とともに列挙し、その意味と実務的インパクトを専門家視点で解釈します。
事実(出典)
- Reflection AIは最新ラウンドで20億ドルを調達し、評価額を約80億ドルに引き上げたと報じられています(同社のブログおよびTechCrunch記事)、reflection.ai。techcrunch.com
- 一方で、2025年第3四半期はAIへのベンチャー資金流入が突出しており(グローバルVCの大きな割合をAIが占める)、チップ/インフラ寄りの資金も目立つことが報告されています。半導体・AIチップ分野のQ3資金調達では合計で数十億ドル規模の大型ラウンドが複数(例:Cerebrasの11億ドル、Groqの7.5億ドルなど)発生しています。semiengineering.com
- グローバル投資動向を俯瞰すると、AIスタートアップが全VC資金の大きな割合(報道例では約46%)を占めるという指摘があり、特に米国が主要受け皿であるとの分析があります。主要大型ラウンド(Anthropic、xAI、Mistralなど)が全体のマグニチュードを牽引しているとの報告もあります。coincentral.com
- また、中東系の資本(UAEやサウジなど)や国策的投資は、AIデータセンターやAIハブ建設を通じて存在感を示しており、その過熱ぶりと持続可能性に対する懸念が論点になっています(批評的な論説・調査が存在)。note.com
これらの事実が意味するもの(考察)
-
資金の「集中化」と勝ち筋の二極化
大型ラウンド(数億〜数十億ドル規模)が市場全体の資金額を牽引していることは、資本の集中化を意味します。言い換えると、巨額資金を持つプレイヤーに市場の期待が集まりやすく、プラットフォーム的優位(モデル、データ、インフラの三点セット)を持つプレイヤーが加速度的に有利になると考えられます。Reflection AIの20億ドル調達は、フロンティアモデルの「資本競争」を反映しており、資金が「最先端モデルと巨大GPU占有」に集中する傾向を示しています。techcrunch.com -
中東マネーは量的インパクトと地政学的戦略性を同時に持つ
中東からの大規模投資は単なる資本供給に留まらず、「国家レベルでのAIハブ構築」「主権AI(Sovereign AI)やデータセンターの誘致」といった戦略的効果をもたらすため、短期的なラウンド応援だけでなくインフラ長期投資を促進します。しかし、過剰設備や電力コストの回収不確実性など、バブル化リスクも指摘されています。言い換えると、資本流入の量は大きくとも「回収と需要の実態」が伴わないと、国家・事業側双方に負担が残る可能性があると考えられます。note.com -
VC配分の構造変化:ソフトウェア→モデル→インフラ(ハード+ネットワーク)へ
第3四半期の動きでは、モデル開発だけでなく、計算資源・データセンター・ネットワーキング・専用チップ等のインフラに大きな資金が流れています。これは、実際に運用・スケールするための「コスト要因(GPU/電力/帯域)」が投資家の関心項目になったことを示唆しています。つまり、単なるモデルの優位性だけではなく「コスト効率とデプロイ能力」がビジネス成功の鍵になりつつあると考えられます。semiengineering.com
出典間の対照と注意点
- 大型ラウンドの額や企業ごとのシェアに関する報道は、集計方法や期間の違いで数字に乖離が出ます(例:CRNの企業ごとの調達要約と、四半期集計を行うメディアの数値は必ずしも一致しません)、crn.com。したがって、投資判断では「定性的なトレンド(集中化・インフラ重視・地政学的資本)」を重視しつつ、個別数値は当該ソースの定義と範囲を確認する必要があります。coincentral.com
実務的な示唆(投資家・創業者向け)
- スタートアップ側:資本効率(GPU使用量の最適化、RAGやリフレクションなどのソフト的最適化)で差別化することが、巨額競争に対する実効的な防衛線になると考えられます(Reflection Tuningやエージェント設計の技術的手法は、コストと精度の両立に資すると見られます)。galileo.ai
- VC/LP側:トップ集中化リスクに対しては、ポートフォリオを「フロンティア・モデル」「インフラ(チップ、冷却、ネットワーク)」「応用レイヤー(業務自動化、エージェント)」に分散することで、技術的なベットを分散することが有効と考えられます、semiengineering.com。coincentral.com
- 地域戦略:中東マネーを資金源として活用する場合、電力・稼働率・長期オペレーションプランの現実性を精査し、短期の評価跳ね上がりに乗るだけでなく「オフテイク/稼働保証」などの契約構造を検討すべきと考えられます。note.com
図解:資金フロー(概念図)
参考図(技術説明の補助)


主要出典(本文で引用した代表例)
- Reflection AIのラウンドと戦略(Reflectionブログ & TechCrunch): ,reflection.aitechcrunch.com
- AIスタートアップ総覧と注目企業(CRN):crn.com
- グローバルVCのAI集中(メディア集計):coincentral.com
- チップ/インフラ分野の大型調達(SemiEngineeringのQ3レポート):semiengineering.com
- 中東マネーとリスクに関する評論:note.com
- Reflection tuning(自己修正型LLM手法、コストと有効性):galileo.ai
まとめ(洞察)
短期的には「資金の上位集中化」と「インフラ重視」の二つが同時進行しています。言い換えると、資金は“モデルそのもの”と“その実行に必要な物理的資本”の双方に流れており、それが勝者総取り型の市場構造を強めると考えられます。したがって、創業者は「資本効率」と「差分化されたプロダクト(特定業務領域での高付加価値)」に注力し、投資家は「集中リスク」と「地政学的資本の持続可能性」を見極めた上で配分を検討することが重要だと考えられます。
短期的には「資金の上位集中化」と「インフラ重視」の二つが同時進行しています。言い換えると、資金は“モデルそのもの”と“その実行に必要な物理的資本”の双方に流れており、それが勝者総取り型の市場構造を強めると考えられます。したがって、創業者は「資本効率」と「差分化されたプロダクト(特定業務領域での高付加価値)」に注力し、投資家は「集中リスク」と「地政学的資本の持続可能性」を見極めた上で配分を検討することが重要だと考えられます。
🏷インパクトと示唆:投資家・創業者が取るべき戦術とリスク対策

インパクトと示唆:投資家・創業者が取るべき戦術とリスク対策
要約(1行)
- この一週間の動きから読み取れる潮流は「データインフラ/ラベリングへの大型資金」「ワークフロー→認知エージェントへの移行」「VCのネットワーキング活発化/資金供給の集中」であり、投資家・創業者はデータモノポリー、ガバナンス、実需連携を中心に戦術を立てるべきだと考えられます(以下、事実とその示唆を出典付きで整理します)。
主要事実と示唆(事実→考察の順で提示)
-
大型ラウンドと「データ」が評価軸になっている
- 事実:データラベリングのScale AIがシリーズFで10億ドルを調達し、評価額が138億ドルに倍増したと報じられています。同社は自動運転やNLP向けのアノテーション大規模提供で主要顧客を抱え、資金をAGIに向けた「フロンティアデータ」加速に使うと表明していますtechcrunch.com。techcrunch.com
- 示唆:言い換えると、「高品質なラベル付け・データパイプライン」を持つ事業は、モデルのコストや性能競争の中で長期的に差別化しやすく、投資家はここを“ディフェンシブなインフラ投資先”と見なしていると考えられます。techcrunch.com
- 事実:データラベリングのScale AIがシリーズFで10億ドルを調達し、評価額が138億ドルに倍増したと報じられています
-
「ワークフロー自動化」から「自律エージェント」へ―ツール選定が事業戦略を左右
- 事実:OpenAIのAgentKitは「計画・実行・自己評価が可能なエージェント」を志向し、従来型のノードベース自動化ツール(例:n8n)は「決定論的ワークフローのオーケストレーション」に強みがある、と比較分析されています。medium.com
- 補強事実:n8nを用いた実務テンプレート(SERP分析や競合分析の自動化)やノーコードの競合分析システム事例が複数公開されており、既存業務の自動化需要は依然高いことが示されています、youtube.com。youtube.com
- 示唆:簡潔に言うと、組織が「再現性ある自動化」で価値を取るのか、「不確実な意思決定を代行する認知的エージェント」で差をつけるのかがプロダクト戦略の分岐点になり得ます。投資家はポートフォリオで両側面(データ・自動化基盤と認知エージェント)をバランスさせるべきと考えられます、medium.com。youtube.com
- 事実:OpenAIのAgentKitは「計画・実行・自己評価が可能なエージェント」を志向し、従来型のノードベース自動化ツール(例:n8n)は「決定論的ワークフローのオーケストレーション」に強みがある、と比較分析されています
-
エコシステムでの資金マッチングとネットワーキングは加速している
- 事実:Startup World Cupの世界決勝(10/15–17、サンフランシスコ)には400名超のトップVCが集結すると発表されており、国際的な資金供給とピッチの場が集中していますPR(Startup World Cup)、公式案内Startup World Cup。
- 示唆:短期的な資金獲得のチャンスはイベントを中心に流動化するため、創業者は「イベントでのストーリーテリング」と「事前のVCターゲティング」をきめ細かく準備する必要があると考えられますhttps://is.gd/Nl85D4。
-
バブル・過熱リスクと資金源の地政学的偏り
- 事実(警告):中東マネーなどの大量流入がAI界隈の過剰評価を助長しているとの批評的指摘があります(「中東マネーが煽るAIバブル」等)。note.com
- 示唆:言い換えると、大口資金は一時的なバリュエーション・エクスポージャーを生むため、投資家はリスク管理(落ち着いたマルチシナリオDD)を徹底すべきで、創業者は“ユニットエコノミクス”と「実顧客の支払い意欲(WTP)」で説得力を作る必要があると考えられます。note.com
- 事実(警告):中東マネーなどの大量流入がAI界隈の過剰評価を助長しているとの批評的指摘があります(「中東マネーが煽るAIバブル」等)
実務的な戦術(投資家向け)
-
データ/ラベル供給チェーンの「独占性」を評価する
- 確認項目:データソースの排他性、ヒューマン・イン・ザ・ループ運用の再現性、顧客の乗り換えコスト(顧客ロックイン指標)。参考にScale AIの事例をDDのベンチマークにすることを推奨します。techcrunch.com
- 確認項目:データソースの排他性、ヒューマン・イン・ザ・ループ運用の再現性、顧客の乗り換えコスト(顧客ロックイン指標)。参考にScale AIの事例をDDのベンチマークにすることを推奨します
-
「エージェント化」へのポートフォリオ配分
- 戦術:自動化(n8n等)を使う企業と、AgentKit型の認知系企業の両方を少量ずつ試験投資し、1年以内に顕在化するKPI(顧客継続、TAMの拡大、コスト削減)でリバランスする。medium.com
- 戦術:自動化(n8n等)を使う企業と、AgentKit型の認知系企業の両方を少量ずつ試験投資し、1年以内に顕在化するKPI(顧客継続、TAMの拡大、コスト削減)でリバランスする
-
イベント/LPネットワーク活用を前提にしたデューデリジェンス
- 戦術:Startup World Cupや類似の国際イベントで事前に「面談日程」を固め、現地でのPoC/顧客紹介を条件にタームシートの優先権を検討することが有効ですhttps://is.gd/Nl85D4。
実務的な戦術(創業者向け)
-
プロダクト戦略の明確化:自動化か認知エージェントか
- 指針:B2Bで「プロセスの確実性(再現性)」を売るならn8n的アプローチ、ユーザーの意思決定を代替して高付加価値を提供するならAgentKit的エージェント化を目指すべきです、medium.com。youtube.com
- 指針:B2Bで「プロセスの確実性(再現性)」を売るならn8n的アプローチ、ユーザーの意思決定を代替して高付加価値を提供するならAgentKit的エージェント化を目指すべきです
-
早期に「データ契約」とSLAを確定する
- 実行:顧客とのデータ供給/利用に関する権利範囲、匿名化・品質保証・再販権を明示し、投資家に示せる契約アセットにする(Scaleの評価は“データの豊富さ”という定量的主張が評価につながった例として参考)。techcrunch.com
- 実行:顧客とのデータ供給/利用に関する権利範囲、匿名化・品質保証・再販権を明示し、投資家に示せる契約アセットにする(Scaleの評価は“データの豊富さ”という定量的主張が評価につながった例として参考)
リスク管理チェックリスト(投資家・創業者共通)
- バリュエーションの耐性シナリオ(強気/中立/弱気)を作る(収益・継続率・コストの感度分析)。参考:過熱警戒の議論。note.com
- モデル・セーフティとコンプライアンス(ガバナンス)を初期から組み込む(データ取り扱い、説明責任、監査ログ)。生成AIの規制や安全性議論は引き続き重要であると指摘されています。nikkei.com
- スケール時の運用コスト(トークン/インフラ)を前提にした「収益モデル」を明確化する(特にAgent系は推論コストが重い)。
意思決定サマリ(結論)
- 投資家は「データ供給チェーン」と「認知エージェント化」という二つの大きな潮流を同時に評価・監視すべきであり、短期的にはイベントやネットワーク(例:Startup World Cup)での視察を通じて質の高い案件に当たることが有効と考えられます、https://is.gd/Nl85D4。techcrunch.com
- 創業者は「どの市場ニーズを満たすのか(自動化 vs 認知)」を明文化し、データ契約・顧客SLA・ユニットエコノミクスに基づく資金計画を示すことで説得力を高めるべきだと考えられます、medium.com、youtube.com。techcrunch.com
補足(参照した主要ソース)
- Scale AI(TechCrunch記事): techcrunch.com
- OpenAI AgentKit vs n8n(Medium): medium.com
- n8nテンプレート/事例(YouTube): ,youtube.comyoutube.com
- n8n代替レビュー(Vellum/比較): vellum.ai
- Startup World Cup(公式/案内): https://www.startupworldcup.io/grand-finale , チケット案内等: https://is.gd/Nl85D4
- AIバブルに関する批評(Note): note.com
- 参考画像(Scale AI): https://techcrunch.com/wp-content/uploads/2024/05/3624657-Screen_Shot_2023-01-04_at_12.55.11_PM-e1716289806957.png?w=680
- 参考画像(Startup World Cup バナー): https://prcdn.freetls.fastly.net/release_image/44738/156/44738-156-e5e80a94d5bc1445a37ab3fa159ebb70-2311x1641.png?width=536&quality=85%2C75&format=jpeg&auto=webp&fit=bounds&bg-color=fff
簡潔な次のアクション(短期)
- 投資家:来週の主要イベント参加リストを作り、該当する創業者と事前面談を確約する(投資の温度感を現場で確かめる)。参考: Startup World Cup案内https://is.gd/Nl85D4。
- 創業者:Pitch資料に「データ供給の独自性」「SLA・契約書の要点」「1–2年のユニット経済シナリオ」を必ず加える(Scale事例をベンチマークに)。参考: Scale資金調達記事。techcrunch.com
(必要なら、上記を基に投資家向けのDDチェックリストや創業者向けのピッチテンプレートを作成します。ご希望があれば次に出力します。)
🖍 考察
2025年10月第2週のAI資金調達:Reflection AI、OpenAI、n8n、Ms.Engineer
調査の本質
本調査は、2025年10月5日〜10月12日の一週間におけるAIスタートアップの資金調達ニュース群から、資本の流れ・投資家の志向・事業側の勝ち筋を明確化し、依頼者(投資家/起業家/政策担当者)が実務的に活用できる洞察と行動指針を提示することを目的とします。
表面的には「誰がいくら調達したか」という速報情報が並びますが、本質は次の点にあります:資本は「フロンティア(巨大モデル/研究)」「インフラ(データセンター・GPU等)」「実務ソリューション(自動化・人材育成・評価)」へ二極化・集中化しつつあり、それぞれが相互に依存・摩擦を生んでいる。依頼者にとって価値を提供するには、この構造を踏まえたリスク管理、差別化戦略、パートナーシップ設計を示すことです(出典例:Reflection AI / TechCrunch、OpenAI Stargate / OpenAI、n8n / CRN、Ms.Engineer / BRIDGE)。
表面的には「誰がいくら調達したか」という速報情報が並びますが、本質は次の点にあります:資本は「フロンティア(巨大モデル/研究)」「インフラ(データセンター・GPU等)」「実務ソリューション(自動化・人材育成・評価)」へ二極化・集中化しつつあり、それぞれが相互に依存・摩擦を生んでいる。依頼者にとって価値を提供するには、この構造を踏まえたリスク管理、差別化戦略、パートナーシップ設計を示すことです(出典例:Reflection AI / TechCrunch、OpenAI Stargate / OpenAI、n8n / CRN、Ms.Engineer / BRIDGE)。
分析と発見事項
- 資本の集中と二層化
- 主要事実:Reflection AIが約20億ドルを調達(評価額約80億ドル)し、OpenAIは大規模インフラ計画「Stargate」を進行(長期の巨額投資計画)と報じられる一方、n8nやMs.Engineer等は実務課題解決に対する資金を着実に獲得している(出典:TechCrunch、Reuters、OpenAI、CRN、BRIDGE)。
- 意味:上位プレイヤーへ資本が集中する一方、中堅/ニッチは「運用価値」「業務埋め込み」で差別化して資金を得る二層化が進行。
- インフラ依存性と外部制約の顕在化
- 主要事実:Stargateのようなインフラ拡張は電力・水・GPU供給に大きく依存する(出典:OpenAI公式/解説記事)。
- 意味:インフラ投資は単なる資本投入ではなく、地域インフラ・規制・環境負荷と強く結びつくため、実行リスク(許認可、電力確保、コスト回収)が投資評価に直結する。
- 実務プロダクトへの安定的資金流入
- 主要事実:n8nのシリーズCやMs.EngineerのプレAは、企業導入や社会課題解決(リスキリング)という明確な需要に支えられている(出典:CRN、BRIDGE)。
- 意味:短中期での収益化が見込めるB2B自動化、人材育成、評価サービスは投資家にとって魅力的なターゲットになっている。
- 地政学的資本と資金の持続可能性
- 主要事実:グローバルでAIへ流れるVC比率が高まり、中東等のソブリン資本がインフラ投資を後押しする傾向がある(出典:集計記事)。
- 意味:資金源の構成変化は短期的な過熱をもたらす一方、長期回収の可否をより慎重に見る必要がある。
(視覚化:資金流入の二層化)
より深い分析と解釈
ここでは「なぜ」を3段階掘り下げ、想定外の要因や複数の解釈を示します。
問い1:なぜ資本は巨大ラウンドに集中するのか?
- 第1層(表面的原因):巨大モデルや主権的運用を目指すにはスケールの経済が必要で、投資家は勝者総取りの期待で大型資金を投じる(事実:Reflectionの$2B等)。
- 第2層(構造的要因):GPU供給やデータ、運用インフラが参入障壁を作り、先行する大手がそれらを確保することで差が拡大するため、資本が集中しやすい。
- 第3層(戦略的要因):国家・大型企業は「AIの主権性(sovereignty)」や安全保障的観点からも資本を投じるため、単なる金融リターンだけでない動機が存在する(OpenAIのStargate等)。
問い2:なぜ実務プロダクトに安定資金が入るのか?
- 第1層:企業のDX投資や効率化ニーズが即時的な収益化を可能にするため。
- 第2層:投資家は短期〜中期での回収を重視しており、明確な顧客基盤・ARRがある事業にプレミアムを付ける。n8nのARRや顧客数はその好例。
- 第3層:大企業のCVCや政策資金(地域開発/人材育成)と連動することで、実務プロダクトは「安定した需要の受け皿」を形成できる。
矛盾・想定外への弁証法的解釈
- 矛盾点:一方で、巨大インフラへの過度な投資は電力・環境・地域反発という外部コストを生み、長期ではその負担が投資回収を圧迫する可能性がある。
- 解釈A(楽観):インフラ投資が進めば、計算コスト低下・サービス普及が進み、ソフトウェア側のTAMが拡大する。
- 解釈B(懐疑):過剰設備・需給ミスマッチが生じれば、資本の一部はストランド(稼働率不充分)化し、VCの評価が急速に修正されるリスクがある。
シナリオ分析(短中期)
- ベースケース(推奨対応):フロンティアと実務プロダクトが並存。投資家は分散、創業者は差別化とパートナー戦略(ハード側と連携)を重視。
- ハイリスク(過熱)ケース:中東やソブリン資本の大量注入でインフラ過剰。規制・電力コストで調達期待が剥落。対策:柔軟な稼働契約・再生エネ連携を前提にする。
- デフレ/冷却ケース:資金が縮小し、資本効率の悪いプレーヤーが淘汰。生き残るのは明確な収益パスを示せる事業。
戦略的示唆
依頼者別に実行可能な短期〜中長期アクションを提示します。
A. スタートアップ(創業者)向け
- 差別化の3軸を明確化して投資家に提示する
- 技術差(モデル・評価手法)、データ差(独自データ・契約)、運用差(導入プロセス・SLA)。
- 資本効率を武器にする(即効性)
- モデル訓練・推論のコスト最適化(reflection tuning等の手法参考)とクラウド/ハード提携でTCOを下げる。
- GTMでの証拠準備を強化
- PoCのKPI(NRR、ARR成長、導入日数)を短期で示せるテンプレを用意し、CVCや企業投資家に具体的な導入計画を提示する(Ms.Engineerのような人材領域は、卒業生の就職データを示すと説得力が高い)。
B. 投資家(VC/CVC/LP)向け
- ポートフォリオ分散の推奨配分枠組み(例)
- フロンティア・モデル:30%、インフラ(ハード/データセンター/チップ):30%、応用レイヤー(自動化・評価・人材):40%(各社のリスク許容で調整)。
- DDチェックリスト(重点項目)
- インフラ投資:電力・水・許認可・オフテイク(買い手)契約の有無を精査(OpenAI/Stargate事例を参照)。
- 実務プロダクト:顧客リテンション、ARR、導入成功率、データ権利関係(Scale系の判例を参照)。
- Nvidia等チップサプライヤーの投資先マッピングを継続監視(供給チェーン・市場シグナルとして有効、出典記事参照)。
C. 政策担当者/自治体向け
- データセンター誘致の前提条件を明確化する(電力供給計画・再エネ比率・水利用計画)。
- 人材育成支援の制度化(補助金・税制優遇)で国内エコシステムの底上げを図る(Ms.Engineerの動向を踏まえた支援)。
- 規制・ガバナンス設計:主権的AI運用と輸出管理、環境影響評価の透明化を要求。
D. 具体的短期アクション(3つ、実行優先)
- 創業者:投資家向けに「導入→商用化までの標準パス(SLA・オンボーディング)を1枚で示す資料」を準備しておく(即週内)。
- 投資家:インフラ案件のDDで「電力供給とオフテイク契約」の確認を標準項目化する(次回のタームシート前に必須)。
- 政策:地域でのデータセンター誘致を検討する自治体は、再エネ供給計画と住民説明会のテンプレを用意する(1ヶ月以内に基準設定)。
今後の調査(優先度付き提案)
以下は、本分析を活かすために追加で掘り下げるべきテーマです。出典は当該週の調査結果に含まれる情報を基にしています。
高優先度(直近実行)
- Reflection AIの資金使途・キャピタル構成(出資者の詳細・用途の明確化)(出典:TechCrunch、Reuters)。
- OpenAI Stargateのサイト別スケジュールと地域インパクト(電力契約・稼働開始予定)(出典:OpenAI公式、関連解説記事)。
- n8nの顧客コホート分析(ARRの内訳、主要業種、LTV/NRR)(出典:CRN記事)。
中優先度(中期)
- Ms.Engineerの卒業生の就職実績と企業側の受け入れ状況(リスキリング効果の定量化)(出典:BRIDGE)。
- Sora/PixVerseのマネタイズ経路(広告・サブスク・SDK提供)と次ラウンドの資金動向(出典:BRIDGE記事)。
- Nvidiaの投資ポートフォリオマップと、それが示す業界の熱点(出典:TechCrunch、Reuters)。
低優先度(モニタリング)
- 中東系ソブリン資本の資金供給の持続可能性評価(電力・需要とのバランスに基づくシナリオ分析)(出典:集計記事、評論)。
- Databricks等ソフト大手の「エージェント基盤(Agent Bricks / Lakebase)」展開状況と連携先(出典:CRN記事)。
提案フォーマット(出力可能な追加成果)
- 投資家向け:Due Diligenceチェックリスト(インフラ特化版/ソフト特化版)。
- スタートアップ向け:資金調達時に示すべき「3つの差別化指標」テンプレート(例:データ独占度・導入時間・NRR)。
- 政策向け:Stargate誘致時チェックリスト(電力・雇用・環境・契約条項)。
ご希望があれば、上記のうちどれを優先して詳細化するか(例:「Reflection AIの資金使途分析」または「投資家向けDDチェックリスト」)を指示ください。出典として本報告で参照した記事群も参照可能です(例:Reflection TechCrunch、OpenAI Stargate公式、n8n CRN、Ms.Engineer BRIDGE等)。
このレポートが参考になりましたか?
あなたの仕事の調査業務をワンボタンでレポートにできます。
📖 レポートに利用された参考文献
検索結果: 39件追加のソース: 29件チャット: 7件
233件の参考文献から75件の情報を精査し、約375,000語の情報を整理しました。あなたは約32時間の調査時間を削減したことになります🎉
調査された文献
233件
精査された情報
75件
整理された情報量
約375,000語
削減された時間
約32時間
🏷 概要:2025年10月第2週の資金調達ハイライト
Report: AI investments see largest year-over-year growth in 20 ...
#### AI投資が過去20年で最大の年間成長を記録:Tortoise Intelligenceレポート概要
Tortoise Intelligenceの最新レポートによると、世界のAI企業への投資額は2020年以降115%増加し、2021年には775億ドルに達しました。これは、過去少なくとも20年間で最大の年間成長率を示しています。2020年の360億ドルという過去最高記録を大きく上回る結果となりました[1](https://www.tortoisemedia.com/intelligence/)[2](https://venturebeat.com/2021/10/16/the-2021-machine-learning-ai-and-data-landscape/)。
#### COVID-19がAI投資を加速
レポートの調査結果から、COVID-19パンデミックが政府と投資家の両方において、AIへの世界的な関心を高める要因となったことが明らかになっています。McKinsey Global Instituteのパートナーであるマイケル・チュイ氏によると、パンデミック中にデジタルコラボレーションスペースやリモートワークツールの需要が突如として高まったことで、ビジネスリーダーはデジタルトランスフォーメーションの必要性を痛感しました。この需要は、AIと自動化へのさらなる投資を促しました。
#### 主要国のAI投資動向と競争力
AI分野におけるグローバルリーダーは米国であり、世界をリードする商業シーン、豊富な人材、優れた研究イニシアティブが強みです[3](https://venturebeat.com/2021/09/11/ai-weekly-u-s-agencies-are-increasing-their-investments-in-ai/)[4](https://venturebeat.com/2021/10/11/ai-technology-could-reshape-the-u-s-government-but-should-it/)。次いで中国が第2位に位置し、堅牢なインフラと野心的な政府戦略でAI技術の展開を支援していますが、人材面では課題を抱えています。英国は優れた国内研究者プールと強力なAIスタートアップシーンにより第3位を維持していますが、高額なビザ制度など開発・運営環境には改善の余地があるとしています。

#### 一人当たり投資額で際立つイスラエル
一人当たりの資金調達額では、イスラエルが他の全ての国を上回り、韓国を5位から押し退けてトップに立ちました。イスラエルでは、人口100万人あたり32万5000ドルがAI関連企業に投資されています。また、GDPに占める研究開発費の割合でも世界第1位となっています。
#### 世界中で広がるAI政府戦略
政府もまたAIの時代精神に反応していることが見られます。Tortoise Intelligenceの前回レポート以降、スロベニア、トルコ、アイルランド、エジプト、マレーシア、ブラジル、ベトナム、チリの8カ国が新たに公式なAI政府戦略を発表しました。これは、この技術の人気が世界的に高まっていることの明確な証拠です。
#### Tortoise Global AI Indexとは
Tortoise Global AI Indexは、AIへの投資額、各国のAI人材の強さ、研究の質、スーパーコンピューティング能力、そして国家政府戦略の野心と実行力を含む指標を分析し、各国のAIに対する準備状況をランク付けしています。
このレポートの全容は、Tortoise Intelligenceのウェブサイトでご覧いただけます[5](https://www.tortoisemedia.com/2021/12/02/ai-boom-time/)。
AI Deals Dominate US Venture Capital in 2025
#### 2025年における米国ベンチャーキャピタルを席巻するAIディール
ベンチャーキャピタル業界は、今、まさに地殻変動のただ中にあります。人工知能は単なる有望な技術から、スタートアップ資金調達のルールを根本から書き換える絶対的な原動力へと進化を遂げました。この変革は、投資環境だけでなく、将来のイノベーションの方向性をも決定づけるものとして注目されています。
#### AIが米国ベンチャーディールの60%超を占める
2025年には、AIスタートアップがこれまでに1927億ドルもの資金を調達しました。これは、[The Kobeissi Letter](https://x.com/KobeissiLetter/status/1974992499929489703)が指摘するように、グローバルなベンチャーキャピタル全体の半分以上が単一の技術カテゴリーに流入した史上初の年となります。特に米国では、AIが全ベンチャーディールバリューの60%以上を占めており、そのシェアは2020年以来3倍に増加しています。
かつてベンチャー投資の主役だったモビリティテック、気候テック、暗号、フィンテックといったセクターは、AIに資金が殺到する中で脇に追いやられています。この顕著な変化は、ChatGPTが生成AIの可能性を世界に示した2022年後半に始まり、2025年を通じてその勢いを増しています。これは投資家たちが単なる流行の波に乗っているのではなく、AIが次なるイノベーション時代の基盤となるという長期的な確信に基づいていることを示唆しています。

#### 投資家がAIに集中する理由
投資家がこれほどまでにAIに資本を集中させるのには、いくつかの強力な要因があります。まず、生成AIの爆発的な普及が挙げられます。ChatGPT、Claude、Geminiといったツールが日常生活に浸透し、何百万ものユーザーに具体的な価値を実証しています。同時に、AIの進化には大規模なインフラが不可欠であり、GPU、専用チップ、そして大量のエネルギーを消費するデータセンターに対して数十億ドル規模の投資が行われています。さらに、ヘルスケアから金融、製造業に至るまで、あらゆる産業がコスト削減と競争力維持のためにAI機能の統合を急いでおり、これも投資を加速させる大きな要因となっています。
#### AI投資の規模と波及効果
2025年のグローバルベンチャーキャピタル資金調達総額は3668億ドルに達し、そのうち米国が2502億ドルを占めています。驚くべきことに、そのうち約1930億ドルがAI単独に流れ込んでおり、これは単なる市場リーダーシップを超え、完全な支配状態を示しています。[AI](https://thetradable.com/ai/openais-energy-ambition-surpasses-national-power-grids-ig--a)はベンチャー投資の引力中心となり、他のほぼ全てのセクターから資金と人材を引き寄せているのです。
米国ベンチャーキャピタルの60%以上がAIに流れることは、半導体、クラウドインフラ、そして大規模なデータセンターを動かすための再生可能エネルギープロジェクトなど、あらゆる関連分野に広範な波及効果をもたらします。今後も、より優れたチップ、より効率的な電力ソリューション、新しいコンピューティングアーキテクチャといった、AIエコシステム全体をサポートする分野への継続的な投資が見込まれています。
Nearly Half of Global Venture Capital Now Flows to AI ...
AI startups captured 46% of global venture capital in Q3 2025, totaling US$97 billion. · Anthropic, xAI, and Mistral AI led the quarter's biggest funding rounds.
Artificial Intelligence News for the Week of October 10; Updates ...
2025年10月第2週のAIニュース:CoreWeaveによるMonolith AI買収、IBMとSalesforceのAIエージェント強化、DataikuのAgent Hub発表
2025年10月10日の週に発表されたAI関連の最新ニュースをまとめました。この期間は、AIスタートアップの買収、エンタープライズAIソリューションの強化、AIインフラの進化、そしてAI人材の育成と倫理に関する議論が活発に進展した一週間でした。特に、資金調達の側面では、買収という形でAI技術への戦略的な投資が行われていることが見て取れます。
#### 主要な買収と市場統合
今週は、AIスタートアップの技術が大手企業に統合される重要な動きが2件発表されました。
* **CoreWeaveによるMonolith AI買収**: クラウドおよびスーパーコンピューティングのリーダーであるCoreWeaveは、Monolith AIの買収計画を発表しました。これにより、産業シミュレーションとAIを活用したエンジニアリング向けのソリューションを拡大し、エンタープライズワークロード向けのクラウドおよびスーパーコンピューティングにおける地位を強化することを目指します[https://finance.yahoo.com/news/coreweave-acquire-monolith-ai-expand-081909112.html](https://finance.yahoo.com/news/coreweave-acquire-monolith-ai-expand-081909112.html)。Monolith AIのような革新的なスタートアップが、より大規模なリソースを持つ企業に組み込まれることで、その技術の実用化が加速される事例と言えます。
* **RedisによるFeatureform買収**: Redisは、Featureformの買収を発表し、開発者がリアルタイムの構造化データをAIエージェントに直接提供できるようにしました。この買収は、高性能なインメモリストレージと高度なデータパイプラインを結合し、次世代AIおよび自動化を推進するものです。
#### エンタープライズ向けAIソリューションの進展
多くの企業が、エンタープライズにおけるAI導入を加速するための新製品やサービスを発表しました。
* **Dataiku Agent Hubの発表**: Dataikuは、エンタープライズAIエージェントの管理、オーケストレーション、スケーリングを可能にするプラットフォーム「Agent Hub」をリリースしました。ガバナンス、デプロイメントの自動化、シームレスなエージェントライフサイクル管理が特徴です[https://www.dataiku.com/press-releases/agent-hub/](https://www.dataiku.com/press-releases/agent-hub/)。
* **EXLdata.aiスイートの登場**: EXLは、エンタープライズAIの導入を加速し、データ統合を効率化し、大規模組織におけるアルゴリズム自動化を可能にする統合AIデータソリューションスイート「EXLdata.ai」を発表しました。
* **IBMのAgentic AIとインテリジェントインフラ**: TechXchange 2025にて、IBMは企業がAIの実験段階から真の生産性へと移行するための次世代ソフトウェアとインフラを発表しました。「watsonx Orchestrate with AgentOps」によるエージェントの可観測性とガバナンス、Langflowを通じたローコードエージェント構築、そして新しいメインフレームAIアシスタントなどが含まれます。
* **SalesforceのAIエージェントアップグレード**: DreamforceにてSalesforceは、「Agentforce Voice」による自然な顧客対話機能と、AIエージェント向けの新ハイブリッド推論スキルを発表する予定です。これにより、人間のようなエンゲージメントと柔軟なルール適用を実現し、サービス成果の向上を目指します[https://www.axios.com/2025/10/09/salesforce-dreamforce-agents-voice](https://www.axios.com/2025/10/09/salesforce-dreamforce-agents-voice)。
* **TeradataのAIエージェント研究**: Teradataは、AIエージェントを活用して顧客体験を向上させるための洞察とソリューションを発表しました。パーソナライゼーション、迅速なサポート、顧客満足度の向上に焦点を当てています[https://www.teradata.com/press-releases/2025/can-ai-agents-improve-customer-experience](https://www.teradata.com/press-releases/2025/can-ai-agents-improve-customer-experience)。
#### AIインフラと開発ツールの革新
AIモデルのトレーニングとデプロイメントを支えるインフラと開発ツールも大きく進化しています。
* **NVIDIA VeloxとcuDF**: NVIDIAとパートナー企業は、GPU上で高速な分析とデータサイエンスパイプラインを可能にするオープンソースプロジェクト「Velox」と「cuDF」を発表しました。これにより、データ駆動型企業はより高いスループット、低いレイテンシ、優れたTCO(総所有コスト)を実現できるとされています。
* **Hitachi VantaraとSupermicroの提携**: 両社は、ミッションクリティカルなワークロードとAIモデルを実行する企業向けの、スケーラブルで高性能なハードウェアを提供するための提携を発表しました。
* **MathWorks MATLAB Copilotのローンチ**: MathWorksは、AIを活用したコーディング支援、ワークフロー最適化、トラブルシューティングを提供する「MATLAB Copilot」を発表しました。科学者やエンジニアがコード作成、タスク自動化、発見加速に活用できるよう設計されています。
* **Grafana LabsのAIオブザーバビリティ機能拡張**: Grafana Labsは、異常検知、予測、根本原因分析を強化する高度なAI機能でオブザーバビリティプラットフォームを拡張しました。ユーザーは生成AIモデルを活用して、より実用的な洞察を得られます[https://devops.com/grafana-labs-extends-ai-capabilities-of-observability-platform/](https://devops.com/grafana-labs-extends-ai-capabilities-of-observability-platform/)。
#### AI活用と人材育成・倫理
AIの急速な普及に伴い、組織のAI導入状況や人材育成、倫理に関する課題も浮上しています。
* **SnapLogicの調査でAIトレーニング不足が判明**: SnapLogicのグローバル調査によると、従業員の多くがAIを活用した職場への準備不足を感じており、不十分なトレーニングが原因であることが明らかになりました。AIの導入と従業員のスキルアップの間にギャップがあることを示しています[https://www.snaplogic.com/company/newsroom/press-releases/global-research-employees-lack-ai-training](https://www.snaplogic.com/company/newsroom/press-releases/global-research-employees-lack-ai-training)。
* **Dynatraceのオブザーバビリティに関するレポート**: Dynatraceの最新レポート「State of Observability 2025」では、AIを活用したオブザーバビリティの導入が急増しており、組織がエンドツーエンドの自動化とプロアクティブなリスク軽減に投資していることが示されています[https://www.dynatrace.com/news/press-release/state-of-observability-2025/](https://www.dynatrace.com/news/press-release/state-of-observability-2025/)。
* **「Insight Jam」の専門家パネル議論**: AIと人間知能経済、AIにおけるHuman in the Loop、AIの倫理、AI時代におけるスキルアップなど、多岐にわたるテーマで議論が行われました。これらの議論は、AIの導入がもたらすビジネス上の課題だけでなく、社会的な影響や人材育成の重要性にも光を当てています。
#### 政策と研究投資
* **欧州委員会による「RAISE」戦略の開始**: 欧州委員会は、欧州における科学研究のためのAI開発を推進する「RAISE」戦略を開始しました。新しいインフラへの資金提供、国境を越えた協力、オープンソースツールの推進を通じて、EUの研究者が世界的な競争力を維持することを目指します。
今週のニュースは、AI技術が多様な産業分野で深く統合され、企業の競争優位性確立のための重要な投資対象となっていることを明確に示しています。特にスタートアップの買収は、既存企業が最先端のAI技術を迅速に取り込み、市場でのリーダーシップを強化しようとする動きの一環と解釈できます。
愛・蔵太の気ままなアンテナ
AIデータセンター急拡大が家庭の電気代を引き上げている「AIの成長は電力不足で頭打ち」 1 名前:Gecko ☆:2025/10/05(日) 10:34:56.26 ID:oTBCHW4I9.net. AIデータ ...
調査のまとめ
#### 2025年10月第2週のAIスタートアップ資金調達レポート:OpenAI、Reflection AI、n8nが牽引するAI投資の新局面
#### 回答
この一週間(2025年10月5日〜...
調査のまとめ
#### 2025年10月第2週のAI資金調達ニュース:Reflection AI、Databricks、そしてWayveの動向
ここ一週間のAIスタートアップの資金調達に関するニュースでは、特に「...
調査のまとめ
#### 2025年10月第2週目のAIスタートアップ資金調達ニュース:Scale AIの10億ドル調達と評価額倍増
#### 回答
#### データラベリング大手Scale AIが10億ドルを調...
調査のまとめ
#### 2025年10月第2週 AIスタートアップ資金調達トレンド:『週刊東洋経済』のベンチャー分析とOpenAIの巨額インフラ投資
2025年10月第2週(10月5日以降)に特化した日本のAIス...
調査のまとめ
#### 2025年10月第2週目のAIスタートアップ動向:Ms.Engineerが女性AI・IT人材育成で3.2億円調達、グローバルではSoraとPixVerseの動画生成AI競争が激化
####...
調査のまとめ
#### 2025年10月第1週のAIニュース:Ms.Engineerの資金調達とpostalk、Sora、PixVerseの注目動向
ここ一週間(2025年10月5日から10月12日)における日本...
🏷 大型ラウンド事例の整理:Reflection AI、OpenAI、Scale AIの中身
Nvidia-backed Reflection AI raises $2 billion in funding, ...
Reflection AI, a startup backed by Nvidia, said on Thursday it has raised $2 billion in a new funding round that values the company at $8 billion, ...
The Week's 10 Biggest Funding Rounds: Polymarket And ...
1. (tied) Reflection AI, $2B, AI: New York's Reflection AI, a developer of LLM training models based on open standards, raised $2 billion in a funding round ...
AI Startup Founded by Two Google Researchers ...
After transforming into the "American DeepSeek," an AI startup founded by two Google researchers has raised $2 billion in funding, with its valuation ...
OpenAI to raise $40 billion in SoftBank-led round to boost AI ...
#### OpenAIがソフトバンク主導で400億ドルを調達、AI推進へ
OpenAIは2025年3月31日、ロイター通信が報じたところによると、ソフトバンクグループ[9984.T](https://www.reuters.com/markets/companies/9984.T)が主導する新たな資金調達ラウンドで、最大400億ドルの資金を調達する意向を明らかにしました。この大規模な資金調達により、OpenAIの企業評価額は3000億ドルに達する見込みです。
#### 資金調達の目的とソフトバンクの投資詳細
この調達される資金は、AI研究のさらなる推進、計算インフラの拡充、そして既存ツールの強化に充てられます。ソフトバンクは、2025年4月中旬に100億ドル、同年12月には追加で300億ドルを拠出することで合意に至りました。ただし、この追加投資はOpenAIが年末までに営利企業に移行することを条件としています。もしOpenAIの組織再編が計画通りに進まず、営利企業への移行が失敗に終わった場合、ソフトバンクの総投資額は200億ドルに減少する可能性があります。ソフトバンクはまた、その投資総額のうち100億ドルを他の共同投資家にシンジケートする計画です。
#### 主要投資家とパートナーシップ
関係筋によると、残りの資金はマイクロソフト[MSFT.O](https://www.reuters.com/markets/companies/MSFT.O)、Coatue Management、Altimeter Capital、Thrive Capitalなどの投資家から供給されると見られています。さらに、OpenAIはソフトバンクおよびOracle[ORCL.N](https://www.reuters.com/markets/companies/ORCL.N)と提携し、総額5000億ドル規模の「Stargateプロジェクト」の一環として、米国におけるAIワークロードを支えるデータセンターネットワークの構築を進めています。ソフトバンクグループの孫正義会長兼CEOは、「AIは人類の未来を形作る決定的な力です。OpenAIとの提携拡大は、その可能性を最大限に引き出すという共通のビジョンを加速させます」とコメントしています。
#### OpenAIの現状と戦略的展望
OpenAIは、毎週5億人もの人々が利用するChatGPT向けに、ますます強力なツールを提供することを目指しています。同社は過去に、2024年10月に1570億ドルの評価額で66億ドルの資金調達を完了しており[https://www.reuters.com/technology/artificial-intelligence/openai-closes-66-billion-funding-haul-valuation-157-billion-with-investment-2024-10-02/](https://www.reuters.com/technology/artificial-intelligence/openai-closes-66-billion-funding-haul-valuation-157-billion-with-investment-2024-10-02/)、今回の新たな資金調達ラウンドが成功すれば、その評価額はほぼ倍増することになります。
なお、OpenAIの共同創設者兼CEOであるサム・アルトマン氏は、2025年2月7日、ドイツ・ベルリンのベルリン工科大学で人工知能に関するパネルディスカッションに参加しています。REUTERS/Axel Schmidt/File Photo [Purchase Licensing Rights](https://www.reutersconnect.com/item/openais-sam-altman-discusses-ai-at-a-university-in-berlin/dGFnOnJldXRlcnMuY29tLDIwMjU6bmV3c21sX1JDMk9QQ0E3WUo3Uw%3D%3D/?utm_medium=rcom-article-media&utm_campaign=rcom-rcp-lead)
同社はまた、株主利益と公共の利益のバランスを取りながら、より多くの投資とリソースを呼び込むため、公益法人を設立する新たな営利構造への移行計画[https://www.reuters.com/technology/artificial-intelligence/openai-lays-out-plan-shift-new-for-profit-structure-2024-12-27/](https://www.reuters.com/technology/artificial-intelligence/openai-lays-out-plan- ねshift-new-for-profit-structure-2024-12-27/)も打ち出しています。今回の資金調達により、OpenAIはSpaceX、中国のByteDance、Stripeといった最も価値のある非公開企業の一員となる見込みです。
#### 市場の動向とアナリストの視点
近年、チャットボットの広範な普及や洗練されたAIエージェントの出現が牽引し、人工知能セクターへの投資家の熱意は顕著に高まっています。多くの企業が業務効率化や顧客体験向上にAIソリューションを積極的に統合しており、ベンチャーキャピタル各社も有望なAIスタートアップへの投資を競っています。D.A. Davidson & Coのアナリストであるギル・ルリア氏は、「OpenAIは多くの面で非常に野心的な計画を持っており、これらの目標達成には多大な資本が必要です」と述べています。その一方で、ルリア氏は「この規模を支援したいと望む投資家のリストは縮小しており、ソフトバンクに限定される可能性があり、ソフトバンク自体も必要な資本を持っていないかもしれない」との見解を示しています。ソフトバンクは、最初の100億ドルをみずほ銀行などの金融機関からの借り入れで賄う予定です。なお、今回の取引において、米国法律事務所Morrison Foersterがソフトバンクに助言を提供しました。
Introducing GPT-5
We are introducing GPT‑5, our best AI system yet. GPT‑5 is a significant leap in intelligence over all our previous models, featuring state-of-the-art ...
GPT-5 is About to Be Released! Summary of Related ...
It has been reported that the training cost for GPT-5 (which may be codenamed Orion or Arrakis) exceeds $500 million, and it requires large-scale data centers, ...
OpenAI's Stargate Project: A Guide to the AI Infrastructure
Learn about OpenAI's Stargate project, a $500B AI infrastructure initiative. This guide covers its datacenter locations, partners, technology, ...
Announcing The Stargate Project
The Stargate Project is a new company which intends to invest $500 billion over the next four years building new AI infrastructure for OpenAI in the United ...
http://bloomberg.com/news/articles/2025-10-07/musk-s-xai-nears-20-billion-capital-raise-tied-to-nvidia-chips
https://www.nytimes.com/2025/10/09/business/dealbook/reflection-ai-2-billion-funding.html
Reflection AI raises $2B to be America's open frontier AI lab, challenging DeepSeek | TechCrunch
[Reflection AI](https://reflection.ai/), a startup founded just last year by two former Google DeepM...
🏷 インフラとハード投資の潮流:Databricks、Stargate、Nvidiaの役割
2025年10月8日 更新順
... 資金を全額出したことが気に入らない様子のトメ「ちょっと稼いでるからって好き ... 調達中止」も?…高騰コストと低稼働率の現実! この記事をつぶやく; 10/08 11 ...
ドラマアプリ「BUMP」とはどんなサービス? ”口コミ”や”評判”、”
2026年には日本市場が1,530億円規模に達するとの予測があり、テレビ局などの大手企業の参入やスタートアップによる資金調達が相次いでいるとのことです。この市場拡大 ...
中東マネーが煽るAIバブルは、砂漠の夢か、蜃気楼か?|武智倫太郎
#### 中東マネーが煽るAIバブルは、砂漠の夢か、蜃気楼か?|武智倫太郎
本記事「中東マネーが煽るAIバブルは、砂漠の夢か、蜃気楼か?」(著者:武智倫太郎)は、サウジアラビア、UAE、カタールといった中東産油国が巨額のオイルマネーをAI分野に投じる現状と、それが引き起こす「AIバブル」の光と影を深く掘り下げています。石油依存経済からの脱却と技術覇権を掲げる湾岸諸国と、天文学的な資金需要を抱えるテック企業(NVIDIA、OpenAIなど)の思惑が交錯し、2025年に前代未聞の巨額ディールが次々と生まれている様子が描かれています。
)
#### 灼熱の砂漠で燃え盛るテック狂騒曲
中東諸国は、サウジの「ビジョン2030」やUAEのAI国家戦略に基づき、経済の多角化と技術立国を目指しています。これに対し、生成AI開発に必要な膨大な計算資源と投資を求めるNVIDIAやOpenAIのような企業が、中東の潤沢な財源に注目し、両者の思惑が一致した結果、AIバブルが過熱しています。しかし、その輝かしいディールの裏には、地政学リスク、倫理的ジレンマ、そしてバブル崩壊の歴史的教訓が潜んでいると警鐘を鳴らしています。
#### トランプの「テック・ディール外交」と中東の野心
2025年5月、ドナルド・トランプ大統領の中東歴訪は、グローバル経済に大きな影響を与えました。わずか数日で総額1兆ドルを超える経済協定が締結され、特にUAEとの間では「米国外最大のAIキャンパス」建設協定が注目を集めました。アブダビに建設されるこの施設は、10平方マイル(約26平方キロメートル)、消費電力5ギガワットという大規模なもので、NVIDIAの最新GPUを年間50万基輸入する許可を得ています。このプロジェクトは、UAEが2031年までにAI分野で世界のリーダーとなるという国家目標の象徴であり、「第三のAI勢力圏」の誕生を予感させます。NVIDIAのジェンスン・フアンCEOやOpenAIのサム・アルトマンCEOらがこの歴訪に同行したことは、湾岸諸国がテック業界のスター選手を積極的に招き入れていることを示しています。
#### 孫正義とサウジ:AI投資の再起と課題
ソフトバンクグループの孫正義氏は、中東マネーとAI投資の交差点で再び注目されています。2016年のソフトバンク・ビジョンファンド(SVF)設立時からのサウジとの関係に加え、2023年末に「AIこそ人類史上最大の革命」と宣言し、AI分野への投資を再加速させています。特にOpenAIへの投資は大胆で、2024年秋から2025年春にかけて累計22億ドルを投じ、さらに最大400億ドルの条件付き追加投資契約を締結しました。孫氏はOpenAIを「人工超知能(ASI)実現の最有力パートナー」と位置づけていますが、過去のSVFの投資失敗の経験から、その成功には慎重な戦略が求められると指摘されています。
#### AIバブルの光と影:過熱の先に潜むリスク
現在のAIバブルは、2000年のITバブルを彷彿とさせる過熱状態にあり、需要過大予測、地政学的リスク、倫理的ジレンマといった深刻なリスクが潜んでいます。
* **需要過大予測の危険**: 中国でのAIデータセンターの過剰建設や、UAEの5GW級AIキャンパスが「砂漠のピラミッド」と化すリスクが指摘されています。特に、5ギガワットという途方もない電力消費量を安定的に供給できるか、既存のインフラで支えられるかという現実的な電力供給の問題は看過できない論点として強調されています。
* **地政学的リスク**: UAEやサウジが米中双方と取引を続ける「綱渡り外交」を展開しているため、米政権交代によるAIチップ輸出規制の復活や、中国による独自AI技術の提供拡大といったリスクがあります。
* **倫理的リスク**: 中東の強権国家がAIを監視や人権抑圧に悪用する懸念が強く、技術の恩恵が「デジタル独裁」の道具に転用される危険性も指摘されています。
#### 米国とUAE、AI分野で戦略的パートナーシップを締結
2025年5月15日、米国とUAEは「米UAE AI加速パートナーシップ(US-UAE AI Acceleration Partnership)」の枠組みを発表しました。この合意により、UAEは2025年から年間50万個のNvidia製最先端AIチップの輸入が可能となり、アブダビに5ギガワット(GW)規模のAIデータセンターキャンパスを建設する計画です。このキャンパスでは、太陽光、ガス、原子力発電といった多様なエネルギー源が活用される予定です。このパートナーシップは、UAEがAI分野を国家戦略と位置づけ、経済の多角化と技術立国を目指す強力な意思を示すものであり、米国にとっては最先端AI技術の普及と、中国など他の技術大国との競争において中東を重要なパートナーとして取り込む狙いがあります。
#### 「週刊バブルウォッチ」最新号が警鐘を鳴らす
本記事は、孫正義氏とソフトバンクグループを軸に展開される「AI神話」の構造とその危うさを徹底検証する「週刊バブルウォッチ」最新号の内容にも触れています。OpenAIの非営利体制への回帰、Microsoftとの政治的駆け引き、そして孫氏の焦燥と空転を通じて、「AI神話」が単なる幻想に過ぎない可能性を提示しています。投資家に対し、「現実を直視せずに投じられたマネーはどこへ消えたのか?」、「次に梯子を外されるのは誰なのか?」、「その投資は本当に現実を見ているか?」と問いかけ、ポスト幻想時代の読書体験を提供し、社会の進路に一石を投じる内容となっています。
---
参考資料:
* [Trump announces $200 billion in deals during UAE visit, AI agreement signed](https://www.reuters.com/world/middle-east/trump-heads-uae-it-hopes-advance-ai-ambitions-2025-05-15/?utm_source=chatgpt.com)
* [AI Arrives In The Middle East: US Strikes A Deal with UAE and KSA 5 GW Datacenter, HUMAIN, G42, Diversion and Misuse Risks, Security Requirements, American AI Wins](https://semianalysis.com/2025/05/16/ai-arrives-in-the-middle-east-us-strikes-a-deal-with-uae-and-ksa/?utm_source=chatgpt.com)
* [Trump agrees deal for UAE to build largest AI campus outside US](https://www.theguardian.com/us-news/2025/may/15/trump-artificial-intelligence-uae?utm_source=chatgpt.com)
* [UAE to build biggest AI campus outside US in Trump deal, bypassing past China worries](https://www.reuters.com/world/china/uae-set-deepen-ai-links-with-united-states-after-past-curbs-over-china-2025-05-15/?utm_source=chatgpt.com)
* [UAE deepens AI links with US after past curbs over China](https://www.ksl.com/article/51313686/uae-deepens-ai-links-with-us-after-past-curbs-over-china?utm_source=chatgpt.com)
* [UAE/US Framework on Advanced Technology Cooperation](https://www.commerce.gov/news/press-releases/2025/05/uae/us-framework-advanced-technology-cooperation?utm_source=chatgpt.com)
* [UAE and US Presidents attend the unveiling of Phase 1 of new 5GW AI campus in Abu Dhabi](https://www.commerce.gov/news/press-releases/2025/05/uae-and-us-presidents-attend-unveiling-phase-1-new-5gw-ai-campus-abu?utm_source=chatgpt.com)
* [US close to letting UAE import millions of Nvidia's AI chips, sources say](https://www.reuters.com/business/finance/us-close-letting-uae-import-millions-nvidias-ai-chips-sources-say-2025-05-14/?utm_source=chatgpt.com)
Elon Musk’s artificial intelligence startup xAI is raising more financing than initially planned, tapping backers including Nvidia to lift its ongoing funding round to $20 billion, according to people ...
Failed to extract contents from https://www.instagram.com/reel/DPjXt_9EbbV/. Scraping and AI access may not be possible, and insufficient information was obtained for summarization, so browser operation is required for viewing.
The billion-dollar infrastructure deals powering the AI boom
Nscale: After the startup's $1.1 billion round in September, Nvidia participated in Nscale's $433 million SAFE funding in October. That's a deal that ...
Fears over AI bubble bursting grow in Silicon Valley
OpenAI's Stargate project in Abilene, Texas, funded with the help of Oracle and Japanese conglomerate SoftBank and announced at the White House during President ...
Nvidia's AI empire: A look at its top startup investments
Nscale: After the startup's $1.1 billion round in September, Nvidia participated in Nscale's $433 million SAFE funding in October. That's a deal that secures ...
週刊東洋経済 2025年10/11・10/18合併号
真の競争力が問われる新時代に突入 好機をつかむベンチャーはどこだ? 100社創出は曲がり角 悩める「国産ユニコーン」 ベンチャー評価額&調達額 最新ランキング [スペシャル ...
Databricks Closes $1B Series K Funding Round, Exceeds $100B Market Cap
[AI](https://www.crn.com/news/ai)
# Databricks Closes $1B Series K Funding Round, Exceeds $100B Mar...
Wayve raises $1B to take its Tesla-like technology for self-driving to many carmakers | TechCrunch
[Wayve](https://wayve.ai/), a U.K.-born startup developing a self-learning rather than rule-based sy...
Nvidia eyes $500M investment into self-driving tech startup Wayve | TechCrunch
Nvidia CEO Jensen Huang descended on the United Kingdom this week, armed with a pledge to invest £2 ...
調査のまとめ
現在の調査結果には、ユーザーの皆様が求められている「ここ一週間のAIスタートアップの資金調達に関するニュースをトピックごとにまとめ、分析する」ための具体的な情報が見当たりませんでした。そのため、主要な...
🏷 専門領域での勝ち筋:n8n、Trismik、Wayveに見る差別化戦略
Why AI startup Multiverse Computing thinks smaller AI is ...
Because Multiverse works with open-source models, it doesn't need the LLM creators' cooperation to do the shrinking. The company has so far raised $290 million ...
Trismik Secures £2.2M Pre-Seed Funding for LLM Evaluation
Trismik Raises £2.2M Pre-Seed Round Trismik, a Cambridge, UK-based science-grade LLM evaluation startup, has raised £2.2 million in a pre-seed funding round ...
Nvidia-Backed AI Startup n8n Raises $180M, Hits $2.5B ...
Nvidia funds agentic AI startup n8n via $180 million funding round at $2.5 billion valuation for the AI agent and business automation company.
TechNode - BRIDGE(ブリッジ)
TechNode - BRIDGE(ブリッジ)
Menu
マイページ/メルマガ
Search
Menu
Topics
Tokyo Fusion
Tech Daily
Ecosystem
取材会
IVS...
kigoyama - BRIDGE(ブリッジ)
kigoyama - BRIDGE(ブリッジ)
Menu
マイページ/メルマガ
Search
Menu
Topics
Tokyo Fusion
Tech Daily
Ecosystem
取材会
IVS...
AI-ESG支援で「台風の目」になるシェルパ——10億円調達
AI-ESG支援で「台風の目」になるシェルパ——10億円調達に成功、東京メトロなど大手が続々採用 - BRIDGE(ブリッジ)
Menu
マイページ/メルマガ
Search
Menu
Topics
T...
5日で100万DLしたSoraと1億ユーザー突破のPixVe
5日で100万DLしたSoraと1億ユーザー突破のPixVerse、どうなるミーム動画戦争 - BRIDGE(ブリッジ)
Menu
マイページ/メルマガ
Search
Menu
Topics
Toky...
AI 資金調達 - BRIDGE(ブリッジ)
AI 資金調達 - BRIDGE(ブリッジ)
Menu
マイページ/メルマガ
Search
Menu
Topics
Tokyo Fusion
Tech Daily
Ecosystem
取材会
IVS
...
医療・介護向けAIを手がけるシスタ、NOW や East V
医療・介護向けAIを手がけるシスタ、NOW や East Ventures などから資金調達 - BRIDGE(ブリッジ)
Menu
マイページ/メルマガ
Search
Menu
Topics
Tok...
https://thebridge.jp/ にアクセスします。,サイト内の「ニュース」または「資金調達」といったカテゴリページを探して移動します。,検索窓またはフィルタリング機能を利用して、「AI 資金調達」または「人工知能 資金調達」というキーワードで、公開日を「過去7日間」に指定して検索を実行します。,検索結果に表示された記事を一つずつ確認し、AIスタートアップ名、調達額、投資家、資金使途、そして発表日を詳細にメモします。,もし直接的な資金調達ニュースが見つからない場合でも、ここ一週間で言及された日本のAIスタートアップに関する他の重要な動向や注目記事がないかを確認し、関連情報を収集します。
<step>1</step>
<url>about:blank</url>
<title>Starting agent bfeb...</title>
<thoughts><thinking>Thi...
🏷 国内エコシステムの動き:Ms.Engineer、三井不動産CVC、Sora/PixVerseの示唆
「日経賞」に秘密計算のアカンパニー 生成AIサミットが閉幕
秘密計算のアカンパニー、11億円調達 研究者増員に充当. 5月19日. アカンパニーが提供する機密データ利用サービスのイメージ · 5月12〜23日 スタートアップ資金調達まとめ ...
NEWSCASTニュース一覧
**2025年10月上旬 NEWSCAST主要ニュース:AI技術活用、地域イベント、新商品・サービス発表とビジネス動向**
ユーザー様のご要望でございましたAIスタートアップの資金調達に関する具体的なニュースは、このニュース一覧からは確認できませんでした。しかし、AI技術の活用事例や多様な業界の動き、地域振興イベント、新商品・サービス発表など、2025年10月上旬における多岐にわたる興味深い情報が報告されています。以下に主要なニュースをトピックごとにまとめ、要約いたします。
#### AI技術とDX推進の進展
AI議事録サービス「JAPAN AI SPEECH」にリアルタイム翻訳機能が実装され、企業のグローバル化に伴う言語の壁を解消し、円滑な会議進行に貢献することが期待されています。これは、AIがビジネスコミュニケーションの効率化に深く関与する一例として注目されます。また、カナデビア株式会社の「Kanadevia Virtual Museum」が11月1日より一般公開される予定で、巨大インフラをメタバース空間で実物大に再現することで、新しい環境学習の機会を提供します。これは、VR/メタバース技術が教育分野へ応用される先進的な試みと言えるでしょう[1231715](https://newscast.jp/news/1231715), [7795690](https://newscast.jp/news/7795690)。
株式会社オキサイドは、経営資源の戦略的な投資判断を支える経営管理プラットフォーム「DIGGLE」を導入し、迅速な集計と精緻なシミュレーションを実現する予実管理体制の確立を目指しています。この導入は、DX推進による業務効率化と意思決定の迅速化に寄与するものです[8986793](https://newscast.jp/news/8986793)。
#### 地域活性化とライフスタイル関連イベント
大阪西淀川区では、感涙療法士の吉田英史氏による涙活ワークショップが開催され、医学的根拠に基づいたストレス解消効果や免疫力向上が期待されています。現代社会のストレス状況に対する新しいアプローチとして関心を集めています[2238683](https://newscast.jp/news/2238683)。
また、沖縄ではダウン症重度画家「沖縄のピカソ」小波津有希さんの半生をマンガ化するクラウドファンディングプロジェクトが始動し、同様の境遇にある家族に希望を届けることを目指しています[2122980](https://newscast.jp/news/2122980)。
秋元真夏さんが鹿児島県でマロンゴールドを収穫体験するYouTube番組「ゆるふわたいむ」の動画が公開され、特産品の魅力を楽しく発信しています。JAタウンでは、この収穫体験と連動したプレゼントキャンペーンも実施中です[6044115](https://newscast.jp/news/6044115)。
その他にも、京阪電車では3000系プレミアムカー2両化を記念したキャンペーンや、レール交換作業に伴う最終列車の繰り上げが発表され、地域交通の利便性と維持に向けた取り組みが進行しています[5455271](https://newscast.jp/news/5455271), [5910640](https://newscast.jp/news/5910640)。
さらに、千葉県初のGiGOクレーンゲーム専門店「GiGOクレーンゲームオアシス ワンズモール」がオープンし、地域連携として「千葉市動物公園」とのタイアップも実施されるなど、エンターテイメントと地域貢献を両立する動きが見られます[7912510](https://newscast.jp/news/7912510)。
#### 新商品・サービスの発表とキャンペーン
株式会社SYSTEM SERVERは、中小企業向けのITフルサポートサービス「うちのIT部長」の新規契約キャンペーンを開始し、ワイヤレスマウスなどの特典を提供しています。これは、IT担当者の確保が難しい中小企業の業務効率化を支援するものです[2230642](https://newscast.jp/news/2230642)。
パソコン工房では、グッドウィル36周年記念セールや静岡店の新規オープン記念セールを開催し、Windows 11への乗り換え応援フェアやアップグレード還元フェアも同時に実施しています。最新PCやPCパーツを対象としたお得なキャンペーンで、PCの買い替えやアップグレードを検討する消費者にとって魅力的な機会を提供しています[1054885](https://newscast.jp/news/1054885), [3341819](https://newscast.jp/news/3341819)。
ロッテの人気商品「パイの実」をモチーフにしたデザイン雑貨がGiGOのクレーンゲーム景品として登場し、コラボキャンペーンも展開されます。また、電熱ウェア「Voltera Glove」と「Voltera Neck Warmer」が予約開始され、冬のアウトドアやバイクでの移動を快適にする新製品として注目を集めています[4387966](https://newscast.jp/news/4387966), [8548243](https://newscast.jp/news/8548243)。
#### エンターテイメントと文化イベント
学園生活コミュニティ「キャラフレ」では、スポーツの秋をテーマにした『体育祭』イベントが開催され、バーチャル空間でのミニゲームやチーム対抗戦を通じて、ユーザーは仮想学園生活を楽しめます[7300673](https://newscast.jp/news/7300673)。
映画公開40周年記念『バック・トゥ・ザ・フューチャー』inコンサート2025の東京公演が10月24日より開幕し、公演オリジナルグッズの販売やお得なペア割チケットが提供されています。映画音楽の生演奏を体験できるユニークなコンサートとして注目されます[1345739](https://newscast.jp/news/1345739)。
さらに、全国各地で舞台「大誘拐~四人で大スペクタクル~」や「さよなら挽歌」が上演され、豪華キャストによる演技が観客を魅了しています[3554097](https://newscast.jp/news/3554097), [7589322](https://newscast.jp/news/7589322)。
#### 調査と情報公開
株式会社Ryuki Designが実施した「Webページで印象に残る要素」に関する女性100名への意識調査では、「写真やビジュアルの印象」と「わかりやすく構成されたページ」が特に重視される結果となりました。年代別での傾向の違いも明らかになり、効果的なLPデザインの方向性が示唆されています[5343996](https://newscast.jp/news/5343996)。
ふるさと納税返礼品の還元率比較サイト「とくさと」は、2025年10月版の『パソコン』と『ベビーカー』の還元率ランキングを発表しました。愛知県幸田町の「HP ProDesk 400/800 G4 DM 小型デスクトップパソコン」や愛知県犬山市の「カトージTOBERU」が上位にランクインしており、消費者の賢い選択を支援しています[6276570](https://newscast.jp/news/6276570), [6169227](https://newscast.jp/news/6169227)。
探偵事務所の「興信所探偵ナビ」は、「浮気調査に関する意識と実態調査」の結果を公開し、依頼者が重視する「密会現場の写真・動画」が裁判では弱い証拠となる場合があることを指摘しています。費用や期間に関する依頼者と探偵の認識ギャップも明らかになりました[5658095](https://newscast.jp/news/5658095)。
この一週間で、AI技術のビジネス応用やメタバースの教育分野への活用、地域振興のための多様なイベント、そして消費者のニーズに応える新商品やサービスの発表など、幅広い分野で活発な動きが見られました。
NEWSCASTニュース一覧
「涙活」からAI翻訳機能、PC工房セール、ダウン症画家の物語まで - NEWSCASTニュース一覧
#### AIスタートアップ資金調達ニュースについて
提供されたニュース一覧には、AIスタートアップの資金調達に関する具体的な情報は含まれておりませんでした。
#### 健康・ウェルネス関連イベント
感涙療法士の吉田英史氏が、2025年10月12日に大阪市西淀川区民会館で「涙活(るいかつ)」ワークショップを開催します。このワークショップでは、涙を流すことによるストレス解消効果や免疫力向上といった効能が医学的エビデンスに基づいて解説され、参加者は泣ける映像の視聴や「なみだ作文」などの体験を通じて、自身の「泣きのツボ」を見つけ、泣きやすい体質づくりを目指します。ストレス社会で増加するメンタルヘルス不調者への対応策として、「情動の涙」が副交感神経を優位にし、ストレスホルモンであるコルチゾールの減少や心理的改善に繋がることが示されています。
[https://newscast.jp/attachments/weNmGMpaGzIbfpB8XJzE.jpg](https://newscast.jp/attachments/weNmGMpaGzIbfpB8XJzE.jpg)
[https://newscast.jp/attachments/WBPJLGc9ONTQGjHumwzo.png](https://newscast.jp/attachments/WBPJLGc9ONTQGjHumwzo.png)
[https://newscast.jp/attachments/X9vR4fVbOPsIB5bRcL6d.png](https://newscast.jp/attachments/X9vR4fVbOPsIB5bRcL6d.png)
[https://newscast.jp/attachments/Ptr5ZYYGKWyxFdOODPr4.png](https://newscast.jp/attachments/Ptr5ZYYGKWyxFdOODPr4.png)
[https://newscast.jp/attachments/ivh0KWDIXUtAI1pD1HuV.png](https://newscast.jp/attachments/ivh0KWDIXUtAI1pD1HuV.png)
近畿大学アンチエイジングセンターは、2025年10月18日に東大阪キャンパスで市民公開講座を開催し、「食と栄養で彩る健やかな毎日」をテーマに、加齢に伴う「食べる力」の低下を防ぐ方法や、栄養バランスのとれた食事で健康的に老化を遅らせる方法を紹介します。参加者には、農学部食品栄養学科の学生が考案し、文芸学部芸術学科の学生がパッケージデザインを手がけた「近大アンチエイジング弁当」が無料配布されます。
#### テクノロジー・ITサービス関連ニュース
株式会社オキサイドは、経営資源の戦略的投資判断を支援する経営管理プラットフォーム「DIGGLE」を導入しました。これにより、「部門×科目×施策単位」でのデータ一元管理やKPIデータのシステム上での管理、変数によるシミュレーションが可能となり、月次対応の省力化、分析プロセスの発展、事業部を巻き込んだ予実管理体制の構築が期待されています。
[https://newscast.jp/attachments/JCTJTz9iiCpmeymMVfrj.png](https://newscast.jp/attachments/JCTJTz9iiCpmeymMVfrj.png)
株式会社SYSTEM SERVERは、中小企業向けのITサポートサービス「うちのIT部長」を提供しており、2025年9月1日から10月31日まで、新規契約者を対象にワイヤレスマウス、ウェブカメラ、またはハブをプレゼントするキャンペーンを実施しています。このサービスは、IT担当者を確保できない中小企業の課題に対応し、機器選定からトラブル対応、システム開発までを一貫してサポートします。
[https://newscast.jp/attachments/nunu1R9LTYQd6LGhO495.png](https://newscast.jp/attachments/nunu1R9LTYQd6LGhO495.png)
JAPAN AI株式会社は、AI議事録サービス「JAPAN AI SPEECH」にリアルタイム翻訳機能を実装しました。これにより、オフライン会議での言語の壁を解消し、円滑な会議進行とコミュニケーション向上に貢献します。今後はWeb会議システムとの連携も予定しており、多様な働き方に対応したコミュニケーション支援を目指します。
[https://newscast.jp/attachments/n4kXjhgUKrPJsziQuBgc.png](https://newscast.jp/attachments/n4kXjhgUKrPJsziQuBgc.png)
パソコン工房・グッドウィルを運営する株式会社ユニットコムは、グッドウィル36周年記念セールとWindows 11全力乗換応援フェアを10月11日から開催しています。セールではゲーミングPCやPCパーツが特別価格で提供され、Windows 10サポート終了に伴うWindows 11への乗り換えが、下取りサービスや無料アップグレード診断などの特典付きでお得に行えます。また、パソコン工房静岡店も新規オープン記念セールを実施中です。
[https://newscast.jp/attachments/zwHMeK69kqFfPrggMnSF.jpg](https://newscast.jp/attachments/zwHMeK69kqFfPrggMnSF.jpg)
[https://newscast.jp/attachments/A8jLBzWFOCqPalbgHrPt.jpg](https://newscast.jp/attachments/A8jLBzWFOCqPalbgHrPt.jpg)
[https://newscast.jp/attachments/japQF7XDb9rTEAsq3Qbg.jpg](https://newscast.jp/attachments/japQF7XDb9rTEAsq3Qbg.jpg)
株式会社マクニカは、S&J株式会社へセキュリティ運用の自動化プラットフォーム「Swimlane」を提供しました。これによりS&Jでは、セキュリティ運用の可視化と一元管理を実現し、属人化解消、業務効率およびPlaybook開発スピード、運用品質の向上を達成しました。今後は生成AIの利活用も視野に入れています。
株式会社Ryuki Designは、「Webページで印象に残る要素」に関するアンケート調査結果を発表しました。女性100名を対象とした調査では、「写真やビジュアルの印象」(35%)と「サービス・商品の特徴がわかりやすくまとめられた構成」(34%)が特に印象に残る要素として挙げられました。年代別では、20代・50代で“構成重視”、40代で“ビジュアル重視”の傾向が見られ、ターゲットに合わせたLPデザインの重要性が示されています。
[https://newscast.jp/attachments/s5UESM1d31X4EOxuHSfh.png](https://newscast.jp/attachments/s5UESM1d31X4EOxuHSfh.png)
クラスター株式会社は、大阪・関西万博で展示終了したパビリオン「ふとももEXPO」のデジタルアーカイブワールドを10月10日より公開しました。これは、リアルイベントのレガシー活用という社会課題に対し、メタバースが提供する新たなソリューションを示すモデルケースとして実施され、物理的な制約を超えていつでもアクセス可能なバーチャル空間で体験を共有できます。
[https://newscast.jp/attachments/wvImiQ3LkHRj8NG2G4kU.jpg](https://newscast.jp/attachments/wvImiQ3LkHRj8NG2G4kU.jpg)
日本最大級のメタバースプラットフォーム「cluster」を運営するクラスター株式会社は、カナデビア株式会社の「Kanadevia Virtual Museum」を2025年11月1日より一般公開します。このミュージアムは、ごみ焼却発電プラントや洋上風力発電などの巨大インフラをメタバース上に実物大で再現し、普段は立ち入れない場所をゲーム感覚で探検できる「新しい社会科見学」として、教育現場での活用も期待されています。
[https://newscast.jp/attachments/hBHttNtojRgcgUyboul7.png](https://newscast.jp/attachments/hBHttNtojRgcgUyboul7.png)
株式会社ユークリッドは、従業員50名以下の中小企業向けに、経営者が「手離れよく任せられる」経営伴走サービス『社外社長室』を正式に開始しました。このサービスは、社長の人生と会社の物語に深く共感し、まるで社内の仲間のように経営課題の実行まで伴走する「物語のカタリスト」が特徴で、経営者は本来の使命である「未来を描く仕事」に集中できるようになります。
株式会社KATAZUKEは、伝統工芸美濃焼を採用した液体ソープディスペンサー「mino雫」を、10月1日より名古屋市ふるさと納税の返礼品として提供開始しました。北欧デザインと美濃焼の伝統技法を融合させたこの製品は、セミマット仕上げの磁器製ボディと機能的な大型ポンプが特徴で、上質な空間演出と実用性を両立します。
[https://newscast.jp/attachments/AaNOnwzQZE6GvexAZA8G.jpg](https://newscast.jp/attachments/AaNOnwzQZE6GvexAZA8G.jpg)
レイ・アウトは、Xperia 10 VII シリーズ専用のケースやフィルムなど各種アクセサリーを、Xperia 10 VIIの発売に合わせて順次販売開始しました。ハイブリッドケース「maru Pietra」や「Puffull +レンズガードリング」、手帳型レザーケース、抗菌抗ウィルスPETフィルム、全面保護ガラスフィルムなど、多様なニーズに応える製品がラインナップされています。
[https://newscast.jp/attachments/xjPfg1AOkqatgu7cAS5f.jpg](https://newscast.jp/attachments/xjPfg1AOkqatgu7cAS5f.jpg)
みん100株式会社は、消費者の声をもとに100円ショップ向けに開発された新商品「曲がるストローミニ」を全国の100円ショップで販売開始しました。この商品は、ストローコップに使うストローの長さと太さに関する消費者の悩みを解決するため、直径6×全長160mmという「ちょうどいいサイズ」を実現し、110本入りで110円(税込)という高いコストパフォーマンスも特徴です。
[https://newscast.jp/attachments/EzcZVbKya4eXXfXtqdcK.jpeg](https://newscast.jp/attachments/EzcZVbKya4eXXfXtqdcK.jpeg)
#### 教育・キャリア関連ニュース
近畿大学は、令和7年(2025年)10月17日から23日までの期間、東大阪・奈良・和歌山・広島・福岡キャンパスの学生を対象とした就活支援イベント「業界研究フェア~秋の陣~」を開催します。早期化する就職活動に対応するため、本学学生の採用意欲が高い優良企業149社と対面およびオンラインで交流できる場を提供し、学生の業界・企業理解を促進します。
新井一樹氏の著書『シナリオ・センター式 物語のみがき方』が、2025年10月18日に日本実業出版社より刊行されます。発売前に異例の重版が決定した本書は、「推敲=物語をよりよくみがく力」に焦点を当て、シナリオ・センターのロジックをもとに作品の魅力を高める実践的な方法を解説しており、生成AI時代における人間の「物語をみがく力」の重要性を訴求しています。
[https://newscast.jp/attachments/2Efgkg9UDnPK7ZDTeamT.jpg](https://newscast.jp/attachments/2Efgkg9UDnPK7ZDTeamT.jpg)
株式会社留学ジャーナルは、中学生・高校生向けの「春休みグループツアー」6ヵ国13コースの申込受付を10月9日より開始しました。初の海外渡航者でも安心して参加できるよう、経験豊かな添乗員が同行し、語学研修や観光アクティビティ、海外生活・文化体験を通じて、自立心や視野を広げる機会を提供します。
[https://newscast.jp/attachments/AUr1fgnC1sqRnKMP9hb7.jpg](https://newscast.jp/attachments/AUr1fgnC1sqRnKMP9hb7.jpg)
森ノ宮医療大学は、2025年11月9日に高校1・2年生を対象とした「医療の仕事体験フェスティバル」を開催します。多岐にわたる医療系専門職の学科を擁する大学として、体験プログラムや保護者セミナーを通じて、医療分野への理解を深める機会を提供し、将来の進路選択を支援します。
[https://newscast.jp/attachments/IAOpsGwvFz3wtQhCJONU.png](https://newscast.jp/attachments/IAOpsGwvFz3wtQhCJONU.png)
JAC Recruitmentは、業界や職種の動向を人材視点で解説するYouTubeチャンネル『JACリサーチ チャンネル』を開設しました。元フジテレビアナウンサーの田中大貴氏を司会に迎え、「ジョブ型雇用の今」や「高度人材が動かす半導体業界」といったテーマで、JACリサーチのセンター長が解説を行います。
[https://newscast.jp/attachments/Y3LvatOMChUxqdwA1Vfg.png](https://newscast.jp/attachments/Y3LvatOMChUxqdwA1Vfg.png)
#### 製品・キャンペーン関連ニュース
JAタウンでは、秋元真夏さんがMCを務めるYouTube番組「ゆるふわたいむ」で紹介された鹿児島県産マロンゴールドの販売と、番組グッズが当たるコラボキャンペーンを10月10日から10月26日まで実施しています。
[https://newscast.jp/attachments/uW28O31ax2YqjEqpu0zJ.jpg](https://newscast.jp/attachments/uW28O31ax2YqjEqpu0zJ.jpg)
[https://newscast.jp/attachments/sFkA7usBGpl4aVj81oU0.jpg](https://newscast.jp/attachments/sFkA7usBGpl4aVj81oU0.jpg)
JA全農が運営する「JAタウン」のショップ「三重の味自慢」では、11月末まで「国産を食べて応援キャンペーン」を開催中で、松阪牛をはじめとする三重県産の農畜産物80点以上が「お客様送料負担なし」で購入できます。
[https://newscast.jp/attachments/1FpPPyU0iR3QXjgF96mM.jpeg](https://newscast.jp/attachments/1FpPPyU0iR3QXjgF96mM.jpeg)
JA全農が運営する産地直送通販サイト「JAタウン」のショップ「まるっと完食おおいた~美味しいもんいっぱい送っちゃんけん~」では、収穫しきれなかったものの、太陽の光を浴びて黄金に色づいた「黄かぼす 食べて応援企画」を実施しています。まろやかな酸味とほんのりとした甘みを含んだ特別な味わいの「黄かぼす」を購入することで、産地支援に繋がります。
[https://newscast.jp/attachments/VwNSAZfuKdMqet8Dc5we.jpg](https://newscast.jp/attachments/VwNSAZfuKdMqet8Dc5we.jpg)
カバヤ食品株式会社は、主力製品「タフグミ」ブランドで、お笑いコンビ「かまいたち」さん、ラッパー Zeebraさんら4王者を起用したWeb-CMと、DRAGON76さん描きおろしオリジナルグッズが当たるXキャンペーンを10月14日より実施します。「タフグミ」は累計販売個数1億個を突破し、2年連続グミ市場販売金額No.1を獲得しています。
[https://newscast.jp/attachments/1lRjxMCXUF1OEhwPIIGw.png](https://newscast.jp/attachments/1lRjxMCXUF1OEhwPIIGw.png)
[https://newscast.jp/attachments/S7nPWhQpwMsRMBJgKvla.png](https://newscast.jp/attachments/S7nPWhQpwMsRMBJgKvla.png)
株式会社GENDA GiGO Entertainmentは、個人Vtuberの猫麦とろろとコラボした「猫麦とろろ×GiGOキャンペーン-あいどるこれくしょん!-」を2025年10月25日から12月7日まで開催します。対象のクレーンゲームへの500円投入でホロステッカーを進呈するほか、GiGO限定景品やコラボたい焼き、ドリンクなども登場します。
[https://newscast.jp/attachments/c0oVTI388D95a3iolLfM.jpg](https://newscast.jp/attachments/c0oVTI388D95a3iolLfM.jpg)
株式会社GENDA GiGO Entertainmentは、TVアニメ「光が死んだ夏」とのコラボキャンペーンを2025年10月25日から11月24日までGiGOグループのお店で開催します。対象のクレーンゲームに500円投入でオリジナルクリアカードがもらえるほか、GiGO限定景品やコラボたい焼き、ドリンクなども販売されます。
[https://newscast.jp/attachments/Es9reGgWJ9uJYJRgJtHo.jpg](https://newscast.jp/attachments/Es9reGgWJ9uJYJRgJtHo.jpg)
株式会社GENDA GiGO Entertainmentは、株式会社ロッテとのコラボレーションにより、ロッテの人気商品をモチーフにしたGiGO限定プライズを、全国のGiGOグループのお店で10月11日より3ヵ月連続で展開します。第1弾として、ロッテのロングセラー商品「パイの実」をモチーフにしたデザイン雑貨4アイテムが登場します。
[https://newscast.jp/attachments/f4OY8ex91IkfzJjANBrV.webp](https://newscast.jp/attachments/f4OY8ex91IkfzJjANBrV.webp)
株式会社マネースクエアは、10月11日からラジオNIKKEI共催のWEBセミナー「年末相場を読む」を開催します。現役ファンドマネージャーや経済アナリストが登壇し、米国政治・金融政策の動向、エリオット波動分析、年末見通しなど、実践的テクニックと中長期の相場展望を学べるプログラムを提供します。
[https://newscast.jp/attachments/3UIfzYNeMsXlSjDqBi4z.jpg](https://newscast.jp/attachments/3UIfzJgYNeMsXlSjDqBi4z.jpg)
ふるさと納税返礼品の還元率を比較するサイト「とくさと」が、ふるさと納税でもらえる「パソコン」の還元率ランキングを発表しました。愛知県幸田町の「HP ProDesk 400/800 G4 DM 小型デスクトップパソコン」が還元率87.78%で1位を獲得しました。
ふるさと納税返礼品の還元率を比較するサイト「とくさと」が、ふるさと納税でもらえる「ベビーカー」の還元率ランキングを発表しました。愛知県犬山市の「カトージTOBERU」が還元率31.36%で1位を獲得しました。
株式会社フェイスのノリモノ雑貨ブランド「CAMSHOP.JP」は、2025年に生産終了する50ccバイクの歴史に敬意を表し、Hondaのオフィシャルライセンスのもと、名車ロゴを集めた特別Tシャツ『50cc BIKES』デザインTシャツを販売します。価格は4,950円(税込)で、Amazonなどでも購入可能です。
[https://newscast.jp/attachments/VkJWWsFuTAGtsasMLacZ.jpg](https://newscast.jp/attachments/VkJWWsFuTAGtsasMLacZ.jpg)
PowerArQ(加島商事株式会社)は、寒冷下で快適に過ごせる電熱ウェア「Volteraシリーズ」2製品(「PowerArQ Voltera Glove」「PowerArQ Voltera Neck Warmer」)の予約受付を10月7日より開始しました。3段階の温度調節に対応し、バイクバッテリーやモバイルバッテリーで稼働可能で、専用ケーブルで複数製品を同時給電できます。発売記念キャンペーンも実施中です。
[https://newscast.jp/attachments/B0EOFAHlX1dl5zyHdy9c.png](https://newscast.jp/attachments/B0EOFAHlX1dl5zyHdy9c.png)
片岡物産株式会社は、世界で愛されるココアブランド<バンホーテン>から「ホット チョコレート 2025-2026 リミテッドデザイン缶(150g)」を、2025年10月21日より数量限定で発売します。クラシカルな円形缶には白猫が描かれ、濃厚なホットチョコレートと共に心温まるひとときを提供します。
[https://newscast.jp/attachments/UfZSnqsxdTroaNxgs0sC.jpg](https://newscast.jp/attachments/UfZSnqsxdTroaNxgs0sC.jpg)
ハクバ写真産業株式会社は、2025年10月10日より、カメラバッグブランド「プラスシェル」から、日常使いとカメラ収納を両立する「インナーケースタイプ」の新作カメラバッグ4モデルを発売します。多様なライフスタイルにフィットするデザインと機能性を兼ね備え、ミラーレス一眼から交換レンズまで収納できるラインナップです。
[https://newscast.jp/attachments/eyzothhewnezmNHx5RLf.jpg](https://newscast.jp/attachments/eyzothhewnezmNHx5RLf.jpg)
雪印メグミルク株式会社は、期間限定ポップアップストア「雪印メグミルクの湯in大阪」を2025年10月25日から26日に阪急大阪梅田駅1階ビッグマン前広場にてオープンします。銭湯をテーマにしたこのストアでは、「雪印コーヒー」などのびん商品詰め合わせやオリジナルグッズを販売し、疑似銭湯空間でびん飲料文化を体験できます。
[https://newscast.jp/attachments/PMF5tJJPpVasDTinSlDc.png](https://newscast.jp/attachments/PMF5tJJPpVasDTinSlDc.png)
電報屋のエクスメールは、10月19日の「孫の日」に向けて、由来や過ごし方、贈り物の選び方、電報を活用した贈り方を紹介するコラムを公開しました。ギフトと共にメッセージを伝える「電報×ギフト」の新しい贈り方を提案し、限定の電報台紙やギフト、文例を紹介しています。
[https://newscast.jp/attachments/bUrKamKABfqZuPWceH8c.png](https://newscast.jp/attachments/bUrKamKABfqZuPWceH8c.png)
ライフコーポレーションは、おせちやクリスマスケーキ、ギフト各種をオンラインで注文・予約できる「ライフのオンラインストア」を9月に開設しました。12月10日までに5,000円以上購入するとライフのポイント1,000ポイントをプレゼントする初回購入キャンペーンを実施中です。
[https://newscast.jp/attachments/Y4OlCisUBw1frBGqtQRJ.jpg](https://newscast.jp/attachments/Y4OlCisUBw1frBGqtQRJ.jpg)
ライフコーポレーションは、大田区立山王小学校との協同授業で児童が考案した4つの新作パンを商品化し、10月13日から大田区内の3店舗で期間限定販売します。このプロジェクトは、児童の実社会体験を目的とし、パンの企画からプレゼンまで約40回の授業を経て実現しました。
[https://newscast.jp/attachments/rInzDIoaC9iQVbxwUbSk.JPG](https://newscast.jp/attachments/rInzDIoaC9iQVbxwUbSk.JPG)
PharmaFoodsは、清涼飲料水『ニューモD』を2025年9月29日より全国で発売しました。本製品は、HGP(加水分解卵殻膜末)、PharmaGABA(γ-アミノ酪酸)、亜鉛を配合した栄養機能食品で、独自の特許処方である「ランペップ」とマカエキスを組み合わせ、エナジードリンク風味で飲みやすい設計となっています。
#### イベント・エンターテインメント関連ニュース
株式会社エイプリル・データ・デザインズは、ブラウザで楽しめる多人数参加型学園コミュニティ「キャラフレ」にて、『2025 体育祭』イベントを開催します。全18種目のミニゲームでチーム対抗戦を行い、優勝チームには部屋に飾れる優勝旗アイテムがプレゼントされます。
[https://newscast.jp/attachments/3sBwTSfKHXGWphnrjqc1.jpg](https://newscast.jp/attachments/3sBwTSfKHXGWphnrjqc1.jpg)
株式会社SCRAPと株式会社東京ドームは、謎解きグッズの祭典『ナゾトキマーケット』を東京ドームシティ プリズムホールで2025年11月8日、9日に開催し、販売されるグッズの一部を発表しました。総勢76ブースが出展し、新作リアル脱出ゲーム『閉ざされた東京ドームシティからの脱出』も同時開催されます。
[https://newscast.jp/attachments/M89q0qArY75fsOttT4b0.png](https://newscast.jp/attachments/M89q0qArY75fsOttT4b0.png)
株式会社SCRAPは、自宅で遊べるリアル脱出ゲーム最新作『JACKEYES 7月のトロイメライ』を販売開始しました。他人の視点を盗み見ることができる不思議なアイテム「ジャックアイ」を使い、未解決事件の真相に迫る新感覚のサスペンスゲームで、パッケージ版には特典ステッカーが付属します。
[https://newscast.jp/attachments/lXjA5MZMc88O6iVkXzpJ.png](https://newscast.jp/attachments/lXjA5MZMc88O6iVkXzpJ.png)
劇団劇作家主催の舞台『玄海灘』が、2025年12月11日から14日まで上野ストアハウスで上演されます。「日韓国交正常化60周年」「戦後80年」の節目を記念し、韓国語・英語字幕付きの多言語上演を実現し、帝国主義の嵐が吹き荒れる時代を生きる3人の青年の葛藤と選択を描きます。
[https://newscast.jp/attachments/gBfxmjjfTfXgo3eAxD22.png](https://newscast.jp/attachments/gBfxmjjfTfXgo3eAxD22.png)
『大誘拐~四人で大スペクタクル~』が2025年10月10日から東京・シアター1010で上演後、地方公演も行われます。中山優馬、柴田理恵、風間杜夫、白石加代子が出演し、刑務所で知り合った戸並健次らが紀州の大富豪・とし子刀自を誘拐する前代未聞の物語が描かれます。
[https://newscast.jp/attachments/mRg360nLmJTQWy9D4itJ.jpg](https://newscast.jp/attachments/mRg360nLmJTQWy9D4itJ.jpg)
「バック・トゥ・ザ・フューチャー」inコンサート東京公演が、10月24日から26日に東京国際フォーラムホールAで開催されます。映画第1作目をノーカットで大スクリーンに上映し、80名を超えるフルオーケストラが音楽を生演奏で届けます。公演オリジナルグッズの販売も決定し、40周年記念ロゴ入りのアイテムも登場します。
[https://newscast.jp/attachments/tVcZLWAEt0aIf7AwuqBn.png](https://newscast.jp/attachments/tVcZLWAEt0aIf7AwuqBn.png)
ひらかたパークでは、2025年11月1日から2026年4月5日まで「光の遊園地」が開催され、イルミネーショングッズやバラをモチーフにしたフードが販売されます。イルミネーションスタンプラリーも実施され、今年はローズガーデン誕生70周年を記念してメリーゴーラウンドも豪華に装飾されます。
[https://newscast.jp/attachments/aFRChl6o0RLjPM6bdSva.jpg](https://newscast.jp/attachments/aFRChl6o0RLjPM6bdSva.jpg)
[https://newscast.jp/attachments/jRzfaiiAuFylLpd6Jw6n.jpg](https://newscast.jp/attachments/jRzfaiiAuFylLpd6Jw6n.jpg)
[https://newscast.jp/attachments/0GgxXmFOqCMtP36M7sj5.jpg](https://newscast.jp/attachments/0GgxXmFOqCMtP36M7sj5.jpg)
舎人公園では、10月25日に「防災フェスタ」を開催します。ダンボール倒壊家屋からの脱出訓練やガレキ歩行、東武バスの非常口確認、消防・警察・自衛隊車両の展示、水道利用や給電車両の紹介など、災害時に役立つ知識や技術を体験を通じて楽しく学べるプログラムが用意されています。
[https://newscast.jp/attachments/pWjIzpH5gB3VmwRlngSQ.jpg](https://newscast.jp/attachments/pWjIzpH5gB3VmwRlngSQ.jpg)
Kiba Parkでは、11月8日と9日に「KIBA FESTA 2025」が開催されます。近隣企業や団体が公園から地域の魅力や価値を発信するイベントで、ワークショップ、伝統文化の紹介・体験、マルシェ、デジタルスタンプラリーなどが実施され、木場・深川地区の魅力を発信します。
[https://newscast.jp/attachments/phQgDs2NCzqpDs7FehZ9.png](https://newscast.jp/attachments/phQgDs2NCzqpDs7FehZ9.png)
浜離宮恩賜庭園では、10月31日から11月5日までの6日間、「栗名月」に合わせて開園時間を21時まで延長し、夜の園内をライトアップします。月見台のお供え式や伝統芸能公演、お月見特別ガイドツアー、限定抹茶セットの販売などが行われ、特別なルートで夜の景観を楽しむことができます。
[https://newscast.jp/attachments/d91u8zDktmvOkOx40cv5.png](https://newscast.jp/attachments/d91u8zDktmvOcOx40cv5.png)
[https://newscast.jp/attachments/kbjCphpeV8NXNQqfc4g8.jpg](https://newscast.jp/attachments/kbjCphpeV8NXNQqfc4g8.jpg)
epica OKINAWAは、2025年10月12日(日)にSP GUEST LIVEとして8MCによるヒップホップ・クルーBAD HOPのメンバーBark氏を迎え、イベントを開催します。Bark氏はソロアルバム『South Side Story』をリリースし、エモーショナルなビートに乗せた自身の人生やパーソナルなストーリーを描くラップアルバムとして注目されています。
[https://newscast.jp/attachments/z9LSy6uFNQpgrHqIrNdk.jpeg](https://newscast.jp/attachments/z9LSy6uFNQpgrHqIrNdk.jpeg)
[https://newscast.jp/attachments/Dqe36Ax6xAYu6Liwj87G.jpg](https://newscast.jp/attachments/Dqe36Ax6xAYu6Liwj87G.jpg)
#### 地域・文化関連ニュース
星野工房は、ダウン症重度画家「沖縄のピカソ」として知られる小波津有希さんの半生を描くマンガ制作のクラウドファンディングプロジェクトを2025年9月29日にREADYFORで開始しました。このプロジェクトは、有希さんと母親の二人三脚の人生をマンガ化し、同様の境遇にある家族に希望を届けることを目的としています。マンガはバイリンガル対応で、図書館や特別支援学校へ寄贈される予定です。
[https://newscast.jp/attachments/XYModDVyr6eRT5IpJbpM.jpg](https://newscast.jp/attachments/XYModDVyr6eRT5IpJbpM.jpg)
京都・四条大宮の「kumagusuku」跡地に、クリエイティブ複合施設『sōma』(ソーマ)が2025年11月14日にグランドオープンします。建築士・西山涼二氏が主宰するこの施設は、「リビングギャラリー」をコンセプトに、作品展示だけでなく、制作、会話、偶然の出会いが日常的に生まれる「生きたギャラリー」を目指します。飲食店、アトリエ/ギャラリー、ライブラリ、コワーキングスペースの4つの機能を備え、施設全体が立体的なギャラリーとして機能します。
[https://newscast.jp/attachments/iokhejN8I1zAIMjMzGZ7.jpg](https://newscast.jp/attachments/iokhejN8I1zAIMjMzGZ7.jpg)
BS12 トゥエルビは、田中美久さん出演のグルメ番組「ざっくり地図で巡る!~」で、群馬県の月夜野エリアの鶏料理やボリューミーなオムライス、新潟県の人気おにぎりやソウルフード「イタリアン」などを紹介しています。田中美久さんの秋を感じさせるリアクションが魅力です。
[https://newscast.jp/attachments/XqyGwdw0z3L84l9pC5g3.jpeg](https://newscast.jp/attachments/XqyGwdw0z3L84l9pC5g3.jpeg)
[https://newscast.jp/attachments/0msU9Rd5gHN2O3t68IF9.jpeg](https://newscast.jp/attachments/0msU9Rd5gHN2O3t68IF9.jpeg)
広島ホームテレビは、毎週土曜「ひろしま深掘りライブ フロントドア」で2025年カープ最終戦の様子を放送し、助っ人ドミニカン・ファビアン選手のインタビューや、驚きの価格で弁当を販売するスーパーに密着。さらに、東広島・西条の酒まつり会場から生中継を行い、サイン入りユニフォームが当たる企画も実施しました。
[https://newscast.jp/attachments/Pj8cH3s5dNQjYVqM9K1B.jpg](https://newscast.jp/attachments/Pj8cH3s5dNQjYVqM9K1B.jpg)
[https://newscast.jp/attachments/9ncdrALoI5L6Lmjf5hAt.jpg](https://newscast.jp/attachments/9ncdrALoI5L6Lmjf5hAt.jpg)
千葉市稲毛区のワンズモールに、GiGOのクレーンゲーム専門店として国内最大規模となる「GiGOクレーンゲームオアシス ワンズモール」がオープンします。営業面積約800坪に270台のクレーンゲームを備え、10円プレイコーナーやキッズライドも設置。オープン記念としてお笑い芸人「バンビーノ」によるステージイベントや、千葉市動物公園とのタイアップ企画も実施されます。
[https://newscast.jp/attachments/merTYPpNGmsXhld8OzME.jpg](https://newscast.jp/attachments/merTYPpNGmsXhld8OzME.jpg)
[https://newscast.jp/attachments/D3gqUlLGgAnMPMl0kfRn.jpg](https://newscast.jp/attachments/D3gqUlLGgAnMPMl0kfRn.jpg)
Keihan Holdingsと京阪電気鉄道は、2025年10月26日からの3000系プレミアムカー2両化を記念し、11月25日まで『3000系プレミアムカー2両化記念キャンペーン』を実施します。平日昼間時のプレミアムカークラブポイント5倍進呈や、おけいはんポイント交換キャンペーンのほか、記念ヘッドマークを掲出した車両も運行されます。
[https://newscast.jp/attachments/9876PWWOtUfHR4PKf9PW.jpg](https://newscast.jp/attachments/9876PWWOtUfHR4PKf9PW.jpg)
京阪電気鉄道は、大津線の一部区間(四宮駅~びわ湖浜大津駅間およびびわ湖浜大津駅~御陵駅間)で、2025年11月11日から2026年2月3日までの計9日間、22時以降の列車を繰り上げ(運休)実施します。これにより、深夜の時間帯の保守工事が効率的に行われるとともに、運休時間帯には振替輸送が実施されます。
[https://newscast.jp/attachments/jnJSkSmIhPS3qMyEnmjD.jpg](https://newscast.jp/attachments/jnJSkSmIhPS3qMyEnmjD.jpg)
西明石のホテルキャッスルプラザでは、10月10日から11月9日まで、秋の味覚を楽しむグルメフェア「FourSeasons2025~実~」を開催しています。紅葉鯛や秋刀魚、丹波黒味噌など、旬の食材を和・洋・中の料理人が趣向を凝らして仕立てた御膳やコース料理を提供し、深まる秋の気配を味わいと彩りで楽しめます。
[https://newscast.jp/attachments/xjvItVBLBPwUaoKzXoYO.jpg](https://newscast.jp/attachments/xjvItVBLBPwUaoKzXoYO.jpg)
京都市のパティスリー洛甘舎は、人気の「洛甘バターサンド」に秋限定の<マロン>を10月9日にラインナップ追加しました。マロンペーストと渋皮栗を使用したこの商品は、定番の<プレーン>、<抹茶>と合わせて、「和魂洋才」をコンセプトにした甘さ控えめの口溶けの良いバターサンドとして提供されています。
[https://newscast.jp/attachments/iEZD90dHeSZmazjrk15l.jpg](https://newscast.jp/attachments/iEZD90dHeSZmazjrk15l.jpg)
那須塩原市観光局は、塩原温泉の名物「トテ馬車」を2025年10月18日、19日、12月7日、24日の4日間、温泉街ルートで復活運行します。語り部とともに塩原温泉街を巡り、ご当地グルメ「とて焼」の引換券も付いてきます。那須千本松牧場の「蓮くん」が馬車を牽引します。
[https://newscast.jp/attachments/8Ivl3UkuFQ9EglO3CPIK.jpeg](https://newscast.jp/attachments/8Ivl3UkuFQ9EglO3CPIK.jpeg)
伊豆急行線「伊豆稲取駅」からアクセスできる細野高原では、2025年11月16日に体験型アクティビティ「戦チャンバラ合戦 2025 in 細野高原」が開催されます。スポンジ素材の刀とカラーボールを使った団体戦で、大人も子どもも楽しめる爽快な非日常体験を提供します。
[https://newscast.jp/attachments/glnjKVNebqOZsiQf0mTy.jpg](https://newscast.jp/attachments/glnjKVNebqOZsiQf0mTy.jpg)
英一郎製磁は、愛犬の手元供養用ペットお骨壷「ZUTTO」シリーズの「ミニチュアダックス」を2025年10月1日にリニューアル発売しました。磁器彫刻作家の繊細な技術を活かし、愛犬と“ずっと”一緒にいたい飼い主の想いに寄り添う作品として、洗練されたデザインと実用性を兼ね備えています。
[https://newscast.jp/attachments/aWV6Pw7Mb6py11sbeLcb.jpg](https://newscast.jp/attachments/aWV6Pw7Mb6py11sbeLcb.jpg)
福岡発の手作り辛子明太子ブランド「真喜(しんき)」は、海老名マルイにて第2弾の期間限定販売イベントを10月8日から14日まで開催しています。オンラインショップでしか購入できない人気の「明太ねぇさんの無水明太子」を試食販売し、「無水製法」による濃厚でコク深い味わいを直接体験できる機会を提供します。
[https://newscast.jp/attachments/mExF8OuLAqXxtrXy7iwR.jpg](https://newscast.jp/attachments/mExF8OuLAqXxtrXy7iwR.jpg)
株式会社KATAZUKEは、伝統工芸美濃焼を採用した液体ソープディスペンサー「mino雫」を、10月1日より名古屋市ふるさと納税の返礼品として提供開始しました。北欧デザインと美濃焼の伝統技法を融合させたこの製品は、セミマット仕上げの磁器製ボディと機能的な大型ポンプが特徴で、上質な空間演出と実用性を両立します。
[https://newscast.jp/attachments/AaNOnwzQZE6GvexAZA8G.jpg](https://newscast.jp/attachments/AaNOnwzQZE6GvexAZA8G.jpg)
#### メディア関連ニュース
BS12 トゥエルビは、ガメラ生誕60周年を記念し、4Kデジタル修復版となった昭和ガメラ3作品をテレビ初放送。さらに樋口真嗣監督が特技監督を務めたガメラ平成3部作も一挙放送します。また、特別番組「船越英一郎の昭和再生ファクトリー」では、4Kデジタル修復に密着し、樋口真嗣監督のインタビューや子役の内田喜郎さんによる秘話が公開されます。
[https://newscast.jp/attachments/EUadRTSIqV8rEdlUuB7s.jpg](https://newscast.jp/attachments/EUadRTSIqV8rEdlUuB7s.jpg)
BS12 トゥエルビは、フー・イーティエン、チャン・ジンイー出演のロマンス時代劇「惜花芷(せきかし)」を10月17日よりBS初放送します。これは、落ちぶれた名門一家の女性たちが困難を乗り越え前向きに生き抜く愛と成長の物語で、数々の大ヒット時代劇を手がけたチュー・ユイパンが総演出を務めています。
[https://newscast.jp/attachments/eyzothhewnezmNHx5RLf.jpg](https://newscast.jp/attachments/eyzothhewnezmNHx5RLf.jpg)
CS放送「衛星劇場」では、韓国の俳優チ・チャンウクの出演ドラマ&バラエティを10月に放送します。「于氏王后」では約10年ぶりの時代劇出演で高句麗第9代王コ・ナンムを演じ、「僕を溶かしてくれ」では冷凍人間同士のロマンス、さらにオリジナル番組「韓流スタージャックS」で素顔に迫ります。
[https://newscast.jp/attachments/jQYwagTY2JOb5nhs6JN7.jpg](https://newscast.jp/attachments/jQYwagTY2JOb5nhs6JN7.jpg)
[https://newscast.jp/attachments/es4cP9bbou9afTch4LxO.jpg](https://newscast.jp/attachments/es4cP9bbou9afTch4LxO.jpg)
新日本法規出版株式会社は、新日本法規WEBサイト法令記事「“スポーツ仲裁”をぶっ壊す!?」を2025年10月10日に公開しました。この記事では、スポーツ仲裁が事実上強制的に課される実態に問題提起し、仲裁合意の無効を争う判決事例などを紹介し、紛争の性質に応じた適切な解決手段の選択を検討すべき時期が来ていると論じています。
[https://newscast.jp/attachments/G60zTkapEBmVPfwRuLCh.png](https://newscast.jp/attachments/G60zTkapEBmVPfwRuLCh.png)
オーバーラップは、秋の大収穫祭としてライトノベルとコミックス600冊以上が無料になるキャンペーンを2025年10月10日から19日まで電子ストアで実施しています。『お気楽領主の楽しい領地防衛』や『とんでもスキルで異世界放浪メシ』など、多数のメディアミックス化作品がラインナップされています。
[https://newscast.jp/attachments/MiVyI79eIDtnGZeaNF8q.png](https://newscast.jp/attachments/MiVyI79eIDtnGZeaNF8q.png)
#### その他のニュース
ドイツのパフォーマンスバイクブランド「キャニオン」の日本法人であるキャニオンバイシクルズ・ジャパン株式会社は、日本独自企画モデル「アルティメットCFR カンパニョーロエディション」において、ゾンダ完成車の価格を見直し、より多くのライダーが手に取りやすい価格に設定しました。ハイエンドモデルのCFRフレームを採用しながら、フレームセット399,000円、ゾンダ完成車599,000円という特別価格での提供を実現しています。
[https://newscast.jp/attachments/T9v6y3ylDY7QC3bVDTnM.jpg](https://newscast.jp/attachments/T9v6y3ylDY7QC3bVDTnM.jpg)
[https://newscast.jp/attachments/vTjoGxcf5o55Vi7M5tD3.jpg](https://newscast.jp/attachments/vTjoGxcf5o55Vi7M5tD3.jpg)
近畿大学工業高等専門学校は、令和7年(2025年)10月17日に全学生792人を対象に「南海トラフ震度7以上の強い地震から身を守る」をテーマとした「令和7年度避難訓練」を実施します。地震発生時の安全確保のためのシェイクアウト訓練や避難経路の確認、初期消火訓練を通じて、学生が災害時に迅速かつ落ち着いて行動できるよう備えます。
高知県四万十町では、内閣府や高知県と連携し、県内初となる「避難生活支援リーダー/サポーター研修」を10月18日、19日の2日間で開催します。この研修では、演習やグループワークを通じて避難生活の環境改善のための実践的な知識・ノウハウを学び、災害時に貢献できる地域の人材育成を目指します。
近畿大学おおさかメディカルキャンパスは、医学部・病院の開設50周年に合わせ、2025年10月19日にオープニング記念式典を開催します。式典では近大マグロの解体ショーや地元堺市の和太鼓チームと近畿大学吹奏楽部のスペシャルステージが披露され、20日、21日には地域住民向けの内覧会も実施されます。
近畿大学産業理工学部は、2025年10月18日に大学グラウンドで地元少年野球チームの児童を対象に野球教室を開催します。福岡ソフトバンクホークスとのスポンサー契約に基づき、OB3名が直接指導を行い、子どもたちの健全な成長支援と地域活性化に貢献します。
小山内裏公園では、11月1日に「里山ヨガCafé」を開催し、参加者を募集しています。木々に囲まれた芝生の上で行うヨガでリフレッシュした後、お茶やお菓子を楽しみながら講師を囲んで語り合うカフェタイムを設けています。初めての方も歓迎で、適度な運動とリラックスで心地よい週末を過ごせる機会です。
[https://newscast.jp/attachments/EmqM6sekG6wswzQDj84X.JPG](https://newscast.jp/attachments/EmqM6sekG6wswzQDj84X.JPG)
株式会社アルコグランデは、西日本豪雨災害を経験した故郷広島で、消防団員の日常を描いた舞台【We Are Fire Fighters ~故郷に想いを馳せて~】広島公演を実施するため、クラウドファンディングサイト「CAMPFIRE」で支援を募っています。主演の森田桂介氏(広島県三原市出身)の思いから生まれたこの作品は、消防関係者へのエールと地域への感謝を込めて上演されます。
[https://newscast.jp/attachments/5uaQARxsGPEocp97dDYj.jpg](https://newscast.jp/attachments/5uaQARxsGPEocp97dDYj.jpg)
近畿大学産業理工学部、近畿大学九州短期大学、近畿大学附属福岡高等学校の学生・生徒が、2025年10月19日に開催される第38回「I LOVE 遠賀川」に参加し、ボランティアで清掃活動を行います。飯塚大橋から徳前大橋までの約3kmにわたる範囲でゴミ拾いを実施し、地域美化に貢献するとともに地域住民と交流を深めます。
名古屋モザイク工業株式会社は、第14回Instagramフォトコンテスト「たたずまい」の受賞作品をWEBサイトで公開しています。このコンテストは、タイルで魅せる玄関空間をテーマに募集され、タイルがもたらす温もりや光のゆらぎを取り入れた作品の数々が、日常の一瞬を豊かに彩る様子を映し出しています。
[https://newscast.jp/attachments/gBfxmjjfTfXgo3eAxD22.png](https://newscast.jp/attachments/gBfxmjjfTfXgo3eAxD22.png)
株式会社cielo azulは、配偶者や恋人がいる男女および探偵事務所関係者を対象に「浮気調査に関する意識と実態」についての調査を実施しました。依頼者の約8割が「密会現場の写真・動画」を決定的証拠と考える一方で、探偵の多くはそれを「裁判では証拠力が弱い」と評価。依頼者の期待と現場の実態に明確なギャップが存在することが明らかになりました。
[https://newscast.jp/attachments/tmJr9ARAuG4OvWHLDAu9.png](https://newscast.jp/attachments/tmJr9ARAuG4OvWHLDAu9.png)
[https://newscast.jp/attachments/wnknw3PtNNKbTfi7VNid.png](https://newscast.jp/attachments/wnknw3PtNNKbTfi7VNid.png)
CBS College Platformは、文脈的行動科学(CBS)を楽しく学ぶ・体感するプラットフォームとして開設されました。月2~4回合計60分のオリジナル動画、CBSに関する記事やコラム、Q&A、臨床ツールの紹介・解説などを提供し、セミナーやイベントの早期情報解禁や先行予約の権利も付与されます。
[https://newscast.jp/attachments/AqirieVG8lBvRyji9rJ6.jpg](https://newscast.jp/attachments/AqirieVG8lBvRyji9rJ6.jpg)
株式会社無添加住宅は、環境配慮への意識の高まりを受け、柿渋を使った昔ながらの一閑張りの技法でカゴやカゴバッグを作るワークショップを10月16日にショールームで開催します。参加者は素材選択から防水性付与まで体験でき、実用的かつ芸術的な作品制作を通じて自然素材に触れる機会となります。
#### 金融関連ニュース
名古屋エムケイ株式会社は、10月14日からのタクシー運賃値上げに伴い、独自のプリペイド&ポイントカード「TACPO(タクポ)」を活用した3つのキャンペーンを実施します。期間中、ポイント還元率が5%にアップするほか、チャージや新規会員登録でポイントがもらえる特典を提供し、改定後もお得に利用できる機会を創出します。
[https://newscast.jp/attachments/uoIcQ6PJG3IVBonbWd6d.png](https://newscast.jp/attachments/uoIcQ6PJG3IVBonbWd6d.png)
#### 企業情報
ケイハングループのユニクロ関西国際空港店(仮)が2026年夏頃、関西国際空港第1ターミナル国際線出国エリアに開業予定です。店舗面積は約36坪となる見込みです。
#### ランキング
岡山理科大学は、タイムズ・ハイヤー・エデュケーション(THE)が発表した「世界大学ランキング2026」において、総合ランキングで1501+位に2年連続でランクインしました。国内ではランクインした115大学のうち52位タイと、大きく順位を上昇させています。中四国の私立大学でランクインしたのは同大学のみです。
#### 交通
相鉄バスは、2025年11月1日から旭営業所の路線バス「旭15系統」で完全キャッシュレスバスの実証運行を実施します。国土交通省の採択を受け、運転士の負担軽減や経営改善効果を検証し、本格運行に向けて顧客の理解醸成を図ります。運賃は均一料金で、交通系ICカードやタッチ決済、QRコード決済が利用可能です。
[https://newscast.jp/attachments/QoUMei8PfKGBmpD9ptMG.jpg](https://newscast.jp/attachments/QoUMei8PfKGBmpD9ptMG.jpg)
[https://newscast.jp/attachments/Sn9PuTTMqeV7GoQhu7ly.jpg](https://newscast.jp/attachments/Sn9PuTTMqeV7GoQhu7ly.jpg)
#### ファッション
株式会社シップスは、伝説的な写真集『TAKE IVY』とコラボレーションした限定コレクション『TAKE NVY(テイク ネイビー)』を10月10日より発売します。Tシャツ、スウェット、キャップなどを展開し、すべてアメリカ製にこだわり、アイビー文化を現代的に再解釈したラインナップとなっています。SHIPS銀座店ではPOP UP STOREも開催されます。
[https://newscast.jp/attachments/yELEP9R3pO1H5rkyDpf1.jpg](https://newscast.jp/attachments/yELEP9R3pO1H5rkyDpf1.jpg)
株式会社シップスは、adidas Originalsとのエクスクルーシブモデルとして、オールブラックの「SL 72」を10月17日より全国のSHIPS取扱店舗で発売します。1972年誕生の「SL」シリーズをベースに、アッパーからソールまで全てをブラックで統一した洗練されたデザインが特徴で、サイドのゴールドフォイルロゴが大人のカジュアルスタイルを格上げします。
[https://newscast.jp/attachments/UVArl82K0crY2pZ0R08F.jpg](https://newscast.jp/attachments/UVArl82K0crY2pZ0R08F.jpg)
#### ドラマ
SIZUKUが主演の寺西優真と共に熱演したドラマ『寺西一浩ミステリー・SPELL~死因~』の第3話がTVerのドラマランキングで33位にランクインし、話題を集めています。SIZUKUは娘を事故で失った母・角田孝子役を演じ、オープニングテーマ曲「輪廻」も担当しています。
[https://newscast.jp/attachments/zfcLli7CEMRhYOv9Dqex.jpg](https://newscast.jp/attachments/zfcLli7CEMRhYOv9Dqex.jpg)
#### 美容
医療機関専売エイジングケア化粧品「M-Dear(エムディア)」より、2025年のクリスマスコフレ「エムディア プレミアムコレクション」が数量限定で発売されます。現品サイズのクレンジングジェル、ホイップウォッシュに加え、プレミアムラインのセラージュ3DマスクやPGクリーミィリッチセラムのミニサイズが含まれ、通常価格より大幅にお得なセットとなっています。
[https://newscast.jp/attachments/9734oyBvY4Q0dZYcPdNP.jpg](https://newscast.jp/attachments/9734oyBvY4Q0dZYcPdNP.jpg)
#### 研究
奈良文化財研究所は、2024年度の調査研究成果をまとめた『奈良文化財研究所紀要2025』を発行しました。本書は販売されず、PDFデータが全国文化財総覧にて全文無料公開されています。
[https://newscast.jp/attachments/ihu3p4GqaowkzVdB7UnS.jpg](https://newscast.jp/attachments/ihu3p4GqaowkzVdB7UnS.jpg)
Building Frontier Open Intelligence Accessible to All
Today we're sharing the next phase of Reflection.
We're building frontier open intelligence accessi...
External Redirection
Redirecting you to external site in 3 seconds : https://lnkd.in/d66fYFpR
If you are not automatical...
News & Column - BRIDGE(ブリッジ)
News & Column - BRIDGE(ブリッジ)
Menu
マイページ/メルマガ
Search
Menu
Topics
Tokyo Fusion
Tech Daily
Ecosystem
取材...
Tokyo Fusion - BRIDGE(ブリッジ)
Tokyo Fusion - BRIDGE(ブリッジ)
Menu
マイページ/メルマガ
Search
Menu
Topics
Tokyo Fusion
Tech Daily
Ecosystem
取材会...
Tech Daily - BRIDGE(ブリッジ)
Tech Daily - BRIDGE(ブリッジ)
Menu
マイページ/メルマガ
Search
Menu
Topics
Tokyo Fusion
Tech Daily
Ecosystem
取材会
I...
BRIDGE(ブリッジ) - スタートアップをつなぐブログメ
BRIDGE(ブリッジ) - スタートアップをつなぐブログメディア
Menu
マイページ/メルマガ
Search
Menu
Topics
Tokyo Fusion
Tech Daily
Ecosyst...
BRIDGE(ブリッジ) - スタートアップをつなぐブログメ
BRIDGE(ブリッジ) - スタートアップをつなぐブログメディア
Menu
マイページ/メルマガ
Search
Menu
Topics
Tokyo Fusion
Tech Daily
Ecosyst...
BRIDGE (ブリッジ)の公式ウェブサイトhttps://thebridge.jp/にアクセスします。,サイト内の「Topics/注目テーマ」セクションにある「Tokyo Fusion」タグ(資金調達関連)https://thebridge.jp/tag/fundraiseをクリックして資金調達記事一覧ページに移動します。,さらに、「Tech Daily」タグhttps://thebridge.jp/tag/techdailyも確認し、最近のテックトレンド記事の中にAI資金調達に関する情報が含まれていないかを確認します。,各記事の公開日を「ここ一週間」の範囲(2025年10月5日〜10月12日)に絞り込みながら、AIスタートアップ名、調達額、投資家、資金使途、および発表日を詳細にメモします。,もし直接的な資金調達ニュースが見つからない場合は、ここ一週間で言及された日本のAIスタートアップに関する他の重要な動向や注目記事がないかを確認します。
<step>1</step>
<url>about:blank</url>
<title>Starting agent 82f0...</title>
<thoughts><thinking>The...
🏷 資金フロー分析:集中化・中東マネー・VC配分の構造変化
タクラマカン砂漠数学科
エージェント型AIの次は何?: 生成AIは幻滅期、AIエージェントは「過度な期待」のピーク ガートナー「未来志向型インフラテクノロジーのハイプ・サイクル ...
Chip Industry Startup Funding: Q3 2025
Funds will be used to accelerate mass production of its LLM accelerator card. ... Funds will support the launch of its next-gen system later this year and efforts ...
Applying Cognitive Design Patterns to General LLM Agents
Step-wise reflection is intended to improve overall reliability of LLM responses. The simplest versions of step-wise reflection prompt the language model to ...
AI Agents with Reflection: Outperform Top LLMs in ...
Reflection is a design pattern where AI agents evaluate their own output (or that of other agents), assessing strengths and weaknesses.
Reflection Tuning Explained: Self-Improving LLMs 101 | Galileo
Reflection tuning teaches AI models to critique and rewrite their own responses before delivering them to users. The technique promises better accuracy—models ...
External Redirection
Redirecting you to external site in 3 seconds : https://lnkd.in/gFNzWSHV
If you are not automatical...
External Redirection
Redirecting you to external site in 3 seconds : https://lnkd.in/dYhnQZMh
If you are not automatical...
External Redirection
Redirecting you to external site in 3 seconds : https://lnkd.in/g6-twBgb
If you are not automatical...
承认自己开源不行?转型“美国DeepSeek”后,两个谷歌研究员的AI初创公司融到20亿美元,估值暴涨15倍!
AI 创业公司 Reflection AI 由两位前 Google DeepMind 研究员在去年创立,仅仅一年时间就完成了最新一轮融资——筹集了 20 亿美元,公司估值达到 80 亿美元,比 7 个...
The 10 Hottest AI Startup Companies Of 2025 (So Far)
[AI](https://www.crn.com/news/ai)
# The 10 Hottest AI Startup Companies Of 2025 (So Far)
[Mark Har...
🏷 インパクトと示唆:投資家・創業者が取るべき戦術とリスク対策
スタートアップ一覧|STARTUP DB(スタートアップデータベース)
#### STARTUP DBの概要
「STARTUP DB(スタートアップデータベース)」は、スタートアップ企業のリサーチを支援するサービスです。このサービスは、企業の事業創造を検討する方向けの有料プラン「ENTERPRISE」と、一部機能を無料で利用できる無料会員制度を提供しています。これにより、スタートアップに関する広範な情報を効率的に収集し、活用できる基盤を整えています。
#### 有料プラン「ENTERPRISE」の機能
有料プラン「ENTERPRISE」は、スタートアップとの事業創造を目指す企業様向けに設計されています。会員限定の機能を活用することで、より効率的なリサーチが可能です。主な機能には、以下の点が挙げられます。
* **詳細な検索機能**: すべての検索機能(ソート、フィルタ、複数タグ指定)が利用でき、目的のスタートアップを迅速に見つけられます。
* **無制限データダウンロード**: 必要なデータを制限なくダウンロードし、分析に役立てることができます。
* **専門家によるサポート**: スタートアップに特化した専門家が、企業のリストアップや面談調整をサポートし、具体的なアクションへと繋げます。
このプランは、スタートアップとの連携を深めたい企業にとって、非常に強力なツールとなるでしょう。
#### 無料会員機能
無料会員として登録することで、いくつかの便利な機能を利用できます。
* **最新の資金調達情報の閲覧**: 最新の資金調達に関する情報を確認し、市場の動向を把握できます。
* **フォロー機能の利用**: 関心のあるスタートアップをフォローし、最新の動きを追いかけることができます。
* **コミュニティイベントへの招待**: STARTUP DBが主催するコミュニティイベントに招待され、他の参加者との交流の機会を得られます。
* **セミナー動画視聴**: スタートアップに関するセミナー動画を視聴し、知識を深めることができます。
無料会員でも、スタートアップに関する基本的な情報を得て、サービスの一部を体験できるのが魅力です。
https://digitalpr.jp/release/r_source.xml
2025年10月5日〜10月12日週:大学の教育・研究とAI・DXの進展、新製品・サービス、万博関連イベントの最新動向
#### 大学の教育・研究・連携・イベントの最新情報
**東京工芸大学:AIとメディア芸術シンポジウム開催**
東京工芸大学大学院芸術学研究科メディア芸術研究センターは、2025年10月18日(土)に中野キャンパスで「AIとメディア芸術」をテーマにしたシンポジウムを無料開催します。生成AI活用が日常化した現代におけるAIとメディア芸術の未来について、メディア芸術の最前線で活躍するゲスト2名と久原泰雄教授が語り合います。オンライン参加も可能です。[https://digitalpr.jp/r/120013](https://digitalpr.jp/r/120013)

**武庫川女子大学:看護学部開設10周年記念シンポジウム開催**
武庫川女子大学看護学部・大学院看護学研究科は、2025年9月20日に開設10周年記念シンポジウム「多様性社会における生活者と看護」を開催しました。フリーアナウンサー清水健氏の講演や、初代学部長の阿曽洋子名誉教授が「360°看護力」について語るなど、500名以上が参加しました。2027年4月には共学化し、男性看護師の養成も開始予定です。[https://digitalpr.jp/r/120012](https://digitalpr.jp/r/120012)


**関西大学:大阪・関西万博「サウジアラビア館」サンゴ構造物寄贈と海洋再生研究の始動**
関西大学は、2025年大阪・関西万博サウジアラビア館から3Dプリント製サンゴ構造物約100体と3Dプリンター装置の寄贈を受け、海洋再生分野での国際共同研究を開始します。関大発ベンチャー(株)イノカの「環境移送技術®」と上田正人教授の「サンゴポリープ定着技術」を融合させ、持続可能な海洋再生研究の新たなステージを切り拓きます。[https://digitalpr.jp/r/120010](https://digitalpr.jp/r/120010)

**関西大学:大阪・関西万博閉幕日イタリア館で「ワールド・イタリア・スポーツデー」開催**
関西大学は、2025年10月13日(月・祝)の大阪・関西万博閉幕日にイタリア館でクロージングセレモニー「ワールド・イタリア・スポーツデー」に参画します。特設スケートリンクでの聖火トーチ引き継ぎ式では、関大アイススケート部員が演技を披露し、校友の宮原知子氏や和田伸也氏も登壇します。[https://digitalpr.jp/r/120008](https://digitalpr.jp/r/120008)

**近畿大学:「マグロの日」に「近大マグロ」特別メニューを学食で限定販売**
近畿大学は、2025年10月10日(金)の「マグロの日」に、東大阪キャンパスの学内食堂で「近大マグロの握り寿司ときつねうどんのセット」と「近大マグロ丼」を学生向けに500円(税込)で限定販売します。[https://digitalpr.jp/r/120007](https://digitalpr.jp/r/120007)

**近畿大学:大学祭「柏の森祭2025『虹』」開催、「水曜日のカンパネラ」スペシャルライブも**
近畿大学産業理工学部は、2025年10月18日(土)に大学祭「柏の森祭2025『虹』」を福岡キャンパスで開催します。「水曜日のカンパネラ」による観覧無料のスペシャルライブが行われるほか、学生や企業の模擬店など、多様なプログラムが用意されており、一般の方も参加できます。[https://digitalpr.jp/r/120005](https://digitalpr.jp/r/120005)

**近畿大学:創立100周年記念特別企画「東京藝術大学学長 日比野克彦氏による講演会」**
近畿大学文芸学部芸術学科造形芸術専攻は、2025年10月14日(火)に東大阪キャンパスで東京藝術大学学長の日比野克彦氏を招き、「アートの種まき ~さらなる100年を目指して~」をテーマに講演会を実施します。芸術が未来に果たす役割や意義について語り、新たな文化の芽を育む一歩となります。[https://digitalpr.jp/r/120004](https://digitalpr.jp/r/120004)

**近畿大学:医学部・病院「おおさかメディカルキャンパス」オープニング記念式典開催**
近畿大学は、2025年10月19日(日)に堺市泉ケ丘駅前に開設する「近畿大学おおさかメディカルキャンパス」のオープニング記念式典を開催します。近大マグロの解体ショーやスペシャルステージが披露されるほか、10月20日・21日には地域住民向け内覧会も実施されます。[https://digitalpr.jp/r/120003](https://digitalpr.jp/r/120003)

**ヤマザキ動物看護大学・大学院:在校生と卒業生が日本動物看護学会・日本臨床獣医学フォーラムで活躍**
ヤマザキ動物看護大学・大学院の在校生と卒業生が、主要な動物看護学会で顕著な成果を上げました。日本動物看護学会第34回大会では齋藤めぐみ助教がポスター発表で優秀賞を、日本臨床獣医学フォーラム第27回年次大会2025では友野悠助教の指導のもと、学生3名がポスターセッション研究部門最優秀賞を受賞しました。[https://digitalpr.jp/r/120002](https://digitalpr.jp/r/120002)


**帝京平成大学:新球場「THU BALL PARK」が完成、11月16日に竣工式・オープニングイベント**
帝京平成大学千葉キャンパスに野球場「THU BALL PARK」が完成し、2025年11月16日(日)に竣工式およびオープニングイベントを開催します。元プロ野球選手を招いた小学生対象の野球クリニックも実施されます。[https://digitalpr.jp/r/120001](https://digitalpr.jp/r/120001)


**神田外語大学:神田佐野文庫常設展「西周、英学の開拓者」開催**
神田外語大学附属図書館は、2025年9月19日(金)から2026年7月31日(金)まで、第4回神田佐野文庫常設展示「西周、英学の開拓者」を開催しています。幕末から明治にかけて活躍した啓蒙思想家・西周に焦点を当て、蘭学から英学への移行期の貴重資料9点の複製を紹介します。[https://digitalpr.jp/r/120000](https://digitalpr.jp/r/120000)


**東京都立大学:「東京都立大学プレミアム・カレッジ」令和8年度入学募集開始**
東京都立大学は、50歳以上の方を対象とした「生涯学べる100歳大学」である「東京都立大学プレミアム・カレッジ」の令和8年度(2026年度)入学(本科)募集を開始しました。最長4年間学び続けられ、専任教授陣によるオンラインイベントも無料配信されます。[https://digitalpr.jp/r/119964](https://digitalpr.jp/r/119964)
**日本大学:光合成生物の分裂に新たな仕組みを発見**
日本大学の金恩哲助教とドイツ・ダルムシュタット工科大学のMarcel Dann助教授を中心とした国際共同研究チームは、光合成生物の細胞や葉緑体の分裂制御において、チラコイド膜形成に関わるCurT/CURT1タンパク質が分裂を協調させる新たな役割を持つことを発見しました。この成果は食料増産やバイオマスエネルギー生産の効率化への応用が期待されます。[https://digitalpr.jp/r/119963](https://digitalpr.jp/r/119963)
**同志社女子大学:公開講座アドルフ・プラ ピアノリサイタルを開催**
同志社女子大学音楽学科は、2025年10月22日(水)に世界的ピアニスト兼音楽学者アドルフ・プラ氏を迎え、公開講座としてピアノリサイタルを開催します。モンポウ作品の魅力を深く味わえる貴重な機会です。[https://digitalpr.jp/r/119962](https://digitalpr.jp/r/119962)

**産業能率大学:学生発案の秋季限定ランチメニューがカフェに登場**
産業能率大学経営学部の倉田洋ゼミと田中彰夫ゼミは、株式会社ラムラとの産学連携プロジェクトで、学生プロデュースの秋季限定ランチメニューを「common cafe 新宿東口店」で2025年10月16日より販売開始します。[https://digitalpr.jp/r/119961](https://digitalpr.jp/r/119961)

**獨協大学:図書館学生サポーターBiVSが選書とPOPを紀伊國屋書店新宿本店に展示**
獨協大学図書館学生サポーターBiVS(ビボス)の学生9名が選んだ本と紹介POPが、2025年10月20日(月)から11月3日(月)まで紀伊國屋書店新宿本店3階のアカデミック・ラウンジに展示されます。[https://digitalpr.jp/r/119960](https://digitalpr.jp/r/119960)
**京都橘大学:生命健康科学研究センター講演会開催、共同研究の創出目指す**
京都橘大学は、2025年10月18日(土)にキャンパスプラザ京都で生命健康科学研究センター講演会を開催し、先進的な研究成果を共有し共同研究創出を目指します。北里大学名誉教授佐藤之俊氏による「肺がんの臨床:診断と治療」に関する講演も行われます。[https://digitalpr.jp/r/119959](https://digitalpr.jp/r/119959)

**法政大学:市ケ谷キャンパス前の区道の通称名が「法大通り」に決定**
2025年8月、法政大学市ケ谷キャンパス前を通る区道の通称名が「法大通り(ほうだいどおり)」に決定しました。大学が地域に根ざした活動を続けてきた実績が背景にあります。[https://digitalpr.jp/r/119958](https://digitalpr.jp/r/119958)

**創価大学:全国学生調査ポジティブリストで全学部が複数項目で上位ランクイン**
創価大学は、文部科学省の2024年度「全国学生調査(第4回試行実施)」ポジティブリストにおいて、全学部が複数の項目で全国上位にランクインしました。国際教養学部は海外留学・英語授業・外国語を使う力で全国1位を獲得するなど、本学の「建学の精神」に基づく教育が高く評価されています。[https://digitalpr.jp/r/119957](https://digitalpr.jp/r/119957)
**東京情報大学:公開講座「距離画像センサによるインタラクティブゲームの開発と体験」開催**
東京情報大学は、2025年11月2日(日)に公開講座「距離画像センサによるインタラクティブゲームの開発と体験」を無料開催します。距離画像センサを応用したインタラクティブゲームの体験を通じて科学の面白さを紹介します。[https://digitalpr.jp/r/119558](https://digitalpr.jp/r/119558)

**東京工芸大学:学生とスウェーデンの学生による共同写真展を開催**
東京工芸大学芸術学部写真学科大和田良准教授のゼミ学生とスウェーデン写真学校Fotoskolan STHLMの学生による共同写真展が、2025年10月21日(火)~11月8日(土)の期間、中野キャンパスの2つの会場で開催されます。[https://digitalpr.jp/r/119912](https://digitalpr.jp/r/119912)

**鎌倉女子大学:農林水産省「官民連携食育プラットフォーム」に加盟**
鎌倉女子大学は、農林水産省「官民連携食育プラットフォーム」に正式に加盟しました。食育を未病対策の柱と位置付け、産学官連携を強力に推進して食育を通した健康づくりに貢献します。[https://digitalpr.jp/r/119904](https://digitalpr.jp/r/119904)

**甲南女子大学とフリュー株式会社:産学連携プロジェクト後期も展開**
甲南女子大学人間科学部文化社会学科の池田ゼミは、フリュー株式会社と連携した産学連携プロジェクトを後期も展開し、「メディアと消費」を中心とした女性のライフスタイル研究を行います。[https://digitalpr.jp/r/119903](https://digitalpr.jp/r/119903)
**追手門学院大学法学部:高槻市の濱田剛史市長による講演会開催**
追手門学院大学法学部は、2025年10月14日(火)に高槻市の濱田剛史市長を招き講演会を開催します。法学を生かしたキャリアと自治体行政の現場から学ぶ機会を学生に提供します。[https://digitalpr.jp/r/119902](https://digitalpr.jp/r/119902)

**京都産業大学と麗澤瑞浪高校:アントレプレナーシップ教育で高大接続連携協定締結**
京都産業大学と麗澤瑞浪高等学校は、2025年10月7日、「アントレプレナーシップ教育に関する連携協定」を締結しました。社会課題の解決や新産業創出に挑戦する人材育成を目指し、高校3年間の「探究・挑戦」と大学4年間の「事業創造」を有機的に接続します。[https://digitalpr.jp/r/119901](https://digitalpr.jp/r/119901)

**清泉女子大学:全国学生調査ポジティブリストで複数項目が全国上位にランクイン**
清泉女子大学は、2025年9月30日に公表された文部科学省の「全国学生調査(第4回試行実施)」ポジティブリストにおいて、文学部が複数の項目で全国上位にランクインしました。清泉大学の人間学部および看護学部も高評価を得ています。[https://digitalpr.jp/r/119900](https://digitalpr.jp/r/119900)
**中部大学:住血吸虫媒介貝のゲノム編集に世界で初めて成功**
中部大学先端研究センターの黒田玲子卓越教授らは、ヒトや齧歯類に寄生するマンソン住血吸虫の中間宿主貝のゲノム編集に世界で初めて成功しました。この技術確立により、住血吸虫症克服への新たな道を拓くものとして医学・公衆衛生への応用が期待されています。[https://digitalpr.jp/r/119854](https://digitalpr.jp/r/119854)
**神戸女学院:創立150周年記念式典を10月12日に挙行**
学校法人神戸女学院は、創立150周年を迎える2025年10月12日(日)に記念式典を挙行します。内田樹名誉教授による記念講演や、音楽学部による記念演奏(世界初演)が行われるほか、新棟建設や奨学金創設など各種記念事業も実施されています。[https://digitalpr.jp/r/119853](https://digitalpr.jp/r/119853)

**日本女子大学:2028年4月に文理融合の「人間科学部(仮称)」開設構想を発表**
日本女子大学は、2028年4月に「人間科学部(仮称)」の開設を構想しています。現在の「人間社会学部心理学科」と「家政学部児童学科」を前身とする1学部2学科で、文理融合的な視点から人間を科学的に研究し、「人間とは何か」という根源的な問いに挑みます。[https://digitalpr.jp/r/119852](https://digitalpr.jp/r/119852)

**甲南女子大学とワコール:産学連携プロジェクト後期も展開**
甲南女子大学人間科学部文化社会学科の米澤泉教授ゼミは、株式会社ワコールと連携した産学連携プロジェクトを後期も展開し、「流行にとらわれない」新たな定番品の考案を目指します。学生ならではの視点と流行調査を活かし、商品デザインの提案を行います。[https://digitalpr.jp/r/119851](https://digitalpr.jp/r/119851)

**産業能率大学:小学生対象のビーチバレーボール大会「SANNO CUP」を開催**
産業能率大学情報マネジメント学部のコース横断プロジェクト科目「イベントプロデュース」は、2025年10月11日(土)に小学生対象のビーチバレーボール大会「SANNO CUP」を開催します。ビーチバレーボール競技の普及を目指し、将来的には全国大会への発展を見据えています。[https://digitalpr.jp/r/119850](https://digitalpr.jp/r/119850)

**獨協大学:図書館講演会「文学と装丁の楽しい関係」開催**
獨協大学は、2025年11月12日(水)に第9回図書館講演会「文学と装丁の楽しい関係ー装丁と装画の醍醐味ー」を独協大学図書館で開催します。美術ジャーナリストの小林真理氏を講師に招き、日本の美しい書物史を紹介します。[https://digitalpr.jp/r/119849](https://digitalpr.jp/r/119849)
**成蹊大学:オムニバス講義「ドイツの技術イノベーション:日本との比較(仮題)」を一般公開**
成蹊大学は、2025年10月14日(火)にオムニバス講義「共生社会トピックス」内で、ドイツ学術交流会東京事務所長のアクセル・カーペンシュタイン氏による講演「ドイツの技術イノベーション:日本との比較(仮題)」を一般公開します。[https://digitalpr.jp/r/119848](https://digitalpr.jp/r/119848)

**ファインセラミックスセンターと芝浦工業大学:マテリアルズインフォマティクスにより巨大誘電率材料の合成に成功**
一般財団法人ファインセラミックスセンターと芝浦工業大学は、第一原理計算とマテリアルズインフォマティクスを駆使し、準安定なペロブスカイト型RbNbO₃の合成に世界で初めて成功しました。これにより、積層セラミックスコンデンサ(MLCC)の新材料開発に道を拓く可能性が示唆されます。[https://digitalpr.jp/r/119847](https://digitalpr.jp/r/119847)

**摂南大学:開学50周年記念国際シンポジウム「アジアにおける持続可能な地域経済開発に向けて」開催**
摂南大学は、2025年10月29日(水)に開学50周年記念国際シンポジウム「アジアにおける持続可能な地域経済開発に向けて」を無料開催します。アジア各国の持続可能な地域経済開発の必要性をテーマに、国内外のリーダーや専門家が知見と実践事例を共有・議論します。[https://digitalpr.jp/r/119846](https://digitalpr.jp/r/119846)

**佛教大学:「起業家リアルトーク」を開催、起業体験を進路選択のヒントに**
佛教大学社会連携センターは、2025年10月9日(木)から22日(水)にかけて計5回「起業家リアルトーク」を開催します。在学生や卒業生を含む起業家が自身の体験を語り、学生の進路選択や将来像を考える機会を提供します。[https://digitalpr.jp/r/119845](https://digitalpr.jp/r/119845)

**佛教大学:「第17回 佛教大学原爆展 ― 被爆80年記念講演と展示 ―」を開催**
佛教大学は、被爆80年を機に平和への学びを深める「第17回 佛教大学原爆展 ― 被爆80年記念講演と展示 ―」を2025年10月17日(金)・18日(土)に開催します。被爆者花垣ルミ氏の講演や学生制作の原爆模型などを通じて平和について考えます。[https://digitalpr.jp/r/119844](https://digitalpr.jp/r/119844)

**金沢工業大学:「【親子で実験】隠されたフルーツの力~高峰譲吉と酵素の世界~」を10月12日に開催**
金沢工業大学は、2025年10月12日(日)に金沢学生のまち市民交流館で「【親子で実験】隠されたフルーツの力~高峰譲吉と酵素の世界~」を開催します。フルーツに含まれる消化酵素の観察や高峰譲吉博士の功績を紹介し、親子で楽しみながら科学への関心を深めます。[https://digitalpr.jp/r/119843](https://digitalpr.jp/r/119843)

**東洋大学:SDGsシンポジウム『未来を拓く研究力―研究成果の社会実装を通じたSDGsへの貢献―』を11月1日に開催**
東洋大学は、2025年11月1日(土)にSDGsシンポジウム『未来を拓く研究力―研究成果の社会実装を通じたSDGsへの貢献―』を白山キャンパスで開催します。研究成果の社会実装に取り組む3つの研究プロジェクトを事例に、研究活動によるSDGsへの貢献を考えます。基調講演には日本総研の村上芽氏を招きます。[https://digitalpr.jp/r/119842](https://digitalpr.jp/r/119842)

**昭和女子大学キャリアカレッジ:ダイバーシティ推進セミナー「AI時代の自分らしいキャリア形成」を11月5日に開催**
昭和女子大学キャリアカレッジは、2025年11月5日(水)にオンラインでダイバーシティ推進セミナー「AI時代の自分らしいキャリア形成ーSNSとビジネスに活かせる自己ブランディングー」を無料開催します。LinkedIn日本代表の田中若菜氏が登壇し、自己ブランディングの実践的ヒントやネットワーク活用の最前線を紹介します。[https://digitalpr.jp/r/119841](https://digitalpr.jp/r/119841)

**青山学院大学:2027年4月、青山キャンパスに「統計データサイエンス学環(仮称)」設置構想を発表**
青山学院大学は、2027年4月に青山キャンパスに「統計データサイエンス学環(仮称)」の設置を構想しています。本学環は、同大学初の青山キャンパスに設置される理系の学士課程であり、既存5学部との連係により、数理や情報技術にとどまらない広い学問的視座を得る新しい教育プログラムを提供します。[https://digitalpr.jp/r/119840](https://digitalpr.jp/r/119840)

**神田外語大学とJR東日本クロスステーション:NewDaysで「世界を味わうおにぎり」を期間限定発売!**
神田外語大学の学生たちは、JR東日本クロスステーションNewDaysと連携し、「世界を味わうおにぎり」をコンセプトにオリジナルおにぎり3種類を企画・開発しました。シーフードパエリア風おにぎり、ナシゴレン風おにぎり、スゴおにビビンバ風おにぎりの3品は、2025年10月14日(火)からJR東日本エリアのNewDaysで期間限定販売されます。[https://digitalpr.jp/r/119839](https://digitalpr.jp/r/119839)

#### AI・DX・先進テクノロジーの進展
**近畿大学中央図書館:アバターによる受付窓口対応を開始しDX推進**
近畿大学中央図書館は、2025年10月14日(火)からアバター技術を活用した受付窓口でのレファレンスサービスを開始します。利用者の利便性向上、図書館業務の効率化、および図書館員の働き方改革を図り、将来的にはAI技術を活用した24時間対応も視野に入れています。[https://digitalpr.jp/r/120006](https://digitalpr.jp/r/120006)

**レブコム:Gartner® IT Symposium/Xpo™ 2025 にPlatinum出展**
株式会社RevCommは、2025年10月28日(火)~30日(木)に開催される「Gartner IT Symposium/Xpo™ 2025」にPlatinum出展社として参加します。セッションでは「RevCommが拓く次世代AI戦略:生成AIによる音声ビッグデータの価値創造と営業・顧客体験の再発明」と題し、音声AI活用の可能性について講演します。[https://digitalpr.jp/r/119907](https://digitalpr.jp/r/119907)

**住友電工情報システム:エンタープライズサーチQuickSolution®がITRの検索・探索エンジン市場調査で8年連続シェア1位を獲得**
住友電工情報システム株式会社のRAG(検索拡張生成)対応エンタープライズサーチ「QuickSolution®」が、株式会社アイ・ティ・アールが発行する市場調査レポート「ITR Market View:生成AI/機械学習プラットフォーム市場2025」の検索・探索エンジン市場において、ベンダー別売上金額シェア1位を8年連続で獲得しました。生成AI連携(RAG)機能により、社内情報に対して質問応答も可能です。[https://digitalpr.jp/r/119549](https://digitalpr.jp/r/119549)

**リコー:推論性能強化によりGPT-5と同等の高性能な日本語大規模言語モデル(LLM)を開発**
株式会社リコーは、リーズニング(推論)性能の追加搭載によって、当社が開発・提供するオンプレミス導入可能な700億パラメータの日本語大規模言語モデル(LLM)の性能を向上させました。「金融業務特化型LLM」では、ベンチマーク評価で米OpenAIのGPT-5をはじめとする最先端モデルと同等レベルの性能を確認しました。[https://digitalpr.jp/r/119915](https://digitalpr.jp/r/119915)

**東芝エネルギーシステムズ:インドの165カ所の発電所を対象にEtaPRO™を活用したDXソリューションの契約を締結**
東芝エネルギーシステムズ株式会社のインド現地法人である東芝ジェイエスダブリュー・パワーシステム社は、インド火力発電公社(NTPC)と、165カ所の発電所を対象とした統合集中監視システムの納入契約を締結しました。当社のプラント監視ソフトウェア「EtaPRO™」を活用し、AIでリアルタイム解析することで、発電所の運営効率向上と電力安定供給に貢献します。[https://digitalpr.jp/r/119567](https://digitalpr.jp/r/119567)

**ウェブ解析士協会:AIエージェント「Genspark」最新機能と活用方法を紹介する無料オンラインセミナーを11月5日に開催**
一般社団法人ウェブ解析士協会は、AIエージェント「Genspark」の最新機能と活用方法を紹介する無料オンラインセミナーを2025年11月5日(水)に開催します。MainFunc社が開発した「Genspark」は、テキスト・画像・スライド・動画生成に加え、動画編集や議事録作成も可能なAI検索エンジンです。[https://digitalpr.jp/r/119866](https://digitalpr.jp/r/119866)

#### 新製品・サービス・ビジネス戦略の発表
**関西大学商学部飴野ゼミ×オクムラ:産学連携スリッパ「POKATTOyori」クラウドファンディング先行販売**
株式会社オクムラは、関西大学商学部飴野ゼミとの産学連携プロジェクトから誕生した新スリッパ「POKATTOyori」を、2025年10月10日(金)よりクラウドファンディングサイト「Makuake」にて先行販売します。オールシーズン対応の快適な履き心地を実現した「POKATTOyori」は、若者にスリッパの良さを広げることを目指しています。[https://digitalpr.jp/r/119975](https://digitalpr.jp/r/119975)

**アニメ「ジョジョの奇妙な冒険 スターダストクルセイダース」×TIGORAコラボレーションアイテム発売**
株式会社アルペンは、プライベートブランドTIGORAより、TVアニメ「ジョジョの奇妙な冒険 スターダストクルセイダース」とのコラボレーションアイテムを2025年10月10日9:00より販売開始します。半袖Tシャツ、長袖Tシャツ、ウインドジャケット、マルチポケットショートパンツなど全8アイテムが展開されます。[https://digitalpr.jp/r/119939](https://digitalpr.jp/r/119939)

**キル フェ ボン:11月11日のチーズの日に合わせて「Cheese Day」開催**
タルト専門店「キル フェ ボン」は、2025年11月7日(金)~11月11日(火)の5日間、全12店舗で「Cheese Day」を開催します。5種類の彩り豊かなチーズタルトが勢揃いし、味覚、香り、見た目すべてでチーズの魅力を楽しめます。[https://digitalpr.jp/r/119966](https://digitalpr.jp/r/119966)

**ブリヂストンのディスクロージャー優良企業選定:自動車・同部品・タイヤ部門で4年連続第1位**
株式会社ブリヂストンは、日本証券アナリスト協会が実施する2025年度「証券アナリストによるディスクロージャー優良企業選定」の自動車・同部品・タイヤ部門において、4年連続で第1位に選定されました。経営陣のIR姿勢や情報開示の充実などが高く評価されています。[https://digitalpr.jp/r/119746](https://digitalpr.jp/r/119746)
**日本板硝子:国内建築用板ガラス製品の価格改定を発表**
日本板硝子株式会社は、2026年1月1日出荷分より、国内の建築用板ガラス製品の価格を10~25%、鏡製品を20~25%、建築用機能ガラス製品を15~20%引き上げると発表しました。コスト上昇やカーボンニュートラル実現に向けた環境対策が背景にあります。[https://digitalpr.jp/r/119719](https://digitalpr.jp/r/119719)
**デロイト トーマツ グループ:新会社名称「合同会社デロイト トーマツ」を発表**
デロイト トーマツ グループは、2025年12月1日付合併により新会社名称を「合同会社デロイト トーマツ」と発表しました。複数専門分野の統合モデル(MDM)を通じてクライアントの経営課題に卓越した価値を提供し、未来に向けた挑戦を続けます。[https://digitalpr.jp/r/119906](https://digitalpr.jp/r/119906)
**JR東海リテイリング・プラス:懐かしの新幹線0系サボ「レプリカサボ」新作3種が登場**
株式会社JR東海リテイリング・プラスは、0系新幹線で使用された行先標を再現した「レプリカサボ」に、新たに「ひかり2号」「こだま201号」「座席種別」の3種類を追加し、2025年10月17日(金)に新発売します。クリアファイルも同時発売されます。[https://digitalpr.jp/r/119749](https://digitalpr.jp/r/119749)


**ダイキン工業:「大ぴちょんくん」×UNIQLO UMEDAのコラボ企画、オリジナルTシャツ・トートバッグを発売**
ダイキン工業株式会社は、2025年10月24日(金)より「UNIQLO UMEDA」と「大ぴちょんくん」の店舗限定コラボレーションを実施します。『UTme!』でオリジナルTシャツやトートバッグ、リメイクサービスでオリジナル刺繍が展開され、幅広い世代にダイキンや空気への興味を持ってもらうことを目指します。[https://digitalpr.jp/r/117296](https://digitalpr.jp/r/117296)

**シュローダー:ハイブリッドアプローチによりクレジット市場での投資機会を発掘**
シュローダーは、クレジット市場での投資において、膨大な計算能力を活用する「システマティック」投資とファンダメンタルズ分析を組み合わせた「ハイブリッドアプローチ」が、追加的なリターンを得る機会を提供すると提唱しています。このアプローチにより、非効率な市場からリターンを創出し、頑健なリスク管理フレームワークを構築します。[https://digitalpr.jp/r/119891](https://digitalpr.jp/r/119891)

**レバンテより洗練されたデザインと機能性を両立した高機能防水スプレー「Sereniq -セレニック-」新登場**
レバンテ株式会社は、2025年10月11日(土)より、シンプルで洗練されたデザインと、最短5分で乾く速乾性、強力な撥水・撥油性能を両立した高機能防水スプレー「セレニックウォータープルーフスプレー」(2,750円税込)をオンライン販売開始します。[https://digitalpr.jp/r/119896](https://digitalpr.jp/r/119896)

**マース ジャパン:保護犬・保護猫の支援活動「マース グローバル アドプション ウィークエンド」を展開**
マース ジャパン リミテッドは、世界規模の「マース グローバル アドプション ウィークエンド」(10月3日~5日)に合わせ、日本でも保護犬・保護猫をサポートする取り組みを実施しました。シェルターでのボランティア活動やキャットフード「カルカン®」の寄付などを行いました。[https://digitalpr.jp/r/119886](https://digitalpr.jp/r/119886)

**freee:コクヨが新エンジニア組織立ち上げでfreee工数管理を導入開始、管理工数わずか5分を実現**
フリー株式会社は、コクヨ株式会社がエンジニア内製化に向けた新組織立ち上げにおいて、freee工数管理の導入を開始したことを発表しました。「導入支援時間ゼロ」で、Googleカレンダー連携や工数不足自動埋め機能が開発メンバーの負担を軽減し、管理者側の月末締め作業もわずか5分で完了するなど、高い業務効率化を実現しています。[https://digitalpr.jp/r/119873](https://digitalpr.jp/r/119873)

**赤ちゃん本舗&森永乳業共同企画:「子育てあるある川柳」入賞作品発表、「赤ちゃんの日」に笑顔届ける**
株式会社赤ちゃん本舗と森永乳業株式会社は、共同企画「子育てあるある川柳2025」の入賞作品10句を発表しました。10月10日の「赤ちゃんの日」に合わせ、「子育てあるある」をテーマに川柳を募集し、大賞には「よちよちと 家を旅する 冒険家」が選ばれました。[https://digitalpr.jp/r/119861](https://digitalpr.jp/r/119861)

**RevComm:音声解析AI「MiiTel」累計通話・会議時間が700万時間を突破、企業価値向上の基盤に**
株式会社RevCommが提供する音声解析AI「MiiTel」に蓄積された累計通話・会議時間が700万時間を突破し、音声のビッグデータ化がさらに加速しています。この膨大なデータを活用して、営業活動の生産性向上だけでなく、顧客理解、市場理解、製品開発、さらには経営判断に役立てることができます。[https://digitalpr.jp/r/119832](https://digitalpr.jp/r/119832)

**第一興商:DAM 2025年夏アニメ主題歌カラオケランキングTOP50発表、「ダンダダン」第2期OPが1位**
株式会社第一興商は、DAMにおける2025年夏クール放送・配信のアニメ主題歌カラオケランキング調査結果を発表しました。1位は『ダンダダン』第2期オープニングテーマのアイナ・ジ・エンド「革命道中」でした。[https://digitalpr.jp/r/119761](https://digitalpr.jp/r/119761)

**BASF:アジア太平洋地域で初となるバイオマスバランスの3-(ジメチルアミノ)プロピルアミンをGalaxy Surfactantsに納入**
BASFは、バイオマスバランスのBMBCert™ 3-(ジメチルアミノ)プロピルアミン(DMAPA)のアジア太平洋地域における初出荷分を、Galaxy Surfactants Ltd.に納入しました。Galaxy Surfactantsは、このBMBCert™ DMAPAを用いてパーソナルケア用途の製品を製造し、CO₂排出量の削減を目指します。[https://digitalpr.jp/r/119718](https://digitalpr.jp/r/119718)

**京王百貨店新宿店:「SHINJUKU OUTLET FASHION SALE」を初開催、有名ブランドの秋冬アイテム5万点以上**
京王百貨店新宿店は、2025年10月23日(木)~28日(火)の期間、7階大催場で「SHINJUKU OUTLET FASHION SALE」を初開催します。全15以上の有名ブランドから、秋冬アイテム5万点以上がお得なアウトレット価格でラインアップします。[https://digitalpr.jp/r/119456](https://digitalpr.jp/r/119456)

**QVCジャパン:神田うの氏・森田敦子氏登壇「美と健康を育むフェムケアを学ぼう!」ティータイムトークショーを11月28日に開催**
株式会社QVCジャパンは、2025年11月28日(金)にホテル椿山荘東京で、モデル・ファッションデザイナーの神田うの氏と植物療法士・フェムケアの第一人者である森田敦子氏をゲストに迎え、ティータイムトークショーイベント「美と健康を育むフェムケアを学ぼう!」を開催します。女性のライフステージに寄り添うフェムケアの最新知識を解説します。[https://digitalpr.jp/r/118195](https://digitalpr.jp/r/118195)

**新潟県:首都圏及び関西圏で新潟米のPRイベントを開催、コシヒカリ・新之助の魅力を発信**
新潟県は、新米の販売が本格化する中、新潟米の購入促進と消費拡大を目指し、首都圏および関西圏で新潟米のPRイベントを開催します。ディアモール大阪や銀座・新潟情報館THE NIIGATA、レモンガススタジアム平塚などで、コシヒカリ・新之助のおにぎり食べ比べセットの販売や炊き方講座を実施します。[https://digitalpr.jp/r/119827](https://digitalpr.jp/r/119827)


**日本デザイン振興会:10月15日に「2025年度グッドデザイン賞 受賞記者発表会」開催、大賞受賞者来場**
公益財団法人日本デザイン振興会は、2025年10月15日(水)に東京ミッドタウン ホール&カンファレンスで「2025年度グッドデザイン賞 受賞記者発表会」を開催します。最高賞である「グッドデザイン大賞」の受賞者が来場し、表彰式と受賞スピーチを実施予定です。[https://digitalpr.jp/r/119399](https://digitalpr.jp/r/119399)

**アルペン:“着て、寝るだけで疲労軽減”リカバリーウェア「TIGORA SLEEP」より女性サイズも登場**
株式会社アルペンは、プライベートブランド「TIGORA(ティゴラ)」より、着用して寝るだけで疲労軽減をサポートするリカバリーウェア「TIGORA SLEEP」(一般医療機器)のレディースモデルを新たに発売します。血行促進、疲労軽減などの効果が期待され、シリーズ累計8万点販売された人気商品です。[https://digitalpr.jp/r/119920](https://digitalpr.jp/r/119920)

**日産化学:富山工場と小野田工場が環境省「自然共生サイト」に認定、生物多様性保全を推進**
日産化学株式会社は、富山工場「日産ビオパーク西本郷」と小野田工場「小野田工場ビオトープ」が、環境省により「自然共生サイト」に認定されました。30by30目標達成に向けた生物多様性保全への取り組みを推進しています。[https://digitalpr.jp/r/119923](https://digitalpr.jp/r/119923)
**ブロッコリー:「うたの☆プリンスさまっ♪」15周年記念CD「15th Anniversary CD」を2026年1月7日に発売**
株式会社ブロッコリーは、『うたの☆プリンスさまっ♪』の15周年を記念した「うたの☆プリンスさまっ♪15th Anniversary CD」を2026年1月7日に発売します。スペシャルユニット「MUSIC」「DREAM」「LOVE」によるユニット曲3曲を収録します。[https://digitalpr.jp/r/119512](https://digitalpr.jp/r/119512)

**東京慈恵会医科大学:国内外科系学会として初の「睡眠外科」に関する講演を11月20日に開催**
東京慈恵会医科大学形成外科学講座の宮脇剛司教授らは、2025年11月20日に日本頭蓋顎顔面外科学会にて、国内の外科系学会として初めて「睡眠障害に対する手術」をテーマとするシンポジウムおよび教育講演を行います。睡眠外科について広く啓発し、患者さんが適切な医療を受けられる環境整備に貢献することを目指します。[https://digitalpr.jp/r/119922](https://digitalpr.jp/r/119922)

**セブン銀行:ゲオホールディングスと「コンビニ証明書受取サービス」の提供に合意、事業会社で初導入**
株式会社セブン銀行は、株式会社ゲオホールディングスと「コンビニ証明書受取サービス」の提供に関して合意しました。ゲオグループの従業員は、2025年10月中旬頃から全国のセブン‐イレブンに設置するマルチコピー機で就労証明書などを受取可能になり、従業員の利便性向上と事業者側の事務負担軽減に繋がります。[https://digitalpr.jp/r/119513](https://digitalpr.jp/r/119513)

**乃村工藝社:「EXPO GALLERY」が「生きた建築ミュージアムフェスティバル大阪2025」に参加**
乃村工藝社は、2025年10月25日(土)、26日(日)に開催される「生きた建築ミュージアムフェスティバル大阪2025」に「EXPO GALLERY」で参加します。乃村工藝社大阪事業所内にあるEXPO GALLERYは、国際博覧会に関する貴重な資料約2万点を収蔵・展示しています。[https://digitalpr.jp/r/119870](https://digitalpr.jp/r/119870)

**牛角焼肉食堂:愛知県7店舗目「イオンモール豊川店」10月15日オープン、気軽に鉄板焼肉・焼肉丼を提供**
「牛角焼肉食堂」は、全国73店舗目、愛知県では7店舗目となる「イオンモール豊川店」を2025年10月15日(水)にオープンします。焼きたての焼肉を定食スタイルで楽しめるフードコート専門店で、「鉄板焼肉定食」や「焼肉丼」が看板メニューです。[https://digitalpr.jp/r/119878](https://digitalpr.jp/r/119878)

**アルペン:スポーツデポフラッグシップストア マークイズみなとみらい店グランドオープン特別体感イベントを開催**
株式会社アルペンは、2025年10月10日(金)に横浜市マークイズみなとみらいに「スポーツデポフラッグシップストア マークイズみなとみらい店」をグランドオープンします。10月24日(金)~11月3日(月・祝)の11日間、グランドオープン特別体感イベントを開催し、ランニングシューズ試し履き会や野球グラブ相談会などを実施します。[https://digitalpr.jp/r/119828](https://digitalpr.jp/r/119828)

**アルペン:スポーツデポ イオンモール須坂店オープンセール開催、長野県内全店で協賛セールも**
株式会社アルペンは、2025年10月10日(金)から10月20日(月)までの11日間、スポーツデポ イオンモール須坂店のグランドオープンセールを開催します。長野県内のスポーツデポ・アルペン全店で協賛セールを同時開催し、アルペングループメンバーズ限定で店内商品が15%ポイント還元となる特別企画を実施します。[https://digitalpr.jp/r/119770](https://digitalpr.jp/r/119770)

**武田薬品:新型コロナウイルス感染症リスクの“今”を知る『コロナ情報館』公開と市民公開講座開催**
武田薬品工業株式会社は、新型コロナウイルス感染症の最新情報をまとめたウェブサイト「コロナ情報館」を公開しました。サイト内では、重症化リスクを確認できる「新型コロナウイルス感染症リスクチェックシート」や、予防接種検討に役立つ「新型コロナワクチン相談カード」を提供しています。また、2025年10月26日(日)には市民公開講座「今からでも遅くない!新型コロナウイルス感染症と向き合う大切な話」をオンラインで開催します。[https://digitalpr.jp/r/119777](https://digitalpr.jp/r/119777)

**日本製鉄:日本航空株式会社機内カトラリー向け省資源ステンレス鋼「NSSC FW®2」出荷量が累計500トン突破**
日本製鉄株式会社は、日本航空株式会社(JAL)の機内カトラリー用素材として供給している省資源・高純度フェライト系ステンレス鋼「NSSC FW®2」の累計出荷数量が500トンを突破しました。NSSC FW2は、レアメタル添加量を35%削減したエコな素材で、高い耐食性と優れた光沢がJALのファーストクラスを含む全クラスで評価され採用されています。[https://digitalpr.jp/r/119833](https://digitalpr.jp/r/119833)

**川崎重工:島根県より防災ヘリコプターとして最新型ヘリコプター「H145//BK117 D-3」を受注**
川崎重工は、島根県からBK117ヘリコプターシリーズの最新型「H145//BK117 D-3」を1機受注し、2028年3月に納入予定です。消防・防災向けのD-3としては7機目の受注で、山岳地帯での安全な救助活動やスムーズな救急搬送を実現します。[https://digitalpr.jp/r/119694](https://digitalpr.jp/r/119694)

**BATジャパン:glo™のフラッグシップストア「glo™ ストア 銀座」を10月18日にオープン**
ブリティッシュ・アメリカン・タバコ・ジャパン合同会社(BATジャパン)は、加熱式たばこブランドglo™のフラッグシップストア「glo™ ストア 銀座」を2025年10月18日(土)に東京・銀座にオープンします。最新デバイス「glo™ Hilo」シリーズなどを展示・販売し、体験・購入が可能です。スタッフユニフォームは相澤陽介氏がデザインを担当しました。[https://digitalpr.jp/r/119780](https://digitalpr.jp/r/119780)

**KARRIMOR:アウトドアも日常も軽やかに動ける“octa sweat シリーズ”が登場**
英国発祥のアウトドアブランド「KARRIMOR (カリマー)」は、吸汗速乾性、軽量性、保温性、通気性など多様な機能を
スタートアップワールドカップ2025世界決勝戦: 400名超のトップクラス ...
#### スタートアップワールドカップ2025世界決勝戦の概要
スタートアップワールドカップ2025世界決勝戦は、世界最大級のスタートアップネットワークイベントとして、2025年10月15日(水)から10月17日(金)まで、サンフランシスコのヒルトン・ユニオン・スクエアで開催されます。このイベントは、世界100以上の国と地域で予選が行われ、毎年3万社以上の革新的なスタートアップ企業が参加するピッチコンテストの最高峰です。優勝企業には、100万米ドル(約1億5千万円)の投資賞金が授与されます。
#### 400名超のトップクラスVCが集結
本イベントには、アンドリーセン・ホロウィッツ、グレイロック・パートナーズ、コスラ・ベンチャーズといった世界屈指の独立系ベンチャーキャピタルや、エイチピー・テック・ベンチャーズ、アイビーエム・ベンチャーズなどのイノベーションを牽引するコーポレートベンチャーキャピタルから、総勢400名を超える一流のベンチャーキャピタリストが一堂に会します。このような規模で世界の代表的なベンチャーキャピタリストが集まる機会は国際的に見ても極めて希少であり、国内外のスタートアップにとって資金調達やネットワーキングの絶好の機会となります。また、企業の新規事業開発やオープンイノベーションを担うビジネスリーダーにとっても、グローバルな視点から実践的かつ先進的な知見を得られる貴重な場となるでしょう。イベントでは日本語同時通訳も提供されます。
![]()
#### 主要なトップクラスVCゲスト一覧
イベントには、以下の主要なVCゲストが参加します。
| 会社名 | 役職 | 名前 |
|---|---|---|
| Andreessen Horowitz | Board Partner | コニー・チェン氏 |
| Norwest | Partner | スコット・ピーチョク氏 |
| Greylock Partners | Partner | ソフィア・ルオ氏 |
| Khosla Ventures | Partner | ラジェッシュ・スワミナサン氏 |
| B Capital | General Partner | カレン・ペイジ氏 |
| Lightspeed | Partner | バハブ・グラワル氏 |
| Redpoint Ventures | Partner | メーラ・クラーク氏 |
| Tesla | Board Partner | アイラ・エーレンプレイス氏 |
| HP Tech Ventures | Partner | アンジェロ・デル・プリーオーレ氏 |
| IBM Ventures | Operating Partner | アナ・ロペス氏 |
| Amazon Web Services | Worldwide Venture Innovation Lead | イエレナ・ジョフェ・ワイル氏 |
| Deloitte | Managing Partner | タリア・アブラモウィッツ氏 |
| Intel Capital | Investment Director | アヴィ・パラドワジ氏 |
| 3M Ventures | Director and Head of Silicon Valley | チョン・ソン氏 |
| Franklin Templeton | Senior Vice President | マーガレット・キング氏 |
| Adobe | Corporate Development and Ventures | マンブリート・コーリィ |
| Samsung | Managing Director | ジョン・クォン氏 |
| Shell Ventures | Partner | ヴィカス・グプタ氏 |
| Caterpillar | Corporate Ventures | ナンシー・デクレーック氏 |
| Goldman Sachs | VC Coverage Investment Banking | マット・マーゴリン氏 |
| Marathon | Strategy and Business Development | ザック・トーブ氏 |
| Mercedes-Benz | Director, Americas M&A, Ventures and Partnerships | ホリー・クー氏 |
| Swisscom Ventures | Investment Partner | ステファン・クエント氏 |
| SK Telecom Ventures | Senior Investment Director | シェシ・アマナスドウ氏 |
| Snowflake | Director of Corporate Development | ケント・ディエップ氏 |
| CoreWeave | Vice President | ニック・フーバー氏 |
| Micron Ventures | Investment Director | ヘンリー・ファン氏 |
その他、多数のゲストが公式サイトに掲載されています。
#### イベントスケジュールと会場
* **日程**: 2025年10月15日(水) - 10月17日(金)
* **会場**: Hilton Union Square, San Francisco (333 O'Farrell St, San Francisco, CA 94102)
具体的なプログラムは以下の通りです。
* **Day 1 (10月15日(水))**: 準決勝 [https://www.startupworldcup.io/semifinals](https://www.startupworldcup.io/semifinals)
* **Day 2 (10月16日(木))**: ワークショップ [https://www.startupworldcup.io/workshops](https://www.startupworldcup.io/workshops) & CVCイノベーションセミナー [https://www.startupworldcup.io/corporateseminar](https://www.startupworldcup.io/corporateseminar)
* **Day 3 (10月17日(金))**: 世界決勝戦 [https://www.startupworldcup.io/grand-finale](https://www.startupworldcup.io/grand-finale) & ネットワーキングパーティー [https://www.startupworldcup.io/networking-party](https://www.startupworldcup.io/networking-party)
世界決勝戦のWebサイトはこちらです: [https://www.startupworldcup.io/grand-finale](https://www.startupworldcup.io/grand-finale)
チケットのお申し込みはこちらから可能です: [https://is.gd/Nl85D4](https://is.gd/Nl85D4)
スタートアップワールドカップ2025公式サイト: [https://www.startupworldcup.io/](https://www.startupworldcup.io/)
#### 日本予選と日本代表企業
日本予選は今年、九州、東京、東北の3か所で開催され、合計8,000人以上の大手企業関係者、投資家、メディアなどがスポンサーや観客として参加しました。日本予選だけに特別に1億5千万円規模の投資賞金も用意され、応募したすべてのスタートアップに資金獲得のチャンスが提供されました。世界決勝戦では、総勢約8,000名の観客が見守る中、日本予選を勝ち抜いた以下の3社が日本代表として世界へ挑戦します。
* 九州予選代表: トイメディカル株式会社 [https://toymedical.jp/](https://toymedical.jp/)
* 東京予選代表: 株式会社Acompany [https://acompany.tech/](https://acompany.tech/)
* 東北予選代表: AZUL Energy 株式会社 [https://azul-energy.co.jp/](https://azul-energy.co.jp/)
#### ペガサス・テック・ベンチャーズについて
本イベントの主催者の一つであるペガサス・テック・ベンチャーズは、米国シリコンバレーに本社を置き、世界40社以上の大手企業からLP出資を受け入れています。これまで米国、日本、東南アジアを中心に280社以上のスタートアップに投資を実施しており、日本ではマネーフォワード、メタップス、エアトリ、モンスターラボ、AI CROSSといった上場企業や、Mujin、SkyDrive、テラモーターズ、ユニファ、FiNC Technologies、ライフイズテック、WizWeなどへの投資実績があります。投資先の海外展開や事業提携、資金調達の支援も手掛けています。
ペガサス・テック・ベンチャーズの公式サイト: [https://ja.pegasustechventures.com/](https://ja.pegasustechventures.com/)
問い合わせ窓口:
ペガサス・テック・ベンチャーズ
担当:海野あやか
unno@pegasusventures.com
TEL:03-6417-4570
[https://prcdn.freetls.fastly.net/release_image/44738/156/44738-156-e5e80a94d5bc1445a37ab3fa159ebb70-2311x1641.png?width=536&quality=85%2C75&format=jpeg&auto=webp&fit=bounds&bg-color=fff](https://prcdn.freetls.fastly.net/release_image/44738/156/44738-156-e5e80a94d5bc1445a37ab3fa159ebb70-2311x1641.png?width=536&quality=85%2C75&format=jpeg&auto=webp&fit=bounds&bg-color=fff)
[https://prcdn.freetls.fastly.net/release_image/44738/156/44738-156-cf48f2cde13c6750ea4ae9e475475b36-789x765.png?width=536&quality=85%2C75&format=jpeg&auto=webp&fit=bounds&bg-color=fff](https://prcdn.freetls.fastly.net/release_image/44738/156/44738-156-cf48f2cde13c6750ea4ae9e475475b36-789x765.png?width=536&quality=85%2C75&format=jpeg&auto=webp&fit=bounds&bg-color=fff)
15 Best n8n Alternatives: Reviewed & Compared
We reviewed and compared 27 n8n alternatives to help you evaluate 2025's top 15 best n8n alternatives for your team and use case.
How I Built a Competitor Analysis AI System in n8n (No-Code)
... use (some of these are affiliate-links, thanks!): N8N: https://n8n ... AI use cases for businesses weekly.
I Built a n8n AI Agent to Automate SERP-Analysis & Competitor Analysis (Free Template)
#### n8n AIエージェントによるSERP・競合分析の自動化の概要
このコンテンツでは、ウェブサイトの新規コンテンツ作成時に時間を節約するため、SERP(検索エンジン結果ページ)分析と競合分析を自動化するn8n AIエージェントの構築方法が紹介されています。通常、手作業で行われる競合記事の構造、キーワード、エングラム分析、モバイル/デスクトップ対応、FAQの調査といったプロセスを自動化し、効率的なコンテンツ戦略立案を支援することを目的としています。
#### コンテンツ作成における課題と自動化の価値
コンテンツクリエーターは、通常、以下のような手順を手動で行います。
* フォーカスキーワードに対する競合サイトの分析
* 競合記事の構造とコンテンツの評価
* エングラム分析によるターゲットキーワードの特定
* モバイルとデスクトップ両方でのトップ記事の調査
* 関連するFAQ(よくある質問)の収集
これらの作業は時間と手間がかかりますが、n8n AIエージェントを導入することで、これらのプロセスを自動化し、質の高い記事作成に必要なデータを迅速に収集できるようになります。
#### n8nワークフローの仕組み
この自動化ワークフローは、シンプルなフォームから開始します。ユーザーはフォーカスキーワード(例: "Chat GPT Alternatives")と国(例: "Germany")を入力し、送信します。その後、以下のステップでデータが処理されます。
1. **SERP結果の取得**: SerpAPIを利用して、指定されたキーワードのSERP結果をモバイルとデスクトップの両方から取得します。
2. **記事コンテンツの取得**: Crawl for AIを使用して、SERP上位の主要な記事コンテンツをクロールします(デフォルトでは上位3件ですが、設定で変更可能)。
3. **LLMによる分析**: 取得したコンテンツはLLM(大規模言語モデル、この場合はGPT-4 Omni Mini)に渡され、SEOスペシャリストとして記事の分析、要約、潜在的なフォーカスキーワード、関連するロングテールキーワード、エングラム分析が実行されます。LLMへの入力形式としてMarkdownが推奨されており、パフォーマンス向上が期待されます。
4. **FAQの抽出**: ユーザーが検索する可能性のある関連FAQも抽出されます。
5. **結果の保存**: 分析されたデータとFAQはGoogleシートに整理して書き込まれ、コンテンツ作成者が容易に利用できるようになります。
ワークフローでは、データマージ、重複削除、APIコストを節約するためのデータ量制限など、効率的な処理のための工夫が凝らされています。
#### 分析結果と活用方法
自動化されたプロセスによってGoogleシートに出力される情報は以下の通りです。
* 記事のタイトル
* 記事へのリンク
* スニペット(短い要約)
* 潜在的なフォーカスキーワード
* エングラム分析に基づく関連キーワード(記事内で頻繁に使用されるキーワードの組み合わせ)
* 頻繁に尋ねられる質問(FAQ)とその回答源へのリンク
これらの情報は、コンテンツ作成者がSEOに強く、ユーザーの疑問に応える高品質な記事を効率的に執筆するための基盤となります。
#### コストと必要なツール
この自動化エージェントの運用コストは比較的低く抑えられています。
* **LLM利用料**: GPT-4 Omni Miniのようなコスト効率の良いモデルを使用することで、トークンコストは非常に安価です(例: 1セント)。分析するデータ量が増えるとコストは増加します。
* **SerpAPI**: 月100回の検索までは無料で利用できるプランがあり、少量利用であればコストはかかりません。
このワークフローを実行するために必要なツールは以下の通りです。
* SerpAPIアカウント
* OpenAIアカウント(またはローカルで動作するLLM)
* SERP分析とFAQ用にそれぞれシートが分けられたGoogleスプレッドシート
#### 無料テンプレートの提供
この自動化ワークフローは無料のテンプレートとして提供されており、GitHubプロファイルからダウンロードが可能です。これにより、ユーザーは動画を見ながら手動で再構築することなく、すぐにこの強力なツールを利用開始できます。提供者は今後も他の自動化に関する動画をアップロードしていく予定です。
OpenAI AgentKit vs N8N : The best AI Workflow Builder?
n8n's UI is built for connecting APIs. You drag nodes like “HTTP Request → Filter → Database Insert” and define how data moves between them. · AgentKit's Agent ...
Make the most of your professional life
Agree & Join LinkedIn
By clicking Continue, you agree to LinkedIn’s User Agreement, Privacy Policy...
External Redirection
Redirecting you to external site in 3 seconds : https://lnkd.in/gt4TWc3A
If you are not automatical...
Data-labeling startup Scale AI raises $1B as valuation doubles to $13.8B | TechCrunch
[Scale AI](https://scale.com/), which provides data-labeling services to companies that want to trai...
📖 レポートに利用されていない参考文献
検索結果: 102件追加のソース: 0件チャット: 2件
DiMORA(ディモーラ)番組表
番組表でお気に入りのテレビ番組をチェック!- テレビ番組から録画予約までできるテレビ番組サイト『DiMORA(ディモーラ)』-
bookfan - 本 - Yahoo!ショッピング
bookfanの本を取り扱い中。Yahoo!ショッピングならお買得な人気商品をランキングやクチコミからも探せます。LINEアカウント連携でPayPayポイント毎日5%(上限あり)
eラーニングコース:動作環境
【eラーニング】AI経営の最前線 ~AI活用によって生産性を向上させる経営戦略~. OS×ブラウザ:Microsoft Windows 11×Microsoft Edge・Google Chrome 音声:あり 音声の ...
https://api.syosetu.com/novelapi/api/?lim=500&st=1...
... AI学習禁止。 2025/7/30 KADOKAWA様より 書籍が発売されました! cv 井上和彦様の素敵なPR動画も! 2025/8/6 KADOKAWA様より 重版決定のお知らせを戴く事が出来 ...
#宇宙それは最後のフロンティア /usePocket.com
最終的に100万円台で宇宙に行くことを目指し金持ちだけじゃない「宇宙の民主化」を目指しているスタートアップです。 ロードマップは半年遅れだが計画は極めて順調なのでは ...
簡易化されたメニューで人件費削減!ハワイアン飲食店の効率 ...
店舗拡大の壁と資金調達の苦悩とは?#Tbalance #パーソナルトレーナー #トレーナー支援 #令和の虎 #関西版令和の虎#起業家ストーリー #稼げない悩み #挑戦者の声 #夢を ...
お知らせ | HIKE
SEEDS LINK OSAKA・KANSAI、新たに5名のアドバイザーが就任 ― 社会実装 ...
地方でSaaS導入支援会社を起業して3年、階段から降りられなくなった ...
STANDARD BOOKSTORE
孫正義の無謀な博打:SBG崩壊が日本経済を奈落へ突き落とす日|武智倫太郎
Venture Funding Roars Back in Q3, Thanks to AI's Billion- ...
Gigantic investments of $500 million dollars or more into Artificial Intelligence companies led a 38 percent increase in year-over-year third quarter global ...
ThePitchDeck: Venture capital at a crossroads
In 2024, global venture capital funding for AI start-ups reached US$131 billion (RM550 billion). If we exclude the US$40 billion for OpenAI, the creator of ...
19-Year-Old Raises 120 Million Yuan in Financing
The Series A financing of his company, Surge AI, is seeking $1 billion, and its corresponding valuation has risen to approximately $24 billion (equivalent to ...
AI2 Incubator launches $80M fund as it doubles down on ...
AI2 Incubator launches $80M fund as it doubles down on real-world AI applications in Seattle and beyond. GeekWire chronicles the Pacific Northwest startup scene ...
AI dominates billion-dollar funding rounds >> See the full ...
In 2023, it: • Attracted $67.2 billion in private AI investments (compared to China's $7.8 billion). • Produced 61 notable machine learning models, far ahead of ...
The State of AI Investing on AngelList | AngelList
India's AI Funding Paradox: Investors Show Caution But Deal ...
60 Growing AI Companies & Startups (2025)
Top 10 Biggest Investors in AI-based Startups [2025]
In 2025, AI startups attracted $192.7 billion in global funding, setting new records and accounting for over 48% of all venture capital deployed worldwide. For ...
How Vercel Hit $9.3B and Replit Hit $3B… After a Decade. The Long ...
Unicorn Startups: AI & Enterprise Tech Companies Hit Record ...
State of VC: It's all about AI now
AI Portfolio gains 8.7% less than five months since inception
Since the portfolio's inception in May this year, the AI portfolio is up 8.7%. On an annualised basis, this works out to 24.1%. As a quick refresher, two key ...
Could Buying $10000 of This Generative Artificial ...
Since its inception in 2023, the Roundhill Generative AI & Technology ETF has returned an impressive 148% compared to a 66% total return from the S&P 500.
The Roundhill Generative AI & Technology ETF Will Soar ...
A U.N. Trade and Development report forecasts that AI spending will increase by 30% annually over the next eight years. An investment in the Roundhill ...
3 Artificial Intelligence (AI) Stocks That Surged More Than ...
The worst-performing stock on this list is up 2300% versus Nvidia's nearly 1000% gain since its ChatGPT boost.
Prediction: The Roundhill Generative AI & Technology ETF ...
A U.N. Trade and Development report forecasts that AI spending will increase by 30% annually over the next eight years. An investment in the Roundhill ...
AI investments are pulling the US economy forward. Will it ...
If businesses pull back on their AI spending because they find the tools are not that helpful, it could cause major problems for the AI industry.
G2 Report Reveals AI Agents Are Delivering the Growth ...
Nearly 60% of companies now have AI agents in production. 40% of businesses have AI agent budgets of $1 million or more. Businesses report a 23% median gain ...
Is there a bubble in AI stocks? - by Sanjiv
Generative AI Cybersecurity Market Size, Share and Global Market ...
The Largest Global Capital Formation in History - AI and its ...
Seeing Double: An AI Bubble? | Richmond Fed
The AI Bubble Is a Ticking Time Bomb. If It Pops, so Will the U.S. ...
AI (Artificial Intelligence) Startups funded by ...
We unlock affordable, quick bank funding for the 30M+ small businesses in the US who would otherwise be subject to the high interest rates from predatory online ...
TirAI Inovasi 2025: AI for Indonesia's Startups
... funding drop in recent weeks. Global AI Startup Funding Highlights:- - OpenAI has attracted worldwide attention with a massive $40 billion funding round led ...
Governments are spending billions on their own 'sovereign' ...
Soket AI is one of a handful of companies attempting to build a national LLM for India with the support of India's government-funded IndiaAI Mission, which has ...
Startups debate on whether to build or buy AI solutions at ...
Large language model (LLM) startup Anthropic held its first developers' day event in Bengaluru. Accel, which is one of the investors in Anthropic, hosted ...
How Startups Spend on AI - by Stepan Ikaev
Top 10 Startup Trends (2024 & 2025)
This is both brilliant and hilarious… | Adam Bernard
Buying prestige on Product Hunt: How tech startups manufacture ...
Mega Funds, Mega Premiums – and the Looming Early-Stage ...
Corporate investors have their biggest quarter since the venture ...
The Death of Pre-Seed and Seed in AI: Why Founders Are Skipping ...
Why Every PM Needs to Understand LLMs — Module 1 — LLM ...
Top 100 AI Startup Funding & Investment Statistics [2025 ...
AI venture funding continued to surge in third quarter, data ...
Global venture funding in the third quarter increased 38% year-over-year to $97 billion, increasing slightly from $92 billion in the second quarter. Get a daily ...
AI firms win nearly half of global venture capital - Digit.fyi
AI companies continue to gain the majority of venture funding in the third quarter of this year, data from Crunchbase shows.
Record AI Investment Sparks “Innovation Winter” for Non-AI ...
Global VC funding hits historic highs as AI investment has surged over $190B, leaving non-AI innovators in a funding freeze and fueling new bubble warnings.
AI embraces and extends enterprise software as funding ...
OpenAI is spending $10 billion on AMD hardware (and stock!), while Elon Musk's xAI is spending (or borrowing for) an additional $18 billion worth of Nvidia ...
CEO: AI and defense demand are remaking the space ...
The space economy is experiencing a kind of growth in 2025 that looks nothing like the speculative frenzy of 2021 — and that's exactly why it matters.
What Happens if the AI Bubble Bursts? - Bloomberg
OpenAI builds a circular economy for AI, now with AMD in the loop
Weighing the Risk of Circular AI Investment
Artificial intelligence - Crunchbase News
From OpenAI to Meta, firms channel billions into AI infrastructure ...
筑摩屋松坊堂のアンテナ
【PC/AI】 ◇ AIは脚本家の世界観を再現できるか~日本初「AI脚本」によるテレビドラマから考える 前編,後編 - NHK文研ブログ◇ AIが生成した誤情報を別のAIが情報源 ...
OpenAI, Oracle, and SoftBank expand Stargate with five ...
New data centers put Stargate ahead of schedule to secure full $500 billion, 10-gigawatt commitment by end of 2025.
Countdown to GPT-5, OpenAI's Stargate Sputters, AI Math Wars
OpenAI's Competitive Landscape 05:59 The Coding Capabilities of GPT-5 08:55 The AGI Debate and Its Implications 12:11 The Stargate Project: Ambitions and ...
GPT-5 is here | OpenAI
GPT-5 (2025) – Dr Alan D. Thompson – LifeArchitect.ai
OpenAI Officially Launches GPT-5. Here's a breakdown of what's new ...
OpenAI GPT-5 今夏有望登場!Sam Altman 透露Stargate 計 ...
OpenAI GPT-5 今夏有望登場!Sam Altman 透露Stargate 計畫與Jony Ive 合作進度 · AGI 定義已不斷更新,科學突破才是人類進步關鍵 · GPT-5 確定今年夏天登場,版本命名更清楚 ...
OpenAI、Oracle, 和SoftBank 宣布興建五座AI 資料中心基地
七月份時,OpenAI 和Oracle 達成協議,計畫額外開發高達4.5 GW 的Stargate 運算容量。此項協議代表這兩間公司在接下來的五年期間將進行超過3,000 億美金的合作計畫。
Inside OpenAI's Stargate Megafactory with Sam Altman | The ...
... after his inauguration ... Inside OpenAI's Stargate Megafactory with Sam Altman | The Circuit. 5.3M views · 4 months ago #Stargate #Technology #OpenAI ...
Stargate AI: The World's Largest Artificial Intelligence Project
Discover how OpenAI, SoftBank, Oracle, and the UAE's MGX plan to build Stargate AI — a $500 billion network of super‑fast data centers packed with millions ...
Introducing GPT-5 - Resource | OpenAI Academy
OpenAI, Oracle deepen AI data center push with 4.5 gigawatt ...
GPT-5 is alive
Developers Say GPT-5 Is a Mixed Bag | WIRED
Building Frontier Open Intelligence Accessible to All
Reflection raises $2B to build frontier open intelligence. Combining large-scale LLM training with advanced RL for accessible AI models.
LLM architecture to solve 90% of your problems | by Vikram
LLMs are like interns: they do better with clear instructions and templates. Define JSON schemas while calling your APIs (Generate structured output with the ...
Examining the impact of large language models on design
The identified core capabilities allow LLMs to support designers across all stages of the design process [32], performing tasks such as generating survey ...
Reflections on OpenAI
It's hard to imagine building anything as impactful as AGI, and LLMs are easily the technological innovation of the decade. I feel lucky to have seen some of ...
Reflection System for the Abstraction and Reasoning Corpus
Using augmented ARC data, we fine-tune LLMs and observe a significant gain in ARC accuracy after training. By utilizing reflection, we combine LLMs and a ...
Generative AI models for different steps in architectural ...
由 C Li 著作 · 2025 · 被引用 59 次 — This paper first provides an overview of generative AI technologies, with a focus on probabilistic diffusion models (DDPMs), 3D generative models, and ...
New LLM DESTROYS Every Other Model with "Self Healing ...
I think you're misunderstanding the reflection part. It is reflecting on its answer as it goes. You are thinking of the LLM's answer as one output product, ...
Getting AI Agent Architecture Right with MCP
Emerging Architectures for LLM Applications | Andreessen Horowitz
Self-Reflecting AI Agents Using LangChain | by Vijaykumar Kartha ...
LLM Powered Autonomous Agents | Lil'Log
Observability of LLM Applications: Exploration and Practice from ...
World's "best open-source model" falls short of promised performance
Comparative Analysis of Leading LLM Architectures: OpenAI o3 Pro ...
ArchGPT: harnessing large language models for supporting ...
Meet the new, most powerful open source AI model in the world ...
Your Guide to AI Orchestration: Best Practices and Tools – n8n Blog
AI Agents with n8n: 10+ Automation Ideas Roadmap
Organizations implementing AI agents with n8n in 2025 aren't just automating tasks — they're building competitive moats through superior operational efficiency.
AI Agent Orchestrator - Questions
Hey folks, I'm building a personal AI agent for a client that acts like a digital second brain – deeply integrated into Notion, Gmail, and Google Calendar.
Where Make, n8n, and Langflow Fit
Overall, n8n provides an “AI-native” automation environment: not only can it call AI services, it can let AI drive the automation, enabling far more adaptive ...
DON'T use AI Agent node in N8N
Hi guys! I've spent a lot of time building AI agents for real clients and found that agents made with the basic n8n node are very bad at tool selection, ...
9 AI Agent Frameworks Battle: Why Developers Prefer n8n
n8n is a powerful choice for building AI agents that connect with existing business systems and scale to production. Its blend of visual development, robust ...
OpenAI just killed n8n. How AgentKit Changes Everything
n8n is a general automation tool adapted for AI agents. AgentKit is specifically designed for agentic workflows with: Pre-built agent patterns; Native support ...
n8n Tutorial for Beginners: How to Build AI Automations for FREE ...
SHOWROOM(ショールーム) | ライブ配信サービス
日経トレンディ 2018年2月号 No.427 - 雑誌・無料試し読みなら、電子 ...
スタートアップワールドカップ2025世界決勝戦: 400名超の ...
事業拡大を目指すスタートアップにとって、資金調達、事業提携やマーケティングに繋がるまたとないチャンスとなります。また、日本予選だけに特別に1億5千万円規模の投資 ...
Mutti braucht sex
日経会社情報 · 人事ウオッチ · NIKKEI Prime. メディア一覧. NIKKEI Digital ... 資金調達に疑義も · 日経BizGate · 倒産の力学 芸能プロダクション 編芸能プロ、消え ...
ライフスタイル 舵オンライン │ 船遊びの情報サイト
はてなアンテナ - 愛・蔵太の気ままなアンテナ
著者:ジェイムズ・リー・バーク(吉野弘人 訳)新潮文庫2025年お懐かしや刑事ロビショー・シリーズが復活した!彼が暮らすルイジアナ、かつて組合運動家が惨殺されるという ...
要約の参照
Databricksは、新たにAgent BricksやLakebaseといったAIエージェント向けのデータ基盤開発を拡大し、買収やグローバル展開に資金を充てることが報じられています[CRN](htt...
要約の参照
Trismikは、大規模言語モデル(LLM)の評価に特化したケンブリッジ大学発のスタートアップです。科学グレードのLLM評価手法を開発・提供しており、プレシードファンディングラウンドで220万ポンド(...
📊 ドメイン統計
参照ドメイン数: 95引用済み: 38総文献数: 233
1
引用: 11件/ 総数: 11件
引用率: 100.0%
2
引用: 7件/ 総数: 11件
引用率: 63.6%
3
引用: 6件/ 総数: 8件
引用率: 75.0%
4
引用: 3件/ 総数: 3件
引用率: 100.0%
5
引用: 2件/ 総数: 10件
引用率: 20.0%
6
引用: 2件/ 総数: 8件
引用率: 25.0%
7
引用: 2件/ 総数: 7件
引用率: 28.6%
8
引用: 2件/ 総数: 6件
引用率: 33.3%
9
引用: 2件/ 総数: 6件
引用率: 33.3%
10
引用: 2件/ 総数: 6件
引用率: 33.3%
11
引用: 2件/ 総数: 2件
引用率: 100.0%
12
引用: 1件/ 総数: 10件
引用率: 10.0%
13
引用: 1件/ 総数: 6件
引用率: 16.7%
14
引用: 1件/ 総数: 5件
引用率: 20.0%
15
引用: 1件/ 総数: 2件
引用率: 50.0%
16
引用: 1件/ 総数: 2件
引用率: 50.0%
17
引用: 1件/ 総数: 2件
引用率: 50.0%
18
引用: 1件/ 総数: 2件
引用率: 50.0%
19
引用: 1件/ 総数: 2件
引用率: 50.0%
20
引用: 1件/ 総数: 2件
引用率: 50.0%
21
引用: 1件/ 総数: 2件
引用率: 50.0%
22
引用: 1件/ 総数: 2件
引用率: 50.0%
23
引用: 1件/ 総数: 1件
引用率: 100.0%
24
引用: 1件/ 総数: 1件
引用率: 100.0%
25
引用: 1件/ 総数: 1件
引用率: 100.0%
26
引用: 1件/ 総数: 1件
引用率: 100.0%
27
引用: 1件/ 総数: 1件
引用率: 100.0%
28
引用: 1件/ 総数: 1件
引用率: 100.0%
29
引用: 1件/ 総数: 1件
引用率: 100.0%
30
引用: 1件/ 総数: 1件
引用率: 100.0%
31
引用: 1件/ 総数: 1件
引用率: 100.0%
32
引用: 1件/ 総数: 1件
引用率: 100.0%
33
引用: 1件/ 総数: 1件
引用率: 100.0%
34
引用: 1件/ 総数: 1件
引用率: 100.0%
35
引用: 1件/ 総数: 1件
引用率: 100.0%
36
引用: 1件/ 総数: 1件
引用率: 100.0%
37
引用: 1件/ 総数: 1件
引用率: 100.0%
38
引用: 1件/ 総数: 1件
引用率: 100.0%
39
引用: 0件/ 総数: 10件
引用率: 0.0%
40
引用: 0件/ 総数: 5件
引用率: 0.0%
41
引用: 0件/ 総数: 4件
引用率: 0.0%
42
引用: 0件/ 総数: 4件
引用率: 0.0%
43
引用: 0件/ 総数: 3件
引用率: 0.0%
44
引用: 0件/ 総数: 3件
引用率: 0.0%
45
引用: 0件/ 総数: 3件
引用率: 0.0%
46
引用: 0件/ 総数: 3件
引用率: 0.0%
47
引用: 0件/ 総数: 3件
引用率: 0.0%
48
引用: 0件/ 総数: 2件
引用率: 0.0%
49
引用: 0件/ 総数: 2件
引用率: 0.0%
50
引用: 0件/ 総数: 2件
引用率: 0.0%
51
引用: 0件/ 総数: 2件
引用率: 0.0%
52
引用: 0件/ 総数: 2件
引用率: 0.0%
53
引用: 0件/ 総数: 2件
引用率: 0.0%
54
引用: 0件/ 総数: 2件
引用率: 0.0%
55
引用: 0件/ 総数: 2件
引用率: 0.0%
56
引用: 0件/ 総数: 2件
引用率: 0.0%
57
引用: 0件/ 総数: 2件
引用率: 0.0%
58
引用: 0件/ 総数: 2件
引用率: 0.0%
59
引用: 0件/ 総数: 2件
引用率: 0.0%
60
引用: 0件/ 総数: 2件
引用率: 0.0%
61
引用: 0件/ 総数: 2件
引用率: 0.0%
62
引用: 0件/ 総数: 2件
引用率: 0.0%
63
引用: 0件/ 総数: 2件
引用率: 0.0%
64
引用: 0件/ 総数: 1件
引用率: 0.0%
65
引用: 0件/ 総数: 1件
引用率: 0.0%
66
引用: 0件/ 総数: 1件
引用率: 0.0%
67
引用: 0件/ 総数: 1件
引用率: 0.0%
68
引用: 0件/ 総数: 1件
引用率: 0.0%
69
引用: 0件/ 総数: 1件
引用率: 0.0%
70
引用: 0件/ 総数: 1件
引用率: 0.0%
71
引用: 0件/ 総数: 1件
引用率: 0.0%
72
引用: 0件/ 総数: 1件
引用率: 0.0%
73
引用: 0件/ 総数: 1件
引用率: 0.0%
74
引用: 0件/ 総数: 1件
引用率: 0.0%
75
引用: 0件/ 総数: 1件
引用率: 0.0%
76
引用: 0件/ 総数: 1件
引用率: 0.0%
77
引用: 0件/ 総数: 1件
引用率: 0.0%
78
引用: 0件/ 総数: 1件
引用率: 0.0%
79
引用: 0件/ 総数: 1件
引用率: 0.0%
80
引用: 0件/ 総数: 1件
引用率: 0.0%
81
引用: 0件/ 総数: 1件
引用率: 0.0%
82
引用: 0件/ 総数: 1件
引用率: 0.0%
83
引用: 0件/ 総数: 1件
引用率: 0.0%
84
引用: 0件/ 総数: 1件
引用率: 0.0%
85
引用: 0件/ 総数: 1件
引用率: 0.0%
86
引用: 0件/ 総数: 1件
引用率: 0.0%
87
引用: 0件/ 総数: 1件
引用率: 0.0%
88
引用: 0件/ 総数: 1件
引用率: 0.0%
89
引用: 0件/ 総数: 1件
引用率: 0.0%
90
引用: 0件/ 総数: 1件
引用率: 0.0%
91
引用: 0件/ 総数: 1件
引用率: 0.0%
92
引用: 0件/ 総数: 1件
引用率: 0.0%
93
引用: 0件/ 総数: 1件
引用率: 0.0%
94
引用: 0件/ 総数: 1件
引用率: 0.0%
95
引用: 0件/ 総数: 1件
引用率: 0.0%
このレポートが参考になりましたか?
あなたの仕事の調査業務をワンボタンでレポートにできます。